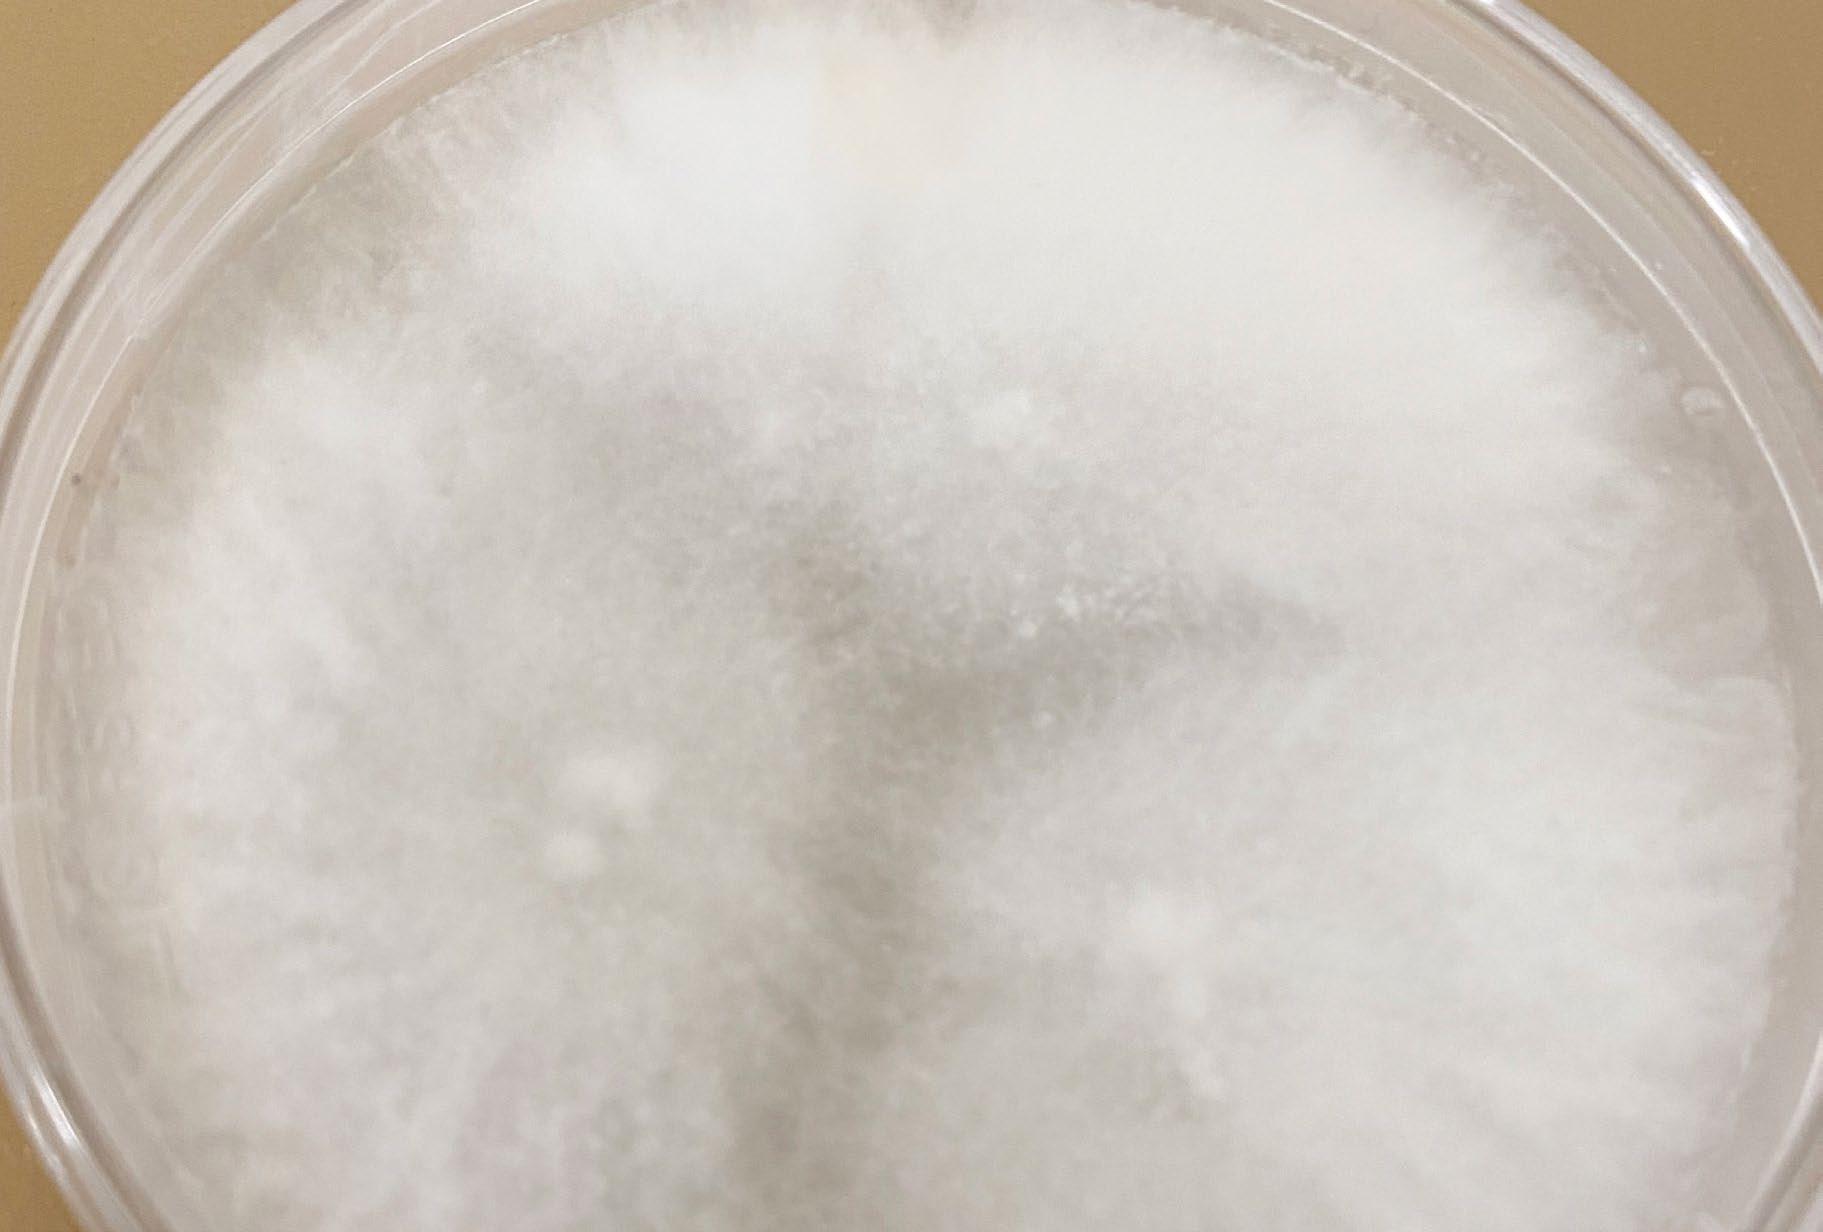

IMMOBILIEN AKTUELL
By IMMOCOM
AUSGABE 2023
WANDLUNGSFÄHIGKEIT

GEFRAGT
Warum in der Bestandsentwicklung ein Umdenken nötig ist
ENTEIGNUNGEN
Pro und Kontra
Menschen aus allen Bereichen und Segmenten der Immobilienbranche vor. Die Immobilien- und MarketingProfis Ivette Wagner und Michael Rücker sprechen mit Immobilienentwicklern, Bestandshaltern und Investoren, mit den bekannten Marktgrößen ebenso wie mit neu gegründeten Start-ups. Dabei geht es um die verschiedenen Assetklassen und aktuelle Themen, die die Branche bewegen: Wohnen und Büro, Handel und Logistik, Nachhaltigkeit und ESG, Finanzierung und Fonds. Was wird da gerade gemacht, warum, was treibt die Menschen an, was ist neu, was ist spannend? Freuen Sie sich auf unterhaltsame und informative Gespräche –für alle, denen das Thema Immobilien wichtig ist.

Jetzt reinhören!
www.immobileros.de
IMMOBILIEN AKTUELL 2
Weggeglupscht?

Chamäleons sehen die Welt durch Superglupscher: extrem scharf. Sie scannen ihre Umwelt, die Augen drehen sich wie Bälle in alle Richtungen, damit sie nichts verpassen. Und was sehen wir? „Vertreibung aus dem Mieterparadies“ titelte die FAZ, „Immobilienmarkt mit historischem Einbruch“ die Immobilien Zeitung, „Die Regierung lässt Wohnungsverkäufer im Stich“ die Süddeutsche Zeitung. Die zum Teil gehässigen Schlagzeilen der taz und des Neuen Deutschlands zu den zahlreichen Insolvenzen der Branche haben hier nichts zu suchen.
Befällt Chamäleons die Angst, schalten viele auf Schwarz. Lassen sie sich von Angriffslust durchlaufen, werden sie rot. Niedergeschlagenheit und Alarm also, gemixt wird es zu – je nachdem, welcher Farbton hauptsächlich als Zutat einfließt – irgendwas zwischen dunkelrot und schwarzbraun. Farben, die nicht gerade für eine sonnige Zukunft stehen.
Resignation macht sich breit, rien ne va plus, nichts geht mehr. Oder zumindest nicht mehr viel. Aus dem zähen Ringen ist eine Vollbremsung geworden. Mannigfach funkelt dagegen die Politik: zwischen einem nicht wirklich durchdachten und sehr verwirrendem Heizungsgesetz, unzureichenden bis keinen Förderungen, dafür aber um so mehr Forderungen. Hier scheint es keine Superglubscher zu geben, die gestochen scharf sehen. Die Bundesbauministerin und ihr Team schaffen es innerhalb von fast drei Monaten nicht, ein paar Interviewfragen schriftlich zu beantworten. Urlaub, Krankheit, viel zu tun. Da wechselt das Chamäleon direkt von Schwarz auf Rot und wieder zurück. Was, wenn die Immobilienbranche sich abduckt? Urlaub, Krankheit, viel zu tun. Leider können wir keine Gespräche mehr führen. Da liefe dann die Politik Rot an?
Bashing ist doof, da halten wir es lieber mit der Geduld. Denn die haben Chamäleons fast unendlich, können stundenlang regungslos auf Beute warten. Macht die Branche genau das? Kapituliert sie vor Transformation, wirren ESG-Regularien, Verboten, Auflagen, Partizipation? Neben den Dingen, die sowieso schon nicht passen: schnell gestiegene Zinsen, veränderte Baukosten, zurückhaltende Investoren. Schwarz oder rot? Wann das Chamäleon Immobilienbranche wieder schillert in all den schönen Farben der Welt? Auch die Glupschaugen können keine Zukunft sehen. Also müssen es alle gemeinsam richten. Am besten mit Respekt füreinander.

In diesem Sinne
Herzliche Grüße Ivette Wagner Redaktionsleiterin
PS: Mit dem Erscheinen dieses Editorials ist, so wurde mir das gesagt, die Wahrscheinlichkeit „noch irgendetwas mit unserem Ministerium zu machen“ passé.

IMMOBILIEN AKTUELL 3 EDITORIAL
SCHWERPUNKTE
Bestandsentwicklung
Wandlungsfähigkeit ist gefragt: Von Umwidmungen über Aufstockungen bis hin zu neuen Nutzungskonzepten für Erdgeschosse – mit Bestandsentwicklung tut sich die Branche schwer. Dabei liegt hierin ein Schlüssel für moderne Stadtentwicklung. Der neue Verband für Bauen im Bestand (BiB) macht sich für ein Umdenken und neue Normen stark.
48 – 55
Neue Assetklassen
Investoren sind am Immobilienmarkt zurückhaltender geworden. In unsicheren Zeiten suchen sie nach Projekten, die sich durch Konjunkturunabhängigkeit und stabile Cashflows auszeichnen. Laut Marktkennern rücken damit Quartiere, Sozialimmobilien, Rechenzentren und Life ScienceImmobilien in den Fokus.


62 – 69
Einzelhandel
Während sich der klassische Einzelhandel aus den Innenstädten zurückzieht, erobern neue Mieter mit frischen Konzepten die leerstehenden Flächen. Selbst der Lebensmitteleinzelhandel versucht sich mit Innenstadtfilialen. In Umwidmungen, Sanierungen und Mixed-Use-Konzepten liegen neue Chancen für Handelsimmobilien.

IMMOBILIEN AKTUELL 4
90 – 95
INHALT
MEINUNGEN
KOMMENTAR: PRO
Die Vergesellschaftung von Wohnungen sorgt für bezahlbare Mieten. Denn wenn der Renditedruck entfällt, können die Mietpreise stabilisiert oder sogar gesenkt werden. Davon ist Politikwissenschaftlerin Constanze Kehler überzeugt, die sich bei Deutschen Wohnen & Co. enteignen engagiert.

KOMMENTAR: KONTRA
Durch Enteignung entsteht keine neue Wohnung. Denn eine Vergesellschaftung würde private Investitionen in den Wohnungsmarkt verhindern und den Neubau abwürgen, warnt Professor Thomas Beyerle, Head of Research bei Catella und Professor für Immobilienwirtschaft und Immobilienresearch.


GASTBEITRAG
Deutschlands Innenstädte müssen sich neu erfinden. Es braucht mehr Möglichkeiten für Begegnung und Erlebnis, mit einer höheren Aufenthaltsqualität, betont Markus Lewe, Präsident des Deutschen Städtetages und Oberbürgermeister der Stadt Münster.
IMMOBILIEN AKTUELL 5 INHALT
96
14
15 Editorial Impressum 3 118
KURZ & KOMPAKT
München baut nur noch Hochhäuser mit Mehrwert Bundesverband Immobilienverrentung gegründet
IVD hat neuen Präsidenten
Schlechte Noten für Deutschlands Brücken
TRENDS & TENDENZEN
Umfrage: Welches sind die attraktivsten deutschen Standorte für Immobilienprojekte?

Kirche: Oberkirchenrätin Deike Möller über finanzielle Hürden und Sanierungsstau
Stadtflucht: Die Abwanderung ins Umland ist auf dem höchsten Niveau seit 30 Jahren
Investment: Michael Keune über dunkelgrüne Impact-Fonds, Wohntürme und ein deutsches Hindernis

Office: Warum Untervermietung im BüroMarkt eine immer größere Rolle spielt
Acht Hochhäuser auf einmal: Jena bekommt eine Skyline
PropTechs: Vier heiße Start-ups der Immobilienbranche im Porträt
PROJEKTE & VORHABEN
Berlin: Am Behrens-Ufer entsteht Europas nachhaltigstes Gewerbeprojekt
Dresden: Fernbusbahnhof soll Leuchtturmprojekt für urbane Mobilitäts-Hubs werden
Nürnberg: Neuer Business-Tower THE ONE wächst zur markanten Landmarke heran
Stuttgart: Wie das Mixed-Use-Projekt TWO.ONE die Kontraste zweier Straßen aufgreift

München: Der MediaWorks-Komplex wird als gemischt genutzter Campus revitalisiert

IMMOBILIEN AKTUELL 6 INHALT 30 32
10 11 12 13 16 20 22 24 26 28 30 32 34 36 37 38 22
PROJEKTE & VORHABEN
Lübeck: Mit der Neuen Meile entsteht eines der größten neuen Wohnquartiere an der Trave


Düsseldorf: Gläsernes Stadttor mit freitragendem Glasprisma
Worms: Historischer Schlachthof wird zur modernen Lifestyle-Immobilie MATADERO

Halle (Saale): Der Zuschlag für das Zukunftszentrum beschert der Stadt viele Aufgaben
Köln: Parkstadt Süd und Grüngürtel sollen bis 2037 vollendet werden
Hamburg: Luxuswohntower The Lyte avanciert zur neuen Ikone der HafenCity
Frankfurt am Main: Wie das Bürogebäude ATREEUM zur entschleunigten grünen Oase wird
ESG: Vattenfall trägt mit dezentralen Lösungen zur Wärmewende im Gebäudesektor bei
BAUEN & ROHSTOFFE
Pilz-Power: Baustoffe aus Pilzmyzel könnten in absehbarer Zeit produktionsreif sein

Modulbau: SEMUDO-Expertin Nasim Fahimian über Vorteile und Vorurteile
Schadstoffe: Wie die Herausforderungen des Rückbaus am Behrens-Ufer gelöst werden
IMMOBILIEN AKTUELL 7 INHALT 56 42
39 40 42 43 44 45 46 47 56 58 60 74
MACHER & MÄRKTE
Premier Inn: Chris-Norman Sauer über Expansion, Silverlining und Bestandskonversion
Leerstand: Prof. Dr. Günter Vornholz befürchtet Abwärtsspirale und abgehängte Regionen
Holzwohnungsbau: Schweizer Spezialist Swiss Property AG drängt auf deutschen Markt
Makler: In Zeiten rarer Käufer sind wieder Vermittler mit Verkäufertugenden gefragt
Reingehört: Das Who is Who der Branche im Immobiléros-Podcast
Gesundheitsimmobilien: Betreutes Wohnen erobert Marktanteile
Entwicklermarkt: Simon Kempf von DLE Land Deveolpment über die aktuelle Situation
BÜRO & LOGISTIK
Raues Fahrwasser: Büromarkt zwischen Umsatzrückgang und neuen Anforderungen
Studie: In Europa drohen drei Viertel aller Bürogebäude bis 2030 zu veralten
HIH Invest Real Estate: Klassiker wie Büroimmobilien kommen nie aus der Mode

Logistikimmobilien: Die Sonderkonjunktur bei Lagerhallen und Verteilzentren ist vorbei

Evolution: Die Zukunft von Logistikimmobilien liegt im Ausbau zu Infrastrukturhubs
Flächenknappheit: Standorte an der A24 profitieren von Hamburgs Platzmangel
KAPITAL & INVEST
Immobilienleasing: Welche Vorteile es bietet und warum der Markt plötzlich boomt
Connecting: DNS:NET ist Partner der Wohnungswirtschaft bei der Glasfaseranbindung
Crowdinvestment: Wie Wohnungsgenossenschaften von einer Spareinrichtung profitieren
Ferienimmobilien: Der Markt ist von Kaufzurückhaltung und Verschiebungen geprägt
Impact-Investing: Erste Impact-Fonds für Pflegeimmobilien aufgelegt
Ökologische Geldanlage: Darum sind Holzinvestments schwer angesagt
IMMOBILIEN AKTUELL 8 INHALT 102 90
70 72 73 74 76 78 80 82 84 85 86 88 89
98 99 100 102 106 108
DIE GALERIE 110 – 117
Volkstheater – Rostock
Im Herbst 2028 hebt sich der Vorhang des neuen Volkstheaters in Rostock zum ersten Mal. Der Solitär mit Rundblick soll das neue Wohnzimmer der Stadt werden.


Bredeney Park – Essen
Angelehnt an beste BauhausTraditionen entstehen im Essener Stadtteil Bredeney sieben Stadtvillen an den Ruhrhöhen.
STUTTGART
Westend Gardens – Frankfurt
Garbe Immobilien will den gut 30 Jahren alten Verwaltungsbau der ehemaligen Oberpostdirektion im Frankfurter Westend bis 2025 ESG-konform revitalisieren.

Aer – München
Im Münchner Stadtteil
Neuperlach verwandelt Hines einen ehemaligen AllianzStandort in das nachhaltige Büro- und Wohnquartier Aer.

House of One – Berlin
Ein Gotteshaus für drei Religionen, das ist die Idee des House of One. Es sieht für Christen, Juden und Muslime unter einem Dach eine Kirche, eine Synagoge und eine Moschee vor.

IMMOBILIEN AKTUELL 9 INHALT
ESSEN
FRANKFURT
MÜNCHEN
HEILBRONN FREIBURG DRESDEN ERFURT WENDLINGEN LEINFELDENECHTERDINGEN
BERLIN POTSDAM BESTENSEE
ROSTOCK HAMBURG
Europas größtes 3D-Druck-Haus fertiggestellt
Heidelberg. Die KRAUSGRUPPE hat in Heidelberg das größte gedruckte Gebäude in Europa errichtet. Das wellenförmige Bauwerk, das von oben wie ein Rechteck mit Kurven aussieht, ist rund 54 Meter lang, elf Meter tief und neun Meter hoch. Es befindet sich auf der Fläche des ehemaligen Hauptquartiers der US-amerikanischen Streitkräfte in Europa. Der Andruck des Gebäudes erfolgte am 31. März 2023, Ende Juli 2023 wurde das Ergebnis der Öffentlichkeit präsentiert. Bei der Herstellung kam ein spezieller 3D-Druckbeton zum Einsatz, der zu 100 Prozent recyclebar ist. Darüber hinaus beinhaltet der mineralische Baustoff ein Bindemittel mit etwa 55 Prozent CO2-Reduktion gegenüber herkömmlichem Zement. Realisiert wurde das Projekt in Zusammenarbeit mit der Firma PERI 3D Construction, die bereits 2021 das erste gedruckte Einfamilienhaus im nordrhein-westfälischen Beckum vollendet hatte, und dem Baustoffunternehmen Heidelberg Materials. Ab Ende 2023 wird der Cloud- und Rechenzentrumsanbieter Heidelberg iT Management GmbH & Co. KG das 3D-gedruckte Haus als IT-Serverhotel nutzen.
München will nur noch Hochhäuser mit Mehrwert bauen
München. Jedes neue Hochhausprojekt in München soll künftig verschiedene Nutzungsformen bieten. So sieht es die vom Stadtrat verabschiedete Hochhausstudie 2023 vor, die das Architekturbüro 03 Arch erarbeitet hat. „Wenn wir hohe Häuser in dieser Stadt planen und zulassen, sollen sie so gestaltet sein, dass sie einen Mehrwert für die Gesellschaft allgemein und vor allem für ihre Umgebung bieten“, erklärte Stadtbaurätin Professor Elisabeth Merk. Mit anderen Worten: Reine Bürohochhäuser wird es nur noch in Ausnahmefällen geben. Vielmehr sollen künftige Projekte neben Büros auch Wohnungen und geförderten Wohnraum sowie gesellschaftlichen Mehrwert durch soziale oder kulturelle Infrastruktur bieten. Darüber hinaus sind Hochhausentwicklungen nur noch in hoher gestalterischer, ökologischer und gesellschaftlicher Qualität möglich. Hierfür sind die Ziele der Klimaneutralität, der Langlebigkeit und der Nutzungsflexibilität ebenso zu berücksichtigen wie das Schwammstadtprinzip. Dem Stadtratsbeschluss zur Anwendung der Hochhausstudie war ein umfangreicher Diskussions- und Beteiligungsprozess vorausgegangen.


Neue Richtlinie zur Betreiberverantwortung mit Fokus auf ESG
Bonn. Von Grund auf überarbeitet und inhaltlich weiterentwickelt präsentiert sich die Neuauflage der Richtlinie
GEFMA 190 Betreiberverantwortung
2.0 im Facility Management. Das Standardwerk zum (rechts-)sicheren und nachhaltigen Betrieb von Immobilien und technischen Anlagen reicht über veränderte gesetzliche Anforderungen
hinaus. Ulrich Glauche, Leiter Richtlinienwesen bei gefma Deutscher Verband für Facility Management e.V., erläutert den Grund dafür: „Früher waren wir der Auffassung, es sei ausreichend, die geltenden Gesetze, Normen und Richtlinien einzuhalten, also im Facility Management rechtskonform zu agieren. Heute müssen wir angesichts
der großen Herausforderungen durch Klimaschutz und Nachhaltigkeit darüber hinaus gehen: Wir benennen und empfehlen in der aktuellen Richtlinie GEFMA 190 zusätzlich freiwillige Maßnahmen im Vorgriff auf kommende Gesetze, denn der Gesetzgeber agiert in diesen Handlungsfeldern unseres Erachtens zu langsam.“
IMMOBILIEN AKTUELL 10 KURZ & KOMPAKT
Bundesverband Immobilienverrentung gegründet
Berlin. Sieben Anbieter von Immobilienverrentungs-Modellen haben sich zum Bundesverband Immobilienverrentung (BVIV) zusammengeschlossen. Die neue Branchenvereinigung hat ihren Sitz in Berlin und wird von Julia Miller (Heimkapital GmbH) und Christoph Sedlmeier (Stiftung Liebenau) als Doppelspitze geführt. Ziel des Verbandes ist es, den Markt für Immobilienverrentungsprodukte gegenüber Verbrauchern transparenter zu gestalten. Zugleich verpflichten sich die Mitgliedsunternehmen, die in einem Code of Conduct definierten Qualitätsstandards zum Schutz der Kunden einzuhalten, damit diese die beste Entscheidung für sich treffen können. Die BVIV-Gründungsunternehmen decken die am Markt etablierten Immobilienverrentungs-Modelle Leibrente, Nießbrauch, Rückmietung, Seniorenkredit sowie Teilverkauf ab. Sie haben Lösungen entwickelt, mit denen Immobilieneigentümer das in der Immobilie gebundene Kapital freisetzen können, ohne ausziehen zu müssen. Solche Lösungen werden seit Jahren immer stärker nachgefragt. Sie sollen mit der Gründung des Verbandes weiter professionalisiert werden.

VKU-Studie fordert flexiblen Regulierungsrahmen für Gas
Berlin. Spätestens 2045 soll kein Gas mehr durch die 330.000 Kilometer langen Gasverteilnetze fließen. Damit stellt sich die Frage: Sollen die Netze stillgelegt oder umgenutzt werden? Der Verband kommunaler Unternehmen e. V. (VKU) hat dazu eine Studie in Auftrag gegeben. Da sich die Netze technisch auf grüne Gase wie Wasserstoff oder Biomethan umrüsten und auch als Speicher nutzen lassen,
plädiert VKU-Hauptgeschäftsführer Ingbert Liebing für einen geordneten Ausstieg aus dem Erdgas und einen Einstieg in klimaneutrale Gase, wo es sinnvoll ist. „Die Transformation hängt von den örtlichen Bedingungen ab“, betont Ingbert Liebing. Was bisher fehle, sei die passende Regulierung. Ob Stilllegung oder Umnutzung, für beide Optionen würden Antworten benötigt, da die bisherige Regulierung auf den
Dauerbetrieb der Gasnetze ausgerichtet sei. Die VKU-Studie zeigt daher auf, bei welchen Bundes- und EU-Regelungen, zum Beispiel zu Netzentgelten, Anschlusspflichten, Nutzungsdauern, Konzessionsverträgen, und vieles mehr, künftig Anpassungsbedarf besteht. Der VKU vertritt über 1.500 Stadtwerke und kommunalwirtschaftliche Energie-, Wasser-, Abfall- und Telekommunikations-Unternehmen.
Weltpremiere: Fassade aus 100 Prozent recyceltem Aluminium
Augsburg. Das Immobilienprojekt Innovationsbogen in Augsburg ist eine echte Weltpremiere, denn die Komponenten und Bauteile der Fassade wurden erstmals zu 100 Prozent aus recyceltem Aluminium hergestellt. Hierfür nutzte die WALTER Beteiligungen und Immobilien AG das Knowhow des Ulmer Aluminium-Systemhauses WICONA. Dessen neu entwickeltes Aluminium Hydro CIRCAL 100R hat einen durchschnittlichen CO₂-Fußabdruck von weniger als 0,5 Kilogramm Kohlenstoffdioxid pro Kilogramm Aluminium. Der europäische Durchschnitt für solches Material liegt bei 6,7 Kilogramm CO₂ pro Kilogramm Aluminium. Somit bewirkt die Verwendung von 85 Tonnen des neuartigen Recycling-Aluminiums für die Fassade des 145 Meter langen, bogenförmigen Bürogebäudes eine CO₂-Einsparung von 527 Tonnen. Entworfen wurde die Fassade von Hadi Teherani Architects, PBI Entwicklung innovativer Fassaden GmbH, Schindler Fenster + Fassaden GmbH und WICONA.

IMMOBILIEN AKTUELL 11 KURZ & KOMPAKT
IVD hat neuen Präsidenten
Berlin. Der Immobilienverband Deutschland IVD hat den Berliner Immobilienmakler Dirk Wohltorf einstimmig an die Verbandsspitze gewählt. Der neue Präsident verwies darauf, dass Immobilienprofis wie Makler, Verwalter, Sachverständige und Berater heute mehr denn je gefragt seien, bei der Lösung der wohnungspolitischen Herausforderungen mitzuwirken. „Wir sind im Bündnis bezahlbarer Wohnraum im regelmäßigen Dialog mit der Bundesregierung. Als Immobilienunternehmer wissen wir, dass für mehr Wohnungsbau die Förderung der Wohneigentumsbildung eine entscheidende Voraussetzung ist“, erklärte Dirk Wohltorf. Der 1975 in Berlin geborene Immobilienökonom war langjähriger Vizepräsident des IVD. Er übernimmt die Verbandsführung von Jürgen Michael Schick, der nach acht Jahren Amtszeit satzungsgemäß nicht erneut für das Präsidentenamt kandidierte.
Trendstudie Real Estate in der Industrie 2023
Frankfurt School Real Estate Institute startet 2024
Frankfurt am Main. Die Frankfurt School of Finance & Management öffnet sich strategisch der Immobilienwirtschaft und gründet hierfür das Frankfurt School Real Estate Institute. Die neue Einrichtung wird mit zwei Professuren ausgestattet: einer Tenure-Track-Professur und einer Management-Practice-Professur. Mehr als 15 Unternehmen der Immobilien- und Finanzwirtschaft werden das neue Institut ab 2024 fördern. „Immobilien bilden die größte Assetklasse, werden aber gerade in der Finance-Forschung

nur marginal adressiert“, sagt Professor Dr. Nils Stieglitz, Präsident der Frankfurt School of Finance & Management. „Dank der großzügigen Förderung, die wir jetzt erhalten, werden wir dies ändern und ein forschungsstarkes Cluster aufbauen.“ Das neue Real Estate Institut will sich drängenden Themen der Immobilienbranche widmen und hierfür Forschungsprojekte durchführen, Bildungsprogramme ausbauen, Netzwerkangebote erweitern, Nachwuchs gewinnen und die Sichtbarkeit der Branche erhöhen.
Stuttgart. Immobilienverantwortliche in Industrieunternehmen müssen sich mit immer komplexeren Themen auseinandersetzen. Das reicht von Nachhaltigkeit über New Work bis hin zur Flächeneffizienz. Zu diesen Ergebnissen kommt die diesjährige Trendstudie Real Estate in der Industrie des Beratungsunternehmens Drees & Sommer SE. Demnach spüren 85 Prozent der Befragten gesellschaftlichen und politischen Druck bei den Themen Nachhaltigkeit und ESG. Doch nur die Hälfte gibt an, sich mit ESG im Detail auszukennen. Auch Homeoffice beschäftigt die Immobilienverantwortlichen. In 28 Prozent der Unternehmen entfallen mittlerweile im Schnitt drei Tage pro Woche auf das Homeoffice. Wegen des Leerstandes wollen fast zwei Drittel der Unternehmen ihre Flächen anpassen, 22 Prozent haben dies schon getan. Zudem ergab die Studie, dass sich der Trend zu zentralen Immobilienorganisationen im Unternehmen verstärkt hat, wodurch Immobilienverantwortliche immer mehr zu strategischen Partnern für andere Bereiche wie Vorstand oder HR werden. Für die Studie wurden 215 Immobilienverantwortliche in deutschen Industrieunternehmen befragt.

IMMOBILIEN AKTUELL 12 KURZ & KOMPAKT
Schlechte Noten für Deutschlands Brücken
Berlin. Fast die Hälfte der 25 höchsten Brücken Deutschlands befindet sich in einem kritischen bis ungenügenden Bauzustand. Das ergab eine Untersuchung der Bundesgütegemeinschaft Instandsetzung von Betonbauwerken. Dabei erhielten elf Brücken, überwiegend aus den 1970er-Jahren und früher, eine Zustandsnote zwischen drei und 3,5 (auf einer Skala von eins bis vier). Ihr Bauzustand ist somit kritisch beziehungsweise ungenügend. Bei den übrigen 14 Brücken reichen die Zustandsnoten von zwei bis 2,9, was einem befriedigenden bis ausreichenden Zustand entspricht. Ursache für den schlechten Bauzustand ist zu starke Belastung. Viele Brücken wurden in Zeiten errichtet, als die Verkehrsströme deutlich geringer waren. Darum weisen viele der Bauwerke heute auch Defizite bei der Traglast auf. Bei elf der 25 höchsten Brücken Deutschlands klafft das Verhältnis von aktueller Belastung zu ausgelegter Tragfähigkeit so weit auseinander, dass sie mit den schlechtesten Traglastindex-Bewertungen IV und V (auf einer Skala von I bis V) abschnitten. Das Brückenmodernisierungsgesetz sieht vor, neun der höchsten Brücken bevorzugt zu modernisieren.

Bochum. Wohnungsgenossenschaften stehen durch gesellschaftliche Veränderungen und besondere Herausforderungen wie Klimaschutz und Energiewende vor neuen Aufgaben- und Fragestellungen. Um hierauf Antworten zu finden, gründete die Bochumer EBZ Business School das Institut für wohnungsgenossenschaftliche Zukunftsfragen eG21. Die neue Einrichtung will als fachkundiger, fundierter und sichtbarer Vordenker für wohnungswirtschaftliche Zukunftsthemen agieren, Nutzen stiften und Wohnungsgenossenschaften als attraktive Arbeitgeber in das Bewusstsein von Nachwuchskräften rücken. „Genossenschaften sind per Definition die nachhaltigste Rechtsform, die wir haben, aber sie müssen dennoch gemeinsam mit den Mitgliedern nach neuen Ansätzen suchen“, sagt Dr. David Wilde, Wissenschaftlicher Leiter des eG21 und Vorstandsvorsitzender der Hattinger Wohnungsgenossenschaft hwg. Bei der Suche nach zukunftsweisenden Ansätzen, so David Wilde, solle das eG21 ein Hotspot werden.
Studie: Kompakte Wohnformen sparen Kosten
Leverkusen. Die Abschlagszahlungen für Compact Living Wohnungen (maximal 1,5 Zimmer neben Küche und Bad) sind 2022 um rund 44 Prozent gestiegen. Das entspricht zwar dem Anstieg in anderen Wohnungssegmenten, doch aufgrund der geringeren Fläche liegt der Zuwachs in absoluten Zahlen nur bei durchschnittlich 268 Euro jährlich.
Bei Zwei- und Drei-Zimmer-Wohnungen sind es dagegen 357 und 466 Euro. Zu diesem Ergebnis kommen das Institut der deutschen Wirtschaft Köln und Cube Real Estate, die zum dritten Mal in Folge den Markt für Compact Living (CL) untersuchten. Aus ihrem „Cube Compact Living Report“ geht außerdem hervor, dass die Heizkosten regional sehr unterschiedlich stiegen –in Berlin und Köln zum Beispiel um mehr als 60 Prozent, in Stuttgart und München um weniger als 40 Prozent. Auch die Kauf- und Mietpreise von CL-Wohnungen haben sich 2022 erhöht. Käufer mussten 7,9 Prozent und Mieter 3,7 Prozent mehr bezahlen. Gerade der Anstieg der Kaufpreise sei angesichts der gestiegenen Zinsen bemerkenswert, betonen die Studienautoren. Sowohl der Preiszuwachs als auch die kürzere Vermarktungsdauer für Mietobjekte spiegle die wachsende Attraktivität des CL-Segments wider, das mit klaren Kostenvorteilen punktet.

IMMOBILIEN AKTUELL 13 KURZ & KOMPAKT
EBZ etabliert Institut für Wohnungsgenossenschaften
Warum
Vergesellschaftung
für bezahlbare
Mieten sorgt
Constanze Kehler, Politikwissenschaftlerin, seit 2020 engagiert bei Deutsche Wohnen & Co enteignen

Die Mehrheit der Berlinerinnen und Berliner hat sich im September 2021 per Volksentscheid für die Vergesellschaftung großer Immobilienkonzerne wie Deutsche Wohnen und Vonovia ausgesprochen. Am 28. Juni 2023 erklärte die Expertenkommission die Enteignungen für rechtlich möglich. Und das ist auch gut so, wie wir in Berlin zu sagen pflegen. Denn die Situation auf dem Berliner Wohnungsmarkt ist so schlimm wie nie zuvor.
Allein im ersten Quartal 2023 sind nach Angaben des Portals immowelt die Bestandsangebotsmieten um 22 Prozent gestiegen. Gleichzeitig steht durch die Leitzinserhöhungen das Geschäftsmodell von Vonovia und Co. unter Druck. Die Aktienkurse der Immobilienkonzerne brechen ein, die Buchwerte der Portfolios sinken, die Verschuldungsgrade steigen. Die Folge: Neubauprojekte werden eingestellt, und gerade die kapitalmarktorientierten Konzerne versuchen,
Wohnungen abzustoßen, um liquide zu bleiben. Kurzum, der Immobilienboom hat einen heftigen Dämpfer bekommen. Doch das ist keineswegs eine gute Nachricht für Mieterinnen und Mieter. Denn die Konzerne bemühen sich, ihre Aktionäre mit dem Versprechen zukünftiger Mieterhöhungen zu beruhigen. Der Druck wird so unmittelbar weitergegeben, denn die Gewinnausschüttungen von heute sind die Mietsteigerung von morgen. Die Krise der Immobilienbranche ist dabei nicht das eigentliche Problem. Sie legt nur die Mechanismen des finanzialisierten Wohnungsmarktes offen. Das Erwirtschaften möglichst hoher und schneller Profite steht an erster Stelle – um eine stabile und leistbare Wohnraumversorgung ging es nie. Die Konzerne investieren deutlich weniger in Instandhaltung als kommunale Wohnungsunternehmen und Genossenschaften, vermieten aber teurer und schaffen kaum bezahlbaren Wohnraum durch Neubau. Durch das ständige Streben nach einer Steigerung der Portfolio-Bewertungen werden die Preise maßlos in die Höhe getrieben – nicht nur für Mietwohnungen, sondern auch für Gewerbeflächen, Eigentumswohnungen, Häuser und Grundstücke.
Diese Dynamik können wir mit einer Vergesellschaftung durchbrechen. Unsere Initiative fordert, den Wohnungsmarkt gemeinwohlorientiert zu organisieren und die Wohnraumversorgung wieder in den Mittelpunkt zu rücken. Die Überführung der Bestände in eine Anstalt des öffentlichen Rechtes würde eine demokratische Verwaltung der Bestände ermöglichen. Alle Berlinerinnen und Berliner könnten dann mitentscheiden, was mit den Beständen passiert.
Die Vergesellschaftung sichert langfristig günstigen Wohnraum für alle. Entfällt der Renditedruck, können die Mietpreise stabilisiert und, wo es möglich ist, abgesenkt werden. Die zu Jahresbeginn erschienene Studie der RosaLuxemburg-Stiftung mit dem Titel „Vergesellschaftung senkt die Miete“ zeigte auf, dass die Mieten in den zu vergesellschaftenden Beständen um etwa 16 Prozent gesenkt werden können, wenn sie nach dem Vorbild der kommunalen Berliner Wohnungsunternehmen bewirtschaftet würden. Davon profitiert die gesamte Stadt, denn wenn der Mietspiegel sinkt, wirkt sich das mietpreisdämpfend auf alle Wohnungen aus. Auch könnten die Erträge aus der Bewirtschaftung in den Bestand reinvestiert werden, statt wie bisher an Aktionäre abzufließen.
Für die neue Anstalt des öffentlichen Rechtes soll nicht das Erwirtschaften möglichst hoher Gewinne an erster Stelle stehen, sondern die Versorgung der Berliner Bevölkerung mit leistbarem Wohnraum. Weitere Aufgaben wären eine möglichst bedarfsgerechte und diskriminierungsfreie Vergabe der Wohnungen, eine nachhaltige Kiezentwicklung, ein konsequenter Klimaschutz und die bedarfsorientierte Instandsetzung und Modernisierung der Bestände.
Wir Berlinerinnen und Berliner ächzen seit Jahren unter zu hohen Mieten. Die Folgen reichen von Gewerbeschließungen, Unsicherheit und Verdrängung bis zu ewig langen Wohnungssuchen und Lock-in-Effekten. Wir wollen endlich selbst entscheiden, wie wir leben wollen und wie unsere Stadt aussehen soll. Wenn wir vergesellschaften, wird ganz Berlin endlich wieder aufatmen können.
IMMOBILIEN AKTUELL 14 KOMMENTAR
Enteignung schafft keine neuen Wohnungen
Prof. Dr. Thomas Beyerle, Head of Research bei Catella und Professor für Immobilienwirtschaft und Immobilienresearch

Die Expertenkommission zur Vergesellschaftung von Wohnungsbeständen großer Bestandshalter ist zu dem Schluss gekommen, dass das deutsche Grundgesetz eine Vergesellschaftung zulässt und dass das Land Berlin diesbezüglich auch Gesetzgebungskompetenz besitzt. Die neue schwarz-rote Landesregierung in Berlin hatte für diesen Fall in ihrem Koalitionsvertrag vereinbart, ein Vergesellschaftungsrahmengesetz zu beschließen, dass einen Rechtsrahmen bildet, objektive qualitative Kriterien für eine Vergesellschaftung definiert und Grundsätze für eine angemessene Entschädigung festlegt.
Gleichwohl: Enteignet werden darf, wenn zum Beispiel Grundstücke oder Immobilien dringend für ein öffentliches Vorhaben gebraucht werden. Denkt man dies zu Ende, wäre die diskutierte Enteignung von Deutsche Wohnen & Co. als Eingriff in den Kapitalmarkt nur der Anfang. Denn der nächste logische Schritt in dieser Kausalkette wäre, dass das Bundesland Berlin selbst als Bauherr am Immobilienmarkt auftritt, um den (enteigneten) Bestand zu sanieren und somit den dringend benötigten Wohnraum zu schaffen. Investoren, also die zuvor enteigneten Geldgeber, werden hier sicher sehr zurückrückhaltend bei Ausschreibungen agieren.
Was soll zudem überhaupt gebaut werden? Neubau ist bei den aktuell hohen bautechnischen und energetischen Anforderungen zu Preisen, welche keine Verzinsung des eingesetzten Kapitals infolge von Preisbindungen und Mietendeckeln zulassen, kaum realisierbar. Es steht zu befürchten, dass der erkennbar überzogene ordnungspolitische Eingriff in den lokalen Wohnungsmarkt und die Außerachtlassung von Grundprinzipien der Ökonomie die Büchse der Pandora öffnet. Wobei es nicht nur um die Reaktion des unregulierten Wohnungsmarktes und seiner Vertreter geht – die Mieten werden erst recht im Bestand weiter steigen –, sondern auch um die Attraktivität des vermeintlich „günstigen“ Wohnbaus für „soziale“ Zwecke. Weiterer Zuzug und Bewerbungen auf „günstige Wohnungen“ werden die Lage eher verschlimmbessern, denn für Entspannung am Wohnungsmarkt sorgen. Die Spirale der Preissteigerungen im Bestand ist klar absehbar.
Es lassen sich stichwortartig zweifelsfrei weitere Argumente anführen, welche die Absurdität dieser Ideologie offenlegen:
• Es entstehen auf absehbare Zeit keine neuen Wohnungen, es wird zu dem bereits skizzierten negativen Effekt auf privatwirtschaftliche Investitionen in den Wohnungsmarkt kommen. Wenn selbst der Regierende Bürgermeister Kai Wegner davor warnt, dass Neubau abgewürgt werden könnte, wird diese Dramaturgie sichtbar.
• Kapitalumlenkung vernichtet Wachstum: Geld, das vom Land Berlin als Entschädigung der Immobilienunternehmen aufgewendet werden müsste, wäre besser angelegt, wenn es in Neubau investiert werden würde.
• Die Erfahrungen mit dem Berliner Mietdeckel lassen grüßen: Das Angebot war über Nacht um die Hälfte eingebrochen, das heißt der problematische Eingriff in die Eigentumsgarantie und die Wirtschaftsverfassung verschreckt Investoren, von denen – wie die Vergangenheit zeigt – zwei Drittel aus dem Privatsektor kommen und häufig eine Wohnung zum Vermieten zur Altersvorsorge erwarben.
• Die Grenze von 3.000 Einheiten, ab der der Immobilienbestand von Unternehmen vergesellschaftet werden soll, ist willkürlich und verstößt gegen das Gleichbehandlungsgebot des Grundgesetzes.
• Die städtischen Wohnungsbaugesellschaften, in die der Bestand voraussichtlich überführt werden würde, haben offenkundig – Stand heute – keine zusätzlichen Kapazitäten, solch eine Anzahl an Wohnungen zu verwalten.
Fazit: Diese Vergesellschaftung ist kein geeignetes Mittel, um das Mietniveau – das Hauptargument der Einteignungsinitiative – niedrig zu halten. Das lehrt nicht nur der Blick in die Geschichte: Auch heute lassen sich noch einige Beispiele einer ideologisch getriebenen, fehlgeleiteten Wohnungspolitik beobachten. Es reicht, dazu mit offenen Augen durch den Ostteil Berlins zu spazieren. Vielleicht sollten die Befürworter der Initiative das einmal tun.
IMMOBILIEN AKTUELL 15 KOMMENTAR
Deutschlands
Immobilien-Hochburgen
Hamburg, Berlin, München oder vielleicht eine ganze Region: Was sind die attraktivsten deutschen Standorte für Immobilienprojekte – und vor allem warum? Wir haben ausgewählte namhafte Entwickler aus verschiedenen Assetklassen um ihre Einschätzung gebeten.
Dieter

Becken, Geschäftsführender Gesellschafter der Becken Holding GmbH:
„Grundsätzlich konzentriert sich Becken auf die Metropolregionen der Top7Standorte Deutschlands. Von daher gäbe es mehrere Städte zu benennen, wobei ich nach Assetklasse und Investmentansatz differenzieren möchte: Mit Blick auf eine langfristige Geldanlage ist München für mich aufgrund der sehr hohen Markt- und Nachfragestabilität der bedeutendste Standort für Büro- und Wohnimmobilieninvestments. Aus Projektentwicklersicht mit Fokus auf eine gesicherte Vermietung von Büros steht Berlin ganz oben auf unserer Investmentliste. Hier ist die Nachfrage nach attraktiven Flächen aktuell höher als in allen anderen Top7Standorten. Mit Blick auf ESG-gerechte Refurbishments von Bestandsimmobilien liegt die Hauptstadt aufgrund der sehr hohen Nachfrage ebenso in
unserem Fokus. In puncto Wohnen –und das betrifft auch das Thema Bauen im Bestand – mache ich kaum einen Unterschied zwischen den Top7. Hier ist überall eine hohe Nachfrage am
Markt vorhanden, allen voran in München. Wenn ich in der Lage wäre, ein Grundstück zu erwerben, das gefördertes Wohnen ermöglicht, würde ich in allen Top7-Standorten investieren.“
IMMOBILIEN AKTUELL 16
notiert von Pierre Pawlik und Matthias Klöppel
TRENDS & TENDENZEN
„Wir sehen in ganz Deutschland einen massiven Bedarf an Pflegeimmobilien, einen besonderen Fokus legen wir aber auf Nordrhein-Westfalen. Aufgrund der hohen Bevölkerungszahl und -dichte ist hier die Nachfrage nach stationären Pflegeplätzen künftig besonders hoch. Zugleich bietet NRW eine gute Anbindung vieler Standorte, ein oft attraktives soziales Umfeld in direkter Nachbarschaft geeigneter Grundstücke und – sehr wichtig bei Pflegeimmobilien – eine gute Personalverfügbarkeit. Auch hat Nordrhein-Westfalen – besser als viele andere Bundesländer – die Investitionskostensätze an die Kostensteigerungen der letzten Jahre angepasst. Das macht das Land für Betreiber und damit auch für uns als Entwickler
Fred-Markus Bohne, Managing Partner für Panattoni Deutschland und Österreich:


„In der Logistikimmobilienentwicklung denken wir nicht in Städten, sondern in Regionen. Betrachtet man diese, so stellt man schnell fest, dass jede Region in Deutschland ihre eigenen Besonderheiten hat. Lokales Verständnis und Expertise sind daher ausgesprochen wichtig. Als Entwickler von Industrie- und Logistikimmobilien, der seine Projekte im Sinne eines ganzheitlichen Ansatzes realisiert, legen wir bei Panattoni stets großen Wert auf die Gegebenheiten vor Ort. Aktuell entwickeln wir vermehrt in den Regionen Berlin, Leipzig und Hannover. So entsteht etwa mit dem Panattoni Park Halle (Saale) Nord ein zukunftsweisendes Neubauprojekt in der Region Leipzig. In der Region Hannover realisieren wir mit dem City Dock Hannover Ost und dem Panattoni Campus Hannover Zentrum sogar zwei Vorhaben gleichzeitig.“
und Bestandshalter attraktiver. Dennoch prüfen wir in Nordrhein-Westfalen jeden neuen Standort vor einer Ankaufentscheidung gründlich, denn auch hier eignet sich nicht jede Region.
Aktuell haben wir vor Ort rund 40 Pflegeheime im Bestand, im Bau oder Projekte bereits notariell gesichert. Darunter sind Standorte wie Essen, Dortmund oder Bochum.“
IMMOBILIEN AKTUELL 17
Christian Möhrke, COO der Cureus GmbH:
TRENDS & TENDENZEN
Kruno Crepulja, Vorstandsvorsitzender und CEO bei


Instone Real Estate:
„Als deutschlandweit tätiger Wohnentwickler haben wir vor allem die wichtigsten Ballungs- und Metropolregionen Deutschlands im Blick – das sind die Top7-Städte plus Leipzig und Nürnberg – da hier der Bedarf an Wohnraum besonders hoch ist. Aber auch gut angebundene Vororte sowie Bund C-Städte in den Metropolregionen gewinnen zunehmend an Attraktivität. Exemplarisch möchte ich hier jedoch Frankfurt am Main herausgreifen. In unserem Projektportfolio (Stand: 31.12.2022) nimmt die Stadt mit rund 31 Prozent im Vergleich zu anderen Metropolen den höchsten Anteil ein. Frankfurt am Main ist wirtschaftliches, finanzpolitisches Zentrum in Deutschland, und es gibt eine Vielzahl von Gründen für die hohe Attraktivität. Die starke Präsenz des Finanzsektors zieht Investoren und Unternehmen an
und sorgt für eine hohe Nachfrage nach hochwertigen Büro- und Gewerbeimmobilien. Darüber hinaus hat Frankfurt am Main eine strategisch günstige Lage in der Mitte Europas und bietet zudem eine hohe Lebensqualität. Sie hat
ein pulsierendes kulturelles Leben mit Theatern, Museen, Galerien und einer lebendigen Musikszene. Darüber hinaus gibt es eine Vielzahl von Restaurants, Bars und Geschäften, die zum urbanen Lifestyle beitragen.“
Albert ten Brinke, Geschäftsführer der Ten Brinke Gruppe:
„In Berlin und in der Region Rheinland / Ruhrgebiet realisieren wir aktuell und in naher Zukunft die meisten Projekte. Berlin verzeichnet seit Jahren ein kontinuierliches Bevölkerungswachstum. Die steigende Nachfrage an Wohnraum führt auch zu einem hohen Bedarf an Wohnbauprojekten. So bauen wir aktuell auf dem ehemaligen Gelände der Firma Siemens am Saatwickler Damm knapp 1.000 Wohnungen. NordrheinWestfalen verfügt mit Städten wie Düsseldorf, Köln / Bonn und Dortmund
natürlich über bedeutende Wirtschaftszentren und das Rheinland / Ruhrgebiet beherbergen eine Vielzahl großer Unternehmen und Industriezweige. Die Nachfrage nach Gewerbeimmobilien ist hoch, da Unternehmen und große Institutionen ihren Hauptsitz oder Niederlassungen in dieser Region haben (möchten). So realisieren wir in Bonn einen kompletten Innovationscampus, für den mit einer Bundesbehörde und dem Deutschen Zentrum für Luft- und Raumfahrt ein Mietvertrag geschlossen wurde. Durch die Vielzahl an Industrie- und Gewerbetreibenden und die dadurch zu besetzenden Arbeitsplätze entsteht auch wieder Nachfrage nach Wohn- und Lebensraum.“
IMMOBILIEN AKTUELL 18 TRENDS & TENDENZEN
Reinhold Knodel, Vorstandsvorsitzender und Alleinaktionär der PANDION AG:
„Die PANDION AG fokussiert sich ausschließlich auf Projektentwicklungen in urbanen Lagen deutscher A-Städte. Wir entwickeln hochwertige
Wohnungen sowie Bürogebäude unter der Marke OFFICEHOME, aber auch städtische Quartiere. Für die Entwicklung von Wohn- und Büroimmobilien
ist Berlin nach wie vor der interessanteste Immobilienmarkt, dicht gefolgt von München und den Rheinmetropolen Köln und Düsseldorf. Das Delta ist nur marginal. Berlin hält mit den dynamischsten Märkten die Spitze. Der Hauptstadtfaktor beeinflusst die hohe und weiterwachsende Nachfrage nach Büro- und Wohnflächen maßgeblich. 2022 wuchs die Zahl der Einwohner um mehr als 75.000 Menschen. Berlin steuert damit auf die magische Zahl von vier Millionen zu. Internationale Unternehmen und solche aus jungen, florierenden Branchen feuern zudem die Nachfrage nach urban gelegenen Büroflächen an. Spannend ist Berlin für uns als Projektentwickler auch wegen des sehr großen Marktvolumens und der im Vergleich zu anderen europäischen Metropolen immer noch spürbaren Unterbewertung der Immobilien.“
Christoph Gröner, CEO der Gröner Group:


„Berlin ist für mich einer der bedeutendsten Immobilienstandorte Deutschlands – natürlich aus beruflicher Sicht als jemand, der als Projektentwickler in dieser Stadt baut, aber auch als Bürger, der sich für eine positive Entwicklung in unserem Land einsetzen will. Denn tatsächlich ist das, was hier in der Hauptstadt passiert, leider beispielhaft für den deutschen Immobilienmarkt: Das Wohnraumangebot verknappt sich immer weiter, dennoch wird kein neues Bauland ausgewiesen. Es finden Demonstrationen gegen steigende Mietpreise statt, zugleich sperrt man sich gegen die Randbebauung des Tempelhofer Feldes.
Damit ist die Hauptstadt wie ein Brennglas für die Situation, die sich in der Baubranche im ganzen Land abzeichnet. Von den hier auftretenden Problemen gewinnen die Politiker im Regierungsviertel ihren Eindruck für
die Maßnahmen, die sie gegebenenfalls bundesweit ergreifen. Wir, die Gröner Group, haben Lösungen für diese Herausforderungen. Wir schaffen es, mit dem Einsatz digitaler und ökologischer
Innovationen Wohnen bezahlbarer und nachhaltiger zu gestalten. Es braucht eine solche Vision für Berlin und für Deutschland, um der aktuellen Lage am Immobilienmarkt zu begegnen.“
IMMOBILIEN AKTUELL 19 TRENDS & TENDENZEN
für Bauunterhalt übersteigen bei weitem die Mittel“
Im Interview spricht Oberkirchenrätin und Architektin Deike Möller, Leiterin des Baudezernates im Landeskirchenamt der Nordkirche, über Erbbaurecht, Stau bei der Bestandssanierung und finanzielle Hürden.
IMMOBILIEN AKTUELL (IA): Die Nordkirche umfasst im Wesentlichen die Länder Schleswig-Holstein, Hamburg und Mecklenburg-Vorpommern. Wie groß ist Ihr Immobilienbestand?
Deike Möller (DM): Die Evangelisch-Lutherische Kirche in Norddeutschland (Nordkirche) unterhält rund 2.400 Kirchen, Kapellen, Friedhofskapellen und Gemeindehäuser, in denen Gottesdienste gefeiert werden. Davon stehen über die Hälfte unter Denkmalschutz, in Mecklenburg-Vorpommern sind es sogar über 90 Prozent. Dazu kommen weitere rund 3.000 Gebäude wie Kindergärten, Weiterbildungseinrichtungen oder Pastorate. Auch von Letzteren stehen allein über 450 unter Denkmalschutz. Ich glaube, diese Zahlen machen die Herausforderungen deutlich, vor denen wir als Nordkirche in diesem Bereich stehen.
IA: Gibt es derzeit aktuelle Neubauprojekte?

DM: Neubauprojekte werden in der Regel von den jeweiligen Kirchengemeinden und Kirchenkreisen verantwortet, die in der Nordkirche den Status einer Körperschaft des öffentlichen Rechts mit dem Recht zur
Selbstverwaltung innehaben. Neu gebaut wird derzeit das Söderblomhaus in Sassnitz (Mecklenburg-Vorpommern). Das alte Gebäude wurde im Juni 2018 durch einen Brand zerstört. Im Neubau entstehen ein Kindergarten sowie multifunktionale Räume, die von der Kirchengemeinde für verschiedene Veranstaltungen genutzt werden können. Träger der Einrichtung wird das Kreisdiakonische Werk Stralsund.
IA: Im Jahr 2012 wurde die Stiftung Kirchliches Bauen in Mecklenburg ins Leben gerufen. Damit werden Arbeiten an kirchlichen Bauten und gottesdienstlich genutzten Gebäuden finanziert. Wie viele Projekte profitieren durchschnittlich pro Jahr davon?
DM: Die Stiftung Kirchliches Bauen in Mecklenburg dient vor allem dem Erhalt der 664 mecklenburgischen Dorf- und Stadtkirchen. Gerade für die Kirchengemeinden im ländlichen Raum ist diese Unterstützung ein wichtiger Baustein, um den Erhalt der Kirchen und ihrer Ausstattung zu sichern. Insgesamt werden jährlich 25 bis 30 Projekte gefördert. Rein auf Bauvorhaben bezogen sind es etwa acht bis zwölf im Jahr.
IA: Können Sie zwei Beispiele nennen und kurz beschreiben, was da gemacht wird.
DM: Im letzten Jahr wurde zum Beispiel die Sanierung des Fachwerkturmes der Kirche Ganzkow (Mecklenburgische Seenplatte) unterstützt, aber auch die Kunstgutinventarisierung in der Propstei Parchim. Die Projekte sind sehr verschieden. Eine Broschüre mit der Auswahl der Förderprojekte der letzten Jahre ist unter folgendem QR-Code verfügbar.
IA: Sanierungsstau ist in vielen Kommunen ein sehr großes Problem: Wie sieht das bei Ihnen aus?
DM: Wir stellen fest, dass die eigentlich notwendigen Aufwendungen für den Bauunterhalt der kirchlichen Gebäude doch bei weitem die Mittel übersteigen, die uns tatsächlich zur Verfügung stehen. Hier war und ist es notwendig, zusätzlich zu den eigenen Mitteln auch Unterstützung aus Gesellschaft und Politik zu erhalten. Auch,
IMMOBILIEN AKTUELL 20 TRENDS & TENDENZEN
„Aufwendungen
damit wir in der kirchlichen Arbeit nicht ‚Steine gegen Menschen‘ ausspielen müssen. Wir sind den Fördermittelgebern, Stiftungen und zahlreichen Spendern außerordentlich dankbar für ihre Unterstützung. Trotzdem werden wir uns mittelfristig der Entscheidung stellen müssen, welche Gebäude wir auf welche Art in die Zukunft tragen können.
IA: Welche Rolle spielen ESG-Anforderungen?
DM: Wir achten in der Nordkirche generell darauf, dass ESG-Belange angemessen berücksichtigt werden. Dies verstehen wir auch als Auftrag, der aus der Botschaft des Evangeliums hervorgeht. Für den Bereich Bau ist dies ausdrücklich im Kirchbaugesetz unserer Nordkirche festgeschrieben. Dort heißt es, dass bei allen Bau- und
Deike Möller hat in Dresden Architektur und anschließend Denkmalpflege und Stadtentwicklung studiert. Ihre berufliche Tätigkeit begann sie in einem Architekturbüro in Dresden. Seit 2013 ist Deike Möller Referentin im Baudezernat des Landeskirchenamtes der Nordkirche in der Außenstelle Schwerin. Dort war sie zuständig für die Begleitung sowie die denkmalrechtliche und kirchenaufsichtliche Genehmigung von Bauvorhaben an Kirchen und Baudenkmalen im Kirchenkreis Mecklenburg. Anfang 2017 wurde sie zunächst stellvertretende Dezernentin und 2019 von der Kirchenleitung zur Dezernentin berufen.

Gestaltungsmaßnahmen sowie beim Betrieb kirchlicher Gebäude auf Barrierefreiheit, Teilhabeförderung und Umweltschutz einschließlich Klimaschutz, Energieeffizienz und Nachhaltigkeit sowie auf die einschlägigen Vorschriften des Denkmal-, Umwelt-, Arbeits- und Gesundheitsschutzes zu achten sei.
IA: Auf der Homepage kirchengrundstuecke.de stehen Häuser, Grundstücke, leer gezogene Kindergärten zum Verkauf: Von welchen Immobilien trennen Sie sich?
DM: Die Entscheidung, für welche Immobilien neue Nutzungen gesucht werden, treffen die Kirchengemeinden in Abstimmung und Beratung mit den Kirchenkreisen. Diese Beratungsprozesse ziehen sich oft über längere Zeit hin. Im Idealfall gibt es
ein zukunftsgerichtetes Konzept der regionalen Kooperation, auf dessen Grundlage entschieden werden kann, welche Immobilien in einer Region weiterhin für die kirchliche Arbeit benötigt werden.
IA: Täuscht der Eindruck oder ist es so: Fast alle Immobilien werden per Erbbaurecht vergeben. Warum?
DM: Die Vergabe im Erbbaurecht ist eine Möglichkeit, bebaute Grundstücke der Obhut anderer zu überlassen. So kann ein Teil der Gebäudelast abgegeben werden und dabei gleichzeitig die geltende Grundstücksrechtsverordnung eingehalten werden. Diese untersagt nämlich die Veräußerung von Grundeigentum der Körperschaften der Nordkirche, mit wenigen Ausnahmen.
Interview: Ivette Wagner
IMMOBILIEN AKTUELL 21 TRENDS & TENDENZEN
Lust auf
Speckgürtel
Die Abwanderung in das Umland ist so stark wie seit 30 Jahren nicht mehr.
Warum der Trend nachhaltig ist und was das 49 Euro-Ticket mit günstigem Immobilienerwerb zu tun hat.
Seit 2018 geht es wieder andersrum. Zogen die Menschen bis dahin fast drei Jahrzehnte lang in die Großstädte, wandern sie seither verstärkt in das Umland ab. Als Hauptgründe hierfür nennt empirica Regio das fehlende Wohnungsangebot und das hohe Preisniveau für Wohnraum in den Top 7-Städten. Die Folge: In Berlin, Hamburg, München und Düsseldorf ist der Zuwanderungssaldo zwischen 2018 und 2021 stark geschrumpft, in Frankfurt am Main, Köln und Stuttgart gab es bereits mehr Wegzüge als Zuzüge. „Immer mehr Menschen sind bereit, längere Fahrzeiten in die Städte auf sich zu nehmen – auch Landkreise in einer Entfernung von einer Stunde und mehr profitieren von der Wanderung“, sagt Jan Grade, Geschäftsführer der auf Immobilienmarktanalysen spezialisierten empirica Regio.
Stadtflüchter meiden ländlichen Raum
Der Trend zur Suburbanisierung betrifft nicht nur die Top 7. Laut einer Studie des Bundesinstitutes für Bevölkerungsforschung (BiB) haben die deutschen Städte mit mehr als 100.000 Einwohnern im Jahr 2021 durch Wegzüge so viel Bevölkerung verloren wie zuletzt 1994. Andersherum ausgedrückt: Die Abwanderung in das Umland ist auf dem höchsten Niveau seit fast 30 Jahren.
Wohin die Städter ihre Wohnsitze verlegen, hat das ifo Institut gemeinsam mit dem Immobilienportal immowelt ermittelt. Demnach zogen 38 Prozent der Befragten in den Speckgürtel und 30 Prozent in eine kleinere Großstadt. Nur neun Prozent bevorzugten eine Kleinstadt und lediglich fünf Prozent den ländlichen Raum.

Dabei sind hohe Mieten und Wohnungsmangel nicht allein ausschlaggebend für das Verlassen der Großstadt. Bei vielen Menschen spielt auch der Wunsch nach mehr Platz, weniger Lärm, einem Garten, mehr Natur oder den eigenen vier Wänden eine wichtige Rolle. Darum prognostiziert das Bundesinstitut für Bau-, Stadt- und Raumforschung
(BBSR) dem Umland weiteres Bevölkerungswachstum. Die höchsten Zuwächse soll es laut BBSR in den Münchner Umlandkreisen Dachau, Erding und Ebersberg sowie rund um die Städte Landshut und Leipzig geben: jeweils mehr als 14 Prozent bis 2040.
Mit dem 49 Euro-Ticket ins Eigenheim
Zusätzlich verstärken dürfte sich der Suburbanisierungstrend durch das 49 Euro-Ticket. Denn wer bereit ist, bis zu einer Stunde Fahrzeit in Kauf zu nehmen, spart im Umland von neun der 14 deutschen Großstädte (über 500.000 Einwohner) im Schnitt mindestens 25 Prozent beim Wohnungskauf. Zu diesem Ergebnis kam eine immowelt-Analyse im April 2023.
Verglichen wurden dabei die Angebotspreise von Bestandswohnungen im Stadtgebiet (drei Zimmer, 75 Quadratmeter, erster Stock, 1990er-Baujahr) mit den Preisen in solchen Umlandgemeinden, die innerhalb von 60 Minuten mit dem öffentlichen Nahverkehr erreichbar sind. Ergebnis: Am meisten sparen lässt sich im Hamburger Umland, denn
22 TRENDS & TENDENZEN
dort kosten Bestandswohnungen im Schnitt 44 Prozent weniger als in der Elbestadt. Rund um Düsseldorf sind es 41 Prozent weniger, im Leipziger Umkreis 40 Prozent, im Kölner Speckgürtel 39 Prozent, im Berliner und im Frankfurter Umland je 38 Prozent und im Dresdner Einzugsgebiet 28 Prozent.
„Das oftmals günstigere Umland bietet vielen Familien nach wie vor die Chance, sich den Traum von den eigenen vier Wänden zu verwirklichen“, betont Felix Kusch, Country Managing Director bei immowelt. Hinzu kommt: Käufer können sich im Umland trotz gestiegener Bauzinsen oft sogar größere Wohnflächen leisten. Im 45-MinutenRadius jeder zweiten Stadt passen laut immowelt mehr als 100 Quadratmeter in das Budget.
Mieters Leid, Investors Freud
Immobilien im Umland sind auch für Kapitalanleger interessant. Sie profitieren neben geringeren Investitionskosten von steigenden Mieten infolge der starken Wohnungsnachfrage. Die Anfragen pro Mietwohnung haben sich 2022 über alle
Mittelstädte hinweg im Schnitt mehr als verdoppelt (plus 137 Prozent). Die Folge: In 99 von 110 Mittelstädten sind laut immowelt die Angebotsmieten innerhalb eines Jahres gestiegen. In Dormagen südlich von Düsseldorf zum Beispiel um 18 Prozent, in Delmenhorst bei Bremen um 14 Prozent oder in Sindelfingen nahe Stuttgart um fünf Prozent. Trotz des Preisanstieges erwartet Remax Germany, dass Umlandgemeinden weiterhin gefragt bleiben, denn sie locken mit günstigeren Kauf- und Mietpreisen und mehr Wohnfläche. Laut einer Remax-Studie wollen 16 Prozent der Deutschen aus der Stadt wegziehen, aber nur sieben Prozent in die Stadt.
Bleibt die Frage, wie lange die Lust auf den Speckgürtel anhält? Kurt Friedl, CEO von Remax Germany, rechnet erst nach 2030 mit einer Reurbanisierung, wenn Millionen Babyboomer in Rente gehen. „Für ältere Menschen bietet die Stadt Vorteile, die auf dem Land nicht unmittelbar zur Verfügung stehen“, so der Experte. Spätestens ab 2036 werde der Zugang zu medizinischer Versorgung, besserer Infrastruktur und Mobilität vielen Menschen wichtiger sein als die ländliche Idylle.

IMMOBILIEN AKTUELL 23 TRENDS & TENDENZEN
Frank Baecke
Dunkelgrün & Dutzendfach
Michael Keune, Managing Director bei Catella Residential Investment Management, spricht mit IMMOBILIEN AKTUELL über Artikel 9-Fonds, über angestrebte 100 energieeffiziente Wohntürme und über ein deutsches Hindernis.
IMMOBILIEN AKTUELL (IA): Catella Residential Investment Management (CRIM) verwaltet zwei Artikel 9-Fonds. Bevor wir zu denen kommen, wie sieht denn der Weg für die „alten“ Fonds aus?
Michael Keune (MK): Als Investment-Manager konzentrieren wir uns seit 15 Jahren auf europäische Wohninvestments für Institutionelle Investoren. CRIM verwaltet und berät sieben Fonds und drei Mandate mit einem verwalteten Vermögen von circa 7,5 Milliarden Euro in zehn europäischen Ländern. Außerhalb unserer beiden Artikel 9-Fonds leisten wir auf Objektebene sukzessive im Rahmen von energetischen Modernisierungen einen wichtigen Beitrag für die ökologische Nachhaltigkeit der Wohngebäude. Dafür haben wir zu Jahresbeginn Spezialisten eingestellt, die unser existierendes Team im Bereich Technisches Asset Management ergänzen. Für uns steht dabei auch die Bezahlbarkeit von Wohnen, also der S-Faktor von ESG, im Fokus. Denn energetische Sanierungen reduzieren den Energieverbrauch deutlich und senken so die Nebenkosten langfristig. Auf diesem Weg kombinieren wir auf der Fondsebene neben den Zielrenditen des Fonds die energetische Qualität der Objekte mit Bezahlbarkeit.
IA: Einer der beiden Artikel 9-Fonds ist der Catella Elithis Energy Positive Fund. Hier sollen ausschließlich energiepositive und möglichst CO₂-neutrale Projekte eingebracht werden, im Wert von etwa 500 Millionen Euro. Auf welche Länder konzentrieren Sie sich?
MK: Der Catella Elithis Energy Positive Fund, kurz CEEPF, fokussiert sich als ‚dunkelgrüner‘ Impact Fonds auf die Errichtung und den Betrieb nahezu CO₂-neutraler und energieeffizienter Wohntürme. Für den Fonds sind wir eine strategische Partnerschaft mit der Elithis Groupe, einem
französischen Entwickler für nachhaltige Gebäudetechnik und Immobilien, eingegangen. Zunächst konzentrieren wir uns auf Frankreich. Hier konnten bereits 25 potenzielle Standorte für die energiepositiven Wohntürme identifiziert werden. Erste Projektentwicklungen wurden inzwischen erworben: Zwei Türme in Dijon und Saint-Etienne, die bereits Mitte 2020 für einen anderen Fonds angekauft wurden, befinden sich kurz vor der Fertigstellung. Drei weitere Projektentwicklungen wurden Anfang 2023 für den Fund erworben. Darüber hinaus sind wir weit fortgeschritten weitere Objekte in Nancy, Clermont-Ferrand und Bordeaux anzukaufen.
IA: Und wie geht es weiter?
MK: Grundsätzlich sollen bis 2030 im Rahmen eines Investitionsprogrammes in Höhe von zwei Milliarden Euro 100 energieeffiziente Wohntürme in ganz Europa errichtet werden – zunächst mit Fokus auf Frankreich, da Elithis als Local Player dort den besten Marktzugang hat. Elithis wird in Frankreich mittlerweile direkt von den Bürgermeistern und Städten angesprochen. Das Interesse an der Kombination von CO₂-effizienten Gebäuden, die darüber hinaus bezahlbaren Wohnraum liefern können, ist groß.
IA: Welche Details zeichnen dieses Anlagevehikel hinsichtlich ESG aus? Oder: Was müssen die Projekte genau haben?
MK: Im Wesentlichen kombinieren wir in dem Elithis Fonds als auch mit den Elithis Objekten im Einzelnen das E, S und G. Die Objekte produzieren mehr Energie als sie verbrauchen. Die Integration von Photovoltaik-Elementen in der Fassade und auf dem Dach bietet eine größere Fläche für die Aufnahme von Solarenergie. In küstennahen Türmen wie in Brest nutzen
wir zudem innovative Windturbinen auf dem Dach, um grünen Strom zu erzeugen. Durch ein bioklimatisches Design und mit der Nutzung erneuerbarer Energien sind die Objekte von Anfang an energiepositiv und können trotzdem zu marktüblichen Baukosten errichtet werden. Die bereits errichteten Wohntürme erfüllen schon jetzt das EU-Klimaziel für das Jahr 2050.
IA: Wie sieht es mit der Drittverwertbarkeit aus?
MK: Die Gebäude sind ‚resilient‘ konstruiert, das heißt sie können sich an verändertes Nutzerverhalten anpassen. Diese ‚Antifragilität‘ der Gebäude reduziert das Risiko von Leerständen in der Zukunft. Als Extrembeispiel könnte man hier das geplante Objekt in Bordeaux erwähnen, dort gibt es keine nutzungsspezifische Genehmigung, das heißt es könnte flexibel von einer Wohn- in eine Büronutzung überführt werden.
IA: Welchen Nutzen haben die Mieter?
MK: Mit Blick auf die sozialen Aspekte profitieren die Mieter erheblich von Einsparungen bei den Energiekosten. Eine Smart-App hilft dabei, Energie durch optimales Nutzungsverhalten zu sparen. So erinnert die App beispielsweise daran, im Sommer, wenn die Sonne scheint, die Jalousien zu schließen, damit sich die Wohnung nicht unnötig aufheizt. Die überschüssige erzeugte Energie aus der Photovoltaik wird – falls nicht selbst genutzt – in das lokale Stromnetz eingeleitet und an die Mieter rückvergütet. Somit sinken die Energie- und Nebenkosten deutlich. Sechs von zehn Mietern können derzeit durch ihr Nutzerverhalten sogar eine positive Energienebenkostenabrechnung erzielen. Dieser doppelte Impact sowohl auf der ökologischen als auch auf der sozialen Seite ist die Voraussetzung für unser Investment.
IMMOBILIEN AKTUELL 24 TRENDS & TENDENZEN
IA: Wohntürme haben ein eher nicht so positives Image. Wie ändern Sie das?
MK: Die Nachfrage nach innerstädtischem Wohnraum ist europaweit sehr hoch. Grund und Boden sind begrenzt. Ein Wohnturm bietet zwei entscheidende Vorteile: eine vergleichsweise hohe Flächeneffizienz und eine geringere Flächenversiegelung. Wir reden bei den Elithis Türmen nicht über Wolkenkratzer. Die Gebäude sind auf 60 Meter begrenzt, was auch bauregulatorisch begründet ist. Das Konzept von Elithis ist für den normalen Mehrfamilienwohnungsbau


mit fünf bis sechs Etagen umsetzbar –den großen Bedarf an Optimierung von Bestandsobjekten mal außen vorgelassen. Die Attraktivität der Türme wird nicht allein durch die umweltfreundliche Nutzung gesteigert, sondern auch durch die Stärkung der Community in der Mieterschaft. Jeder Turm bietet Gemeinschaftsflächen, mit prominenter Lage im Gebäude, beispielsweise auf dem Dach. Die Nutzung ist kostenfrei für alle Mieter möglich. Damit fördern wir die Mieterzufriedenheit und langfristige Mietverträge.
IA: Wie viele dieser Projekte sind für Deutschland geplant? Hier hat ja fast jede Stadt eine andere Hochpunktrichtlinie ...

MK: Nicht nur das, europaweit betrachtet hat jedes Land andere Bauvorschriften und eigene Auflagen für energieeffiziente Gebäude. Aktuell prüfen wir eine Ausweitung auf andere europäische Länder und auch auf Deutschland. Ein wichtiger Punkt ist dabei die Generierung des Mieterstroms mit PhotovoltaikAnlagen. Für Deutschland ist die Regelung nicht klar und eine Gewerblichkeit damit noch nicht ausgeschlossen. Für uns stellt dies klar ein Hindernis dar.
IA: Sind Baugenehmigungen für Wohntürme in anderen Ländern einfacher zu bekommen?
MK: Der Baugenehmigungsprozess ist in vielen Ländern sehr langwierig und zeitaufwendig. Da zeigt sich auch der Heimvorteil von Elithis in Frankreich. Nachdem das erste Energie-positive Wohngebäude 2018 in Strasbourg in Betrieb gegangen ist, und zwei weitere Gebäude in St. Etienne und Dijon, hat die politische Unterstützung in einzelnen Städten deutlich zugenommen.
IA: Können Sie zum Schluss bitte noch ein paar Fakten zu den Renditevorstellungen und zu der Mindestanlagesumme nennen.
MK: Uns ist es wichtig, die Ziele des Fonds im Dreiklang von E, S und G zu verstehen. Neben den ökologischen und sozialen Zielen gilt es auch, finanzielle Ziele zu erreichen. Hier steht die Realisierung einer stabilen, risikoarmen Rendite im Vordergrund. Angestrebt werden vier bis sechs Prozent IRR bei einer Mindestanlagesumme von 25 Millionen Euro. Für unsere beiden Impactfonds ist bei Nichterreichung der festgelegten finanziellen, ökologischen und sozialen Ziele eine Reduktion der jährlichen ManagementFee vertraglich vereinbart, da wir als Catella auch das G (Governance) integrieren wollen. Sollten die gesetzten Ziele nicht erreicht werden, kostet es uns Geld, nach dem Prinzip ‚Skin in the game‘.
Interview: Ivette Wagner
IMMOBILIEN AKTUELL 25 TRENDS & TENDENZEN
Willkommen!


Das Thema Untervermietung spielt auf dem OfficeMarkt wieder eine Rolle. Ob das zu einem ausgeprägten Trend wird, darüber sind sich Experten nicht ganz einig.









































































































Sie sind immer weit vorn: Das Unternehmen Zalando setzte nicht nur im Onlinehandel Maßstäbe, sondern zeigte bereits früh einen Trend am Officemarkt auf. Im März 2023 wurden 15.000 Quadratmeter im neuen Berliner Headquarter feilgeboten. Während hier wohl ein Stellenabbau der Auslöser war, ist es anderswo schlicht und ergreifend das Homeoffice. Laut einer Befragung von Knight Frank wollen die Hälfte der großen Unternehmen mit jeweils über 10.000 Beschäftigten in den nächsten Jahren ihre Büroflächen verkleinern. Im Schnitt sollen zehn bis 20 Prozent aufgegeben werden.



„Untervermietung ist ein erster Hebel“, sagt Sebastian Lindner, Niederlassungsleiter Düsseldorf bei Savills. „Jedoch muss man unterscheiden: Geht es darum, Überkapazitäten aus Effizienzgründen temporär abzugeben oder geht es um einen strategischen Schritt, den Standort aufzugeben.“
RUHR REAL, Experten für das Ruhrgebiet, stellen fest, dass eher größere Firmen ihre Flächen verkleinern. „Gerade beim Mittelstand merken wir, dass die Chefs ihre Mitarbeiter wieder in den Büros haben wollen. Im Gegensatz zu den DAX-Unternehmen oder Großkonzernen halten viele Familienunternehmen oder Kleinunternehmen an ihren Büroflächen fest oder versuchen gerade aus der Krise das Beste aus dem Unternehmen zu erwirtschaften“, konstatiert Geschäftsführer Daniel Hartmann. In Essen gab es nach der Fusion von E.ON und Innogy fast 30.000 Quadratmeter für die Untervermietung. „In Duisburg zum Beispiel sieht das wieder ganz anders aus. Hier gibt es nach wie vor eine geringe Angebotsreserve.“ Daniel Hartmann weist noch auf zwei andere Punkte hin: Zum einen kommen Flächen auf den Markt, die von Start-ups belegt waren, die es nicht zu einer Etablierung geschafft haben. Zum Zweiten stellen
















IMMOBILIEN AKTUELL 26 TRENDS & TENDENZEN
er und sein Team fest, dass die Unternehmen, die untervermieten, die Flächen viel günstiger abgeben als auf dem Markt üblich. Einige Experten warnten hier bereits vor einem Preisrutsch der Mieten insgesamt. Der ist aber bisher nicht eingetreten.
Ausbau und Mietzeiten als Hemmnis
Bei der Angermann Investment Advisory AG heißt es für Frankfurt am Main: „Es besteht ein großes Volumen an Untermietflächen.“ Diese seien jedoch fokussiert auf Backoffice-Standorte von Großkonzernen, der Leerstand im CBD sei sehr gering, „demnach werden Untermietflächen sehr schnell absorbiert“. Übereinstimmend sehen die Experten die Untervermietung durchaus als kompliziert an. Dieser Markt zeichne „sich durch eine höhere Kompromissbereitschaft aus“, führt Sebastian Lindner von Savills an. Für Angermann „scheuen viele Nutzer und Eigentümer ein Untermietverhältnis und versuchen eher ein Direktmietverhältnis zu erzielen und zu verhandeln“. Die Vorstellungen
über den Ausbau und Mietzeiten sind laut dem Analysehaus Colliers dabei die großen Hürden.
Martin Ballweg, Gründer und CEO des Flex-OfficeAnbieters Scaling Spaces, benennt das neue Phänomen „Phantomleerstand“. Es sei erschreckend, wie viele Flächen –teilweise auch Neubauten – zur Verfügung stehen würden. Genau zu beziffern ist der Wert nicht. Wahrscheinlich wird der Markt hier noch steigende Werte sehen. „Der Schmerz ist bei vielen nicht groß genug“, so Martin Ballweg. Aus seiner Sicht kommen in Berlin beispielsweise nur Flächen innerhalb des S-Bahn-Ringes in Frage. Vor allem, wenn es um den Umbau in flexible Flächen geht. Scaling Spaces baut die Büros dann so um, dass sie für unterschiedliche Firmen nutzbar sind.





Im August 2023 goss PwC mit der dritten Studie zum Thema Homeoffice noch Wasser auf die Untervermietungsmühle: „Das Homeoffice hat als Arbeitsort für alle Generationen und über Branchen hinweg an Bedeutung gewonnen“, heißt es da. Und: „Eine vollständige Rückkehr ins Büro wird es zukünftig nicht mehr geben.“






 Ivette Wagner
Ivette Wagner
Prüfungsvorbereitungskurse für Auszubildende zum/zur Immobilienkaufmann/ -frau | Berufsbegleitende Fortbildung zum/zur
„Geprüften Immobilienfachwirt/-in (IHK)“




IMMOBILIEN AKTUELL 27 TRENDS & TENDENZEN Mitteldeutsche Fachakademie der Immobilienwirtschaft e.V. Der Bildungsanbieter für die Wohnungs- und Immobilienwirtschaft www.mfa-erfurt.de Alle Informationen und das aktuelle Bildungsprogramm finden Sie auch auf unserer Website: Moderne Schulungsräume in Erfurt | Erfahrene Referentinnen und Referenten | Enger Kontakt zur Wohnungswirtschaft –hoher Praxisbezug | Seit mehr als 30 Jahren am Bildungsmarkt Ein- und Mehrtagesseminare | Online-Seminare
| Lehrgänge |
Acht auf einen Streich
Gleich acht neue Hochhäuser werden in den kommenden Jahren das Stadtbild von Jena dauerhaft verändern. Dass plötzlich so viel in die Höhe gebaut wird, liegt am wachsenden Flächenbedarf der Stadt und ihrer Einbettung in ein von Bergen umgebenes Saaletal.

Wer Jena mit einem Wort beschreiben soll, dem dürfte aufstrebend in den Sinn kommen. Das Attribut beschreibt recht zutreffend die wachsende Bedeutung der Stadt als Zentrum von Wissenschaft und Hochtechnologie, schließt im weiteren Sinne aber auch das Kulturangebot, die Gastronomie und das von Studenten und jungen Familien geprägte Stadtleben mit ein. Diese Aufzählung muss künftig um die Architektur erweitert werden. Denn in Jena streben in den kommenden Jahren acht moderne Hochhäuser in den Himmel.
Hochhaustradition seit 1915
Nun ist es ja nicht so, dass Hochhäuser für Jena ein Novum wären. Dem Unternehmen Carl Zeiss verdankte die Stadt 1915 mit dem Bau 15 das erste Hochhaus Deutschlands (42 Meter). Es folgten 1935 der Bau 36 (66 Meter) und 1965 der Bau 59 (67 Meter) sowie 1972 der JenTower, der mit 144,5 Metern bis heute das höchste Hochhaus in den neuen Bundesländern ist. Im Mai 2020 kam mit dem K1 das erste Hochhaus nach der Wende hinzu, ein 35 Meter hohes Wohnund Geschäftsgebäude im Stadtteil Lobeda. Dass diese fünf
Hochpunkte, die in mehr als 100 Jahren entstanden, nun acht Geschwister auf einmal bekommen, erklärt Stadtentwicklungsdezernent Christian Gerlitz mit der Lage Jenas in einem schmalen Saaletal zwischen waldbedeckten Hängen: „Wir wollen Wachstum ermöglichen, aber auch den Naturund Landschaftsraum erhalten. Das heißt: Wir müssen im Innenbereich und in die Höhe wachsen.“
Eichplatz und dotSource-Campus
Allein drei der acht neuen Hochhäuser entstehen auf dem Eichplatz direkt im Herzen der Stadt. Die von der STRABAG Real Estate geplanten Gebäude werden 65, 50 und 33 Meter hoch sein beziehungsweise 20, 14 und zehn Geschosse haben. Insgesamt bietet das Ensemble 148 Wohnungen, dazu 7.700 Quadratmeter für Büros, 4.160 Quadratmeter für Läden und Gastronomie sowie 90 Tiefgaragenstellplätze. Das B-Plan-Verfahren läuft bereits.
Einen vierten Hochpunkt plant die dotSource GmbH auf dem Gelände der Alten Feuerwache an der Saalbahnhofstraße. Hier will die Jenaer Digitalagentur bis Ende 2027 einen neuen Firmencampus errichten. Eyecatcher wird ein 66 Meter hoher Wohnturm sein, der den sechsgeschossigen Bürokomplex um zehn Stockwerke überragt. Mehr als 10.000 Quadratmeter Bürofläche sowie 50 Wohnungen sollen im dotSource-Campus entstehen, dazu eine Tiefgarage, ein Supermarkt, ein Restaurant und ein Park. Der Aushub der Baugrube ist für Frühjahr 2024 angesetzt.
Uni-Hochhaus und Quartier 22
Auf dem Inselplatz erfolgte der Aushub für Hochhaus Nummer fünf bereits, ebenso der Hochbau und das Richtfest. Rund 65 Meter ragt der Rohbau in die Höhe, der bald neuer Sitz des Institutes für Psychologie sein wird. Auf 15 Etagen entstehen ein Hörsaal sowie Seminar-, Behandlungs- und Versuchsräume. Das Hochhaus ist Teil des neuen Universitätscampus, der in Zukuft auch die Fakultät für Mathematik
IMMOBILIEN AKTUELL 28 TRENDS & TENDENZEN
und Informatik, ein Rechenzentrum, ein Parkhaus, eine Cafeteria und eine Bibliothek beherbergt.
Nicht für Studien-, sondern für Wohn- und Gewerbezwecke ist das Quartier 22 am Steinweg konzipiert, zu dem das Hochhaus Nummer sechs gehört – ein rund 49 Meter hoher Turm am Eisenbahndamm. Die ersten vier Etagen über der Tiefgarageneinfahrt sind für Büros und Technik vorgesehen, die folgenden zehn Etagen für Wohnungen.

Solarquartier und Columbus Center
Ebenfalls 49 Meter wird das Hochhaus Nummer sieben am Spittelplatz in den Himmel reichen: als Entrée in das künftige Solarquartier zwischen Saalbahnhofstraße und Am Anger. An das Hochhaus mit 15 Etagen schließen fünf- bis siebengeschossige Häuser an, deren versetzte Fassaden ebenso wie die Südfassade des Hochhauses mit Photovoltaik-Modulen ausgestattet sind. Insgesamt werden hier 200 Wohnungen entstehen. Baurecht könnte bis 2024 geschaffen werden.

Deutlich kleiner fällt Hochpunkt Nummer acht im Ortsteil Winzerla aus. Der 35 Meter hohe Elfgeschosser für Wohnungen und Einzelhandel ist Teil eines geplanten Gebäudekomplexes, der das Einkaufszentrum Columbus Center ersetzen soll. Im März 2023 hatte der Stadtrat sein Ja zur Einleitung des vorhabenbezogenen Bebauungsplanes gegeben. Im September 2024 könnte der Satzungsbeschluss vorliegen. Und was halten die Jenaer von all dem Streben
nach Höherem? „Viele Bürgerinnen und Bürger nehmen den Zuwachs an Hochhäusern als Teil der dynamischen Entwicklung der selbstbewussten Stadt Jena wahr. Aber: Anwohner, in deren Nachbarschaft ein Hochhaus entsteht, sorgen sich auch vor Verschattung, mikroklimatischen Veränderungen oder zusätzlichem Verkehr”, schildert Christian Gerlitz die Stimmungslage. Der Stadtentwicklungsdezernent hält aufgrund des Flächenbedarfes noch weitere Hochhausprojekte für möglich. Potenzielle Standorte seien bereits untersucht worden. Kurzum, es bleibt dabei: Für Jena gibt es wohl kein zutreffenderes Attribut als aufstrebend.
Frank Baecke
IMMOBILIEN AKTUELL 29
Newcomer mischen die Branche auf
Digitalisierung wird in der Immobilienwirtschaft immer stärker gewichtet. So ist es nicht überraschend, dass auch die Zahl der Jungfirmen, welche Transparenz und Vereinfachungen versprechen, in die Höhe schießt. Ende 2022 waren allein im PropTechSektor fast 800 Unternehmen in Deutschland aktiv. Vier dieser Start-ups und ihre verschiedenen Lösungen für die Immobilienbranche stellt IMMOBILIEN AKTUELL vor.
FinList – Vergleichsportal für gewerbliche Immobilienkredite
Die FinList GmbH hat es sich zum Ziel gesetzt, gewerbliche Immobilienfinanzierung direkt und transparent zu gestalten. Gelingen soll dies durch die hauseigene Software, über die Finanzierungsangebote möglichst automatisiert vermittelt werden. Die Software digitalisiere und verschlanke den Such- und Anfrageprozess und ermögliche somit schnellere Abschlüsse. Mit dieser Geschäftsidee richtet sich das Start-up aus Hohen Neuendorf bei Berlin, das nicht an Provisionen, sondern an Paketpreisen verdienen wolle, sowohl an Kreditgeber und -nehmer als auch an Makler und Vermittler. Gegründet wurde FinList im Jahr 2021 von Sandra Olschewski und Florian Hollm. Der Leitgedanke des Brandenburger Unternehmens ist, dass Kreditnehmer und
N Robotics – Mobile Robotik für die Baustelle
Kreditgeber selbst den Finanzierungsprozess steuern. Die Kontrolle liege während des gesamten Prozesses bei den Nutzern, wie es von dem Real Estate Fintech heißt. FinList wirbt außerdem damit, alle gelisteten Kreditgeber gewissenhaft zu überprüfen, zu verifizieren und zu strukturieren. Das Projektvolumen in der Software betrage aktuell über drei Milliarden Euro.
Das Start-up hat laut eigener Darstellung bereits mehr als 300 Kunden von sich überzeugt und konnte die Strategis AG und ThinkImmo überdies als Partner gewinnen. www.finlist.de
 Laura Dommel
Laura Dommel
Der Einsatz von Robotern in der Bauindustrie ist momentan für viele Unternehmen noch Zukunftsmusik. Dabei könnten Roboter die Arbeit in der Branche erheblich erleichtern. Besonders gefährliche oder körperlich belastende Aufgaben würden mit ihrer Hilfe sicherer und präziser ausgeführt werden. Oftmals steht der Umsetzung allerdings die aufwendige und komplizierte Programmierung im Weg. Hier setzt die N Robotics GmbH an. Das Berliner Startup will durch seine Produkte einen fairen und vereinfachten Zugang zu Roboter-Technologien gewährleisten und diese weitreichend verfügbar machen. Dafür bietet es nach eigenen Angaben maßgeschneiderte Technologien und Robotik Lösungen an, die speziell an Kundenwünsche und je nach Verwendung angepasst werden. Somit sind die einzelnen Produkte branchenübergreifend anwendbar.
Im Jahr 2021 von Elisa Czerski gegründet, blickt N Robotics auf eine breite Produktpalette, die das gesamte Ökosystem rund um Robotik beinhalte. Der ROS Remote Controller ermögliche es beispielsweise, einen Roboter mithilfe von vier Joysticks gezielt zu steuern. Somit könne dieser auch ganz ohne Coding-Kenntnisse kontrolliert und angewiesen werden. Das Start-up behauptet, bereits mit mehr als 20 Unternehmen und akademischen Einrichtungen weltweit zusammenzuarbeiten.

www.nrobotics.com
Laura Dommel
IMMOBILIEN AKTUELL 30 TRENDS & TENDENZEN
Voltaro – Komplettanbieter für Photovoltaik-Projekte
Die Münchner Voltaro Energy GmbH unterstützt Immobilienunternehmen dabei, bestehende Gewerbegebäude nachhaltiger zu betreiben. Im Mittelpunkt steht dabei die Installation von Photovoltaik-Anlagen auf den Dächern. Dafür bietet das im Jahr 2021 gegründete Start-up eine All-inOne-Plattform, die seine Kunden in die Lage versetzen soll, Gebäude aus dem gesamten Bundesgebiet zu analysieren, wettbewerbsfähige Angebote zu erhalten und Kosten in Umsetzung und Betrieb einzusparen.
Photovoltaik-Projekte, die auf der Plattform zu finden sind, hat Voltaro nach eigenen Angaben bereits vorab ausführlich geprüft, beispielsweise hinsichtlich Statik, Dachqualität, Brandschutz und öffentlicher Genehmigungen. Das von Alessandro Mauri und Jannik Bounin geführte Unternehmen wirbt überdies mit kostenloser Gebäudeportfolio-Analyse, individueller Beratung und Einschätzung der Wirtschaftlichkeit, Nachhaltigkeit und rechtlicher Aspekte. Wenn sich ein Kunde für ein Photovoltaik-Vorhaben entscheidet, übernimmt Voltaro den gesamten Projektablauf: von der Koordination bis zur Inbetriebnahme. Das Start-up habe bereits über 60 Unternehmen erfolgreich begleitet und mehr als 2.500 Gebäude mit Potenzial für Dach-Photovoltaik identifiziert, teilt es in eigener Sache mit. www.voltaro.de
Joline Becker
einwert – Hybrider Gutachter für Immobilienbewertung
Nach Ansicht von Dr. Christina Mauer und Dr. Maximilian Schlachter besteht im Bereich der Immobilienbewertung ein massives digitales und innovatives Defizit. Deshalb hat das Duo im Jahr 2022 die einwert GmbH gegründet. Das PropTech-Start-up aus München hat es sich zur Aufgabe

gemacht, mit einem hybriden Ansatz das Gutachtengeschäft für institutionelle Investoren zu erleichtern. Das Geschäftsmodell: Immobiliengesellschaften geben bei einwert Gutachten digital in Auftrag – entweder über das eigene System mittels Schnittstellen oder über die Plattform des Start-ups. Anschließend besichtigen von einwert beschäftigte Gutachter sowie Partner das Objekt und bewerten dieses in einer Software. KI-unterstützte Tools helfen zusätzlich dabei, Daten für die Bewertung zu beschaffen und auszuwerten, Dokumente auszulesen und die Gutachten auf Basis dieser Daten zu schreiben. einwert sieht sich als führender Hybridgutachter in Europa. Im Unterschied zu weiteren Wettbewerbern stehen bei dem Jungunternehmen rechtssichere, zertifizierte Gutachten am Ende des Bewertungsprozesses. Hatte sich das Start-up in der Anfangsphase auf Süd- und Ostdeutschland fokussiert, will es ab Herbst 2023 ganz Deutschland in den Blick nehmen. Unter den bislang gewonnenen Kapitalgebern sind nach eigenen Angaben unter anderem 468 Capital und Auxxo. www.einwert.com

IMMOBILIEN AKTUELL 31 TRENDS & TENDENZEN
Joline Becker
Alles anders am Behrens-Ufer

Die DIE Deutsche Immobilien Entwicklungs AG strebt für ihr Gewerbeareal in Berlin-Oberschöneweide Superlative an. Sie setzt auf ein Energiekonzept, das Strom und Wärme aus 4.500 Metern Tiefe gewinnt. Flankiert wird das System durch Photovoltaik-Anlagen an Fassaden und innovative Speicher- und Gebäudetechnik.
Auf dem Areal in der Ostendstraße am Spreeufer in Oberschöneweide wurde von 1917 an Industrie- und Architekturgeschichte geschrieben. Jetzt haucht die DIE Deutsche Immobilien Entwicklungs AG (DIEAG) dem 100.000 Quadratmeter großen Gelände neues Leben ein und will damit ein neues Kapitel Geschichte schreiben. Felix Gold, Geschäftsführer der DIEAG, betont: „Wir haben uns 2020 entschieden, nicht nur wirtschaftlich nachhaltig, sondern inhaltlich nachhaltig zu agieren.“ Bis 2028 werden für mehr als eine Milliarde Euro auf rund 283.000 Quadratmetern Bruttogeschossfläche neue Gewerbeflächen errichtet. Darunter befinden sich rund 30 Prozent sanierte Flächen im denkmalgeschützten Bestand wie beispielsweise dem berühmten Peter-Behrens-Bau. Eines der ambitionierten Ziele ist die Energieversorgung, die man vollständig vor Ort gewinnen will. Die Energiekrise spielt den Entwicklern dabei
in die Hände. Denn inzwischen ist in der breiten Öffentlichkeit angekommen, dass Energieautarkie weder ein Spleen noch ein Werbetrick ist. Die Abhängigkeit vom Gas muss beendet und für Innovationen Kapital eingesetzt werden.
Kombination innovativer Ansätze
Das Besondere des Energieversorgungs-Konzeptes ist die Kombination verschiedener innovativer Ansätze. Im Kern wollen die Entwickler am Behrens-Ufer auf Tiefengeothermie setzen. In Deutschland gibt es noch nicht viele Anlagen dieser Art, aber Gemeinden wie zum Beispiel Geretsried in Bayern versuchen inzwischen ganz tief aus der Erde Energie für die Wärmeversorgung zu gewinnen. „Dafür wird ein Loch bis in eine Tiefe von 4.500 Meter gebohrt, wo eine Temperatur von bis zu 160 Grad Celsius herrscht“, erklärt Felix Gold. Mit ZÜBLIN, beziehungsweise der STRABAG, haben sie einen Partner, der in der Lage ist, bis in diese Tiefe zu bohren. In einem geschlossenen System mit eingehängtem Wärmetauschrohr zirkuliert eine Wärmeträgerflüssigkeit (zum Beispiel Wasser), die sich an einem dafür entwickelten Wärmetauscher erhitzt und über ein wärmeisoliertes Innenrohr wieder an die Oberfläche befördert wird. Über die Verdampfung von Ammoniak treibt es dann in einem weiteren, mittels Wärmeübertragung erhitzten Kreislauf, Generatoren und Turbinen zur Stromproduktion an. Die Verteilung erfolgt über ein Kaltwärmenetz. Da tiefe Erdwärmesonden einen geschlossenen Kreislauf besitzen, erfolgt kein Eingriff in Stoffgleichgewichte des Gesteins.
Derzeit werden die Anträge für die seismische Bodenuntersuchung vorbereitet. Bei einer Tiefe von mehr als 100 Metern ist nicht mehr das Land Berlin, sondern das Bergbauamt Cottbus zuständig. Die Entwickler hoffen daher, dass das Land Berlin das Behrens-Ufer zu einem von drei Vorhaben erwählt, die Förderung erhalten. Die Förderung als Pilotprojekt würde die Wichtigkeit des Standortes zusätzlich unterstreichen. Felix Gold sagt: „Das kann eine
32
PROJEKTE & VORHABEN
Schlüsseltechnologie für die Stromversorgung sein und deshalb möchte ich sie jetzt auch in der Umsetzung sehen.“
Die Erdwärme ist nicht die einzige nichtfossile Energiequelle, die Nutzung findet. Flankiert wird das System durch Photovoltaikanlagen für die Sonnenenergiegewinnung. Da die Dächer des Gewerbeareals stets für die Mieter und die Öffentlichkeit zugänglich und begrünt sein sollen, kommen mit Photovoltaik-Modulen verkleidete Fassaden zum Einsatz. Damit der Solarstrom direkt zur Verfügung steht und Transformations- sowie Leitungsverluste vermieden werden, ist ein Niederspannungsnetz geplant. Um auch im Winter ausreichend mit Energie versorgt zu sein, sind entsprechende Speicher, für Wärme auch Eisspeicher, konzipiert. Rund 93 bis 97 Prozent des benötigten Stromes und der Wärmeenergie gewinnt man zum jetzigen Entwicklungszeitpunkt bereits aus nachhaltigen Quellen vor Ort, versichert Felix Gold. Das Areal ist mit einer technischen Redundanz für die Energieversorgung gesichert, sodass auch bei Teilausfällen Energie zur Verfügung stehen kann. Im Notfall wird zudem auf einen externen Anschluss zugegriffen.
Lehmdecken kühlen und heizen
Die Gebäudetechnik ist auf sparsamen Umgang mit Energie ausgerichtet. So werden wasserführende Lehmdecken eingezogen, über die die Gebäude im Sommer Kühlung und im Winter Heizung erfahren. Was einst in klimatisierten Gebäuden nicht möglich war, ist hier Teil des Konzeptes: Die Fenster lassen sich zum Lüften öffnen und schließen. Um Strom für Licht zu sparen, bekommen dunkle Räume, etwa Keller oder die Tiefgarage mit Hilfe von Tageslichtleitern aus Glasfaser genügend Helligkeit. Das Nachhaltigkeitskonzept geht jedoch weit über die Frage der Energie hinaus. Das Regenwasser wird aufgefangen und dient als Brauchwasser und zur Bewässerung der Grünanlagen. Gebaut wird nicht in Beton, sondern in HolzHybrid-Bauweise. Für die drei Bauabschnitte Nord, Süd und
Ost werden mehrere renommierte Architekturbüros für die Entwurfsplanung beauftragt. Dadurch soll eine Vielfalt mit unterschiedlichen Handschriften entstehen, die aus den Federn von GMP und Störmer Murphy and Partners sowie Tchoban Voss Architekten kommen. Letztere zeichnen unter anderem für das Gebäude A 2.2 verantwortlich. Es überragt die Berliner Traufhöhe und gilt daher als Hochhaus. Dieses markante Objekt wird nicht nur vollständig mit Holz verkleidet, sondern verfügt über tragende Holzaußenwände, Holzstützen und Holzverbunddecken. Dahinter steht die Idee, dass das Material eines Tages recycelt werden kann. Und dieser Ansatz spiegelt sich in allen Bereichen wieder. So ist ein verpackungsarmer Supermarkt mit 2.000 Quadratmetern Verkaufsfläche vorgesehen. Gastronomie und Markt bekommen dann Lieferungen von Gemüse, Kräutern und Pilzen, die auf dem Gelände in Vertikal-Farmen und in den Kellern gezogen und geerntet werden. Sogar eine Fischzucht ist angedacht. Der Abfall des einen könnte als Nährboden für den anderen dienen. Außerdem sind 82 Gastro-Spots geplant, vom Imbiss bis zum Edelrestaurant. „Wir schaffen in den Gebäuden die Voraussetzungen für Kreislaufwirtschaft“, sagt Felix Gold. „Denn wir wollen das Gelände weitgehend regional versorgen und setzen, so weit wie möglich, den Do-Not-Harm-Gedanken um.“

 Mara Kaemmel
Mara Kaemmel
33
PROJEKTE & VORHABEN
New Work trifft Mobilität
Umsteigefreundliche Reiseangebote in Kombination mit Bürowelten, Co-Working, Gastronomie und Serviced Apartments – der Dresdner NetWorkHub soll ein Leuchtturmprojekt und Best Practice für urbane Mobilitäts-Hubs werden. Aufhorchen lässt auch das umfangreiche Begrünungskonzept sowie hoher ESG-Standard.
Dach- und Fassadenbegrünungen werden in Zeiten des Klimawandels immer mehr zum Standard. Pflanzen an der Gebäudehülle kühlen und befeuchten die Luft, besonders in urbanen Hitzeinseln. Sie binden Staub und Schadstoffe, dämmen eine Immobilie gegen Straßenlärm und Auskühlung. Neben diesen mikroklimatischen Vorteilen bringt die vertikale Flora auch eine Steigerung der Lebensund Wohnqualität mit sich, entsprechen Begrünungssysteme an und auf Gebäuden doch dem menschlichen Bedürfnis nach einer natürlichen Umgebung. In seinem Positionspapier hebt der Bundesverband GebäudeGrün den hohen ökologischen und gestalterischen Nutzen von Dach- und Fassadenbegrünungen hervor. Diese müssten daher „ein selbstverständliches Instrument in der Stadtentwicklung“ werden, heißt es darin, „um Städte zu schaffen, in denen wir auch in Zukunft noch gerne leben“.
Es sind Einschätzungen wie diese, auf denen Dr. Ingo Seidemann seine eigenen Ambitionen gründet. Der Geschäftsführer der S & G Development GmbH legt bei seinen Projekten großen Wert auf Nachhaltigkeit und Umweltbewusstsein. Exemplarisch dafür steht der NetWorkHub, ein 250 Meter langes Gebäudeensemble, das in den nächsten Jahren an der Westseite des Wiener Platzes in Dresden, direkt neben dem Hauptbahnhof der Landeshauptstadt, in die Höhe wächst und gleich mehrere Funktionen in sich vereint. Ein integraler Bestandteil des Neubaus ist eine innovative Fassadenbegrünung, die sich entlang großer Teile der glasdominierten Fassade erstreckt. Zusätzlich werden eine horizontale Balustradenbegrünung auf einer der Öffentlichkeit zugänglichen Plaza-Ebene sowie intensiv und extensiv begrünte Dächer sowie Biodiversitätsflächen realisiert, teilweise mit Photovoltaik versehen. „Mit diesem
Konzept wollen wir den Hitze ausstrahlenden, hochversiegelten Flächen in der Umgebung stadtklimatisch mildernd entgegenwirken“, hält Dr. Ingo Seidemann fest.
Adressbildende Architektur
Sein Unternehmen S & G ist ein Spezialist für die Entwicklung kleiner, mittlerer und größerer Gewerbeobjekte in den Bereichen Büro, Einzelhandel, Hotel und Sonderimmobilien. Mit dem NetWorkHub zeigt der Entwickler aus Leipzig und Frankfurt am Main, dass nachhaltige Gebäude auch ästhetisch ansprechend sein können. So startet der Komplex, entworfen vom deutschlandweit bekannten Architekturbüro KNERER UND LANG, mit einem zehngeschossigen Hochhaus am Wiener Platz als repräsentativen städtebaulichen Abschluss des Wiener Platzes nach Westen als weithin sichtbare Markante und Anziehungspunkt mit einladendem Foyer. Die rückwertigen, in der Höhe gestaffelten Baukörper werden von hier aus über eine großzügige, fünf Meter breite Freitreppe erschlossen. Diese führt zur PlazaEbene, die den Wiener Platz nach Westen fortführt und den öffentlichen Stadtraum um eine hohe Aufenthaltsqualität mit Aussicht auf die City und den quirligen ein- und ausfahrenden Bahnverkehr des Hauptbahnhofes bereichert. Die langgezogene Anordnung des Neubaus resultiert aus der schmalen Form des rund 7.100 Quadratmeter großen Grundstückes, das obendrein von Bahn- und Straßenbahngleisen umrahmt wird. S & G hatte das Areal im Herbst 2021 von der Stadt Dresden erworben. Dem entsprechenden Bebauungsplan erteilte der Stadtrat Ende 2022 grünes Licht. Um das Grundstück bebaubar zu machen, mussten

IMMOBILIEN AKTUELL 34 ADVERTORIAL
gut 25.000 Kubikmeter beziehungsweise 40.000 Tonnen Erdmasse entfernt sowie eine vier Meter hohe und 50 Meter lange Spundwand an den Gleisen der Deutschen Bahn zurückgebaut und umfangreiche Sicherungsbauwerke entlang der Gleisanlagen errichtet werden.
Bürowelten der Zukunft
Herzstück des NetWorkHub bilden sehr moderne, auf die Anforderungen an anspruchsvolle Büro- und IT-Arbeitswelten eingehende Officeflächen im Umfang von rund 15.000 Quadratmetern. Diese befinden sich in den oberen Etagen und sind für hunderte Arbeitsplätze vorgesehen. „Ganz im Sinne der Post-Pandemie-Ära legen wir einen besonderen Fokus auf optimal auf Nutzerbedürfnisse konfigurierbare Flächen samt erstklassiger digitaler Infrastruktur”, bewirbt Dr. Ingo Seidemann den Officebereich. Um diesen herum gruppieren sich diverse Service-Angebote: Co-Working- und Konferenzflächen, Gastronomie und Catering sowie mehr als 100 Serviced Appartments stehen sowohl Nutzern im Hause als auch auswärtigen Gästen für Übernachtungen zur Verfügung. Dass es solche zeitgemäßen, ESG-konformen Angebote auf dem Dresdner Büromarkt braucht, zeigt die hohe Nachfrage, die laut Aengevelt das vorhandene Angebot übersteigt. Zum Jahresende 2022 habe der Leerstand mit nur rund 3,5 Prozent merklich unterhalb der Fluktuationsreserve gelegen.

Mit dem Neubau schafft S & G neben einer hochwertigen Arbeitsumgebung auch einen multimodalen Verkehrsknotenpunkt. So entsteht im Erdgeschoss ein neues Fernbusterminal mit zehn überdachten Bussteigen. Darunter

ist ein Parkhaus für 800 Fahrräder angesiedelt, das zudem über Lademöglichkeiten für E-Bikes, abschließbare Boxen und eine Fahrradwerkstatt verfügt. Abgerundet wird das Mobilitätskonzept durch die Integration einer neuen Straßenbahnhaltestelle sowie die Verknüpfung mit dem Königspavillon direkt gegenüber, der auf kürzestem Wege Zugang zu den Regional- und S-Bahn-Gleisen des Hauptbahnhofes gewährt.
DGNB-Platin- und ESG-Zertifizierung
Von der Deutschen Gesellschaft für Nachhaltiges Bauen e.V. (DGNB) winkt dem NetWorkHub eine Auszeichnung mit dem Platin-Zertifikat, der höchsten Bewertungsstufe der Organisation. Diese entspricht einem Gesamterfüllungsgrad von mindestens 80 Prozent und einem Mindesterfüllungsgrad von 65 Prozent in allen fünf ergebnisrelevanten Themengebieten. „Überdies soll eine ESG-Zertifizierung stattfinden“, so Dr. Ingo Seidemann. Besondere Nachhaltigkeits-Kriterien seien beim NetWorkHub unter anderem die effiziente Haustechnik, das Fahrradparkhaus, die große Photovoltaikanlage – und eben das außergewöhnliche Begrünungskonzept.

IMMOBILIEN AKTUELL 35 ADVERTORIAL
Dr. Ingo Seidemann, Geschäftsführer S & G Development
für zehn Jahre zugesichert. Weitere gut 1.000 Quadratmeter mietet die Gastronomiekette L’Osteria, einschließlich einer Terrasse im Erdgeschoss.
Unverwechselbares Äußeres
Der nach Fertigstellung weithin sichtbare Gewerbeneubau wird von einem einheitlichen Sockel mit auffälligen Arkadenbögen getragen. Die Entwickler werben mit einer Farbwahl, die regionale Kleinteiligkeit trifft und an den regionaltypischen Sandstein der Kaiserburg erinnert. Eine aufwändige Glas-Elementfassade soll ebenfalls als Blickfang dienen. Die umliegenden Gebäude, welche offen zur Straße und ebenfalls zum Platz liegen, behalten die Arkadenstruktur bei. Auf dem Quartiersplatz der Neuen Mitte Thon sind unter anderem Springbrunnen und Schatten spendende Bäume geplant.
Dennoch orientiert sich das Projekt nicht nur an architektonischen Highlights, S & P will damit auch hohe Nachhaltigkeitsstandards realisieren. „Retentionsflächen auf den Dächern und Außenanlagen sowie eine eigene Versickerungsanlage werden künftig die vollständige Versickerung von Niederschlägen auf dem Grundstück ermöglichen, das zuvor komplett versiegelt war“, betont der geschäftsführender Gesellschafter Sven Sontowski. Mit

Ein Turm zum (Ver-)Schmelzen
Im Nürnberger Nordwesten entsteht der neue Business-Tower THE ONE, der den Stadtteil Thon so anheizen wird, dass er förmlich verschmilzt.

Ob das gelingen kann?
Die Dimensionen sind enorm: 50 Meter soll das geplante Bürohochhaus THE ONE in den Himmel ragen. Die Kosten für das ambitionierte Bauprojekt mit rund 10.000 Quadratmetern Gewerbefläche liegen im mittleren zweistelligen Millionenbereich. Dabei ist der Zwölfgeschosser nur ein Teil auf dem 5,9 Hektar großen Entwicklungsareal Neue Mitte Thon, welches zukünftig als pulsierendes Zentrum des Stadtteiles fungiert. Neben Büroräumen werden hier Gastronomie, Nahversorgung, Einzelhandel, öffentliche Plätze und Dienstleistungen vereint. Den Auftakt als markante architektonische Landmarke macht jetzt THE ONE. Den Grundstein dafür legte die S & P Commercial Development GmbH, eine Beteiligung der Sontowski & Partner Group, im Frühjahr 2023. Die Fertigstellung ist Anfang 2025 anvisiert.
Kurz nach Baubeginn waren bereits über 65 Prozent der Fläche vermietet. Das erste bis fünfte Obergeschoss mit zusammen 5.400 Quadratmetern – und damit die Hälfte aller angebotenen Flächen – ist der arano group, einem Dienstleistungsunternehmen aus dem Gesundheitswesen,
einer Bauausführung im KfW 40-Standard ist zudem für eine „sehr gute“ Energieeffizienz gesorgt. Im Sinne der Kreislaufwirtschaft sollen gut trennbare und wiederverwertbare Materialien zum Einsatz kommen. Zudem wird ein Großteil der Pkw-Parkplätze in der Tiefgarage mit einer E-Lademöglichkeit versehen. S & P strebt für das Objekt die höchste Zertifizierungsstufe durch die Deutsche Gesellschaft für nachhaltiges Bauen (DGNB) an, eine Platin-Zertifizierung.
Steigende Büro-Nachfrage
Projekte wie THE ONE tragen der wachsenden Bedeutung des Nürnberger Büromarktes Rechnung. Laut den Analysten von JLL wurde 2022 in der Frankenmetropole ein Vermietungsumsatz von mehr als 118.000 Quadratmetern erreicht. Gegenüber dem Vorjahr stellt dies einen Anstieg um zwölf Prozent dar, gegenüber dem Zehn-Jahres-Durchschnitt liegt der Wert sogar um einen Drittel höher. Für 2023 erwartet JLL ein Umsatzvolumen von circa 100.000 Quadratmeter auf dem Büromarkt der zweitgrößten Stadt Bayerns.
Viviane Karel
IMMOBILIEN AKTUELL 36
PROJEKTE & VORHABEN
Zweifach einzigartig
Im Herzen Stuttgarts errichtet der Projektentwickler
DQuadrat in einer Kooperation mit WOLFF & MÜLLER die Mixed-Use-Immobilie

TWO.ONE. Das ambitionierte Projekt soll das Beste zweier Welten vereinen.
Hochklassiges Residenzviertel, verfallene Seitengasse, angesagte Erholungsmeile: Die Calwer Straße in der Stuttgarter Innenstadt hat in ihrer über 500 Jahre langen Geschichte so einige Bedeutungswandel durchlebt. Ursprünglich im 15. Jahrhundert als Wohngegend für die Oberschicht angelegt, wurde sie im Laufe der Zeit stark in Mitleidenschaft gezogen, zwischenzeitlich sollte sie gar dem Erdboden gleich gemacht werden. Aufwändige Sanierungsarbeiten und die Verbannung des Straßenverkehrs in den 1970er-Jahren haben den einstigen Problemfall mittlerweile jedoch zum ansehnlichen Kulturgässchen gemacht, in dem sich Restaurants, Ateliers und Boutiquen in jahrhundertealten Häusern diverser Stilepochen aneinanderreihen.
Zwischen Business und Wohnen
Biegt man von ihr zweimal ab, befindet man sich plötzlich in einer völlig anderen Welt. Die Theodor-Heuss-Straße, im Volksmund Theo genannt, ist eine der Hauptverkehrsadern Stuttgarts und vor allem als Flaniermeile und Businessstandort bekannt. Den Kontrast dieser beiden Welten wollen der Projektentwickler DQuadrat und das Bauunternehmen WOLFF & MÜLLER mit ihrem Projekt TWO.ONE vereinen. Dieses befindet sich am Standort Theodor-Heuss-Straße 21 im Bau, das Grundstück erstreckt sich rückläufig bis zur Calwer Straße. DQuadrat konzipierte die Mixed-Use-Immobilie mit einer flexibel nutzbaren Gesamtmietfläche von 6.000 Quadratmetern unter dem Motto: zweifach einzigartig.
Motto und Name spielen auf die erstklassige Lage an, ziehen sich jedoch auch abseits dessen wie ein roter Faden durch das Konzept des TWO.ONE. Dies wird nicht nur in der Mischung von Gewerbe- und Wohnflächen aufgegriffen, sondern zeigt sich auch architektonisch: Die Pläne sehen eine zweigeteilte Fassade vor, die das Flair beider Straßen
widerspiegeln soll. Im sechsgeschossigen Oberbau entstehen neben vier Wohnungen im Dachgeschoss überwiegend Büroflächen, das Erdgeschoss bleibt Einzelhandel und Gastronomie vorbehalten.
Dem angespannten Büromarkt zum Trotz
Insbesondere das Office-Angebot hat der Büromarkt im Stuttgarter Zentrum dringend nötig. Mit einer Angebotsreserve von lediglich etwa 25.000 Quadratmetern und Bestandsmieten von bis zu 33 Euro pro Quadratmeter ist die Situation angespannt wie in kaum einer anderen deutschen Großstadt.
Attraktive Offerten über 3.000 Quadratmeter waren im Jahr 2022 praktisch nicht vorhanden, während Großgesuche öffentlicher Stellen und eine nach Corona steigende Nachfrage das Problem weiter verschärfen, wie im Büromarktbericht der E&G Real Estate zu lesen ist. Zwar befinden sich derzeit eine Handvoll Projekte im Bau, die Fertigstellungstermine sind allerdings teils Jahre entfernt. Entwickler DQuadrat kommt die geringe Anzahl vergleichbarer Projekte und die einzigartige Lage des TWO. ONE hingegen zugute. Der Vermarkungsbeginn für die Büro- und Gewerbeflächen ist bereits erfolgt, erste Mietverträge wurden unterzeichnet und Gespräche mit mehreren Ankermietern laufen. Der Bau befindet sich derweil in vollem Gange. Ein Vorteil ist hierbei die Kooperation mit dem Schwesterunternehmen WOLFF & MÜLLER. Beide haben gemeinsam bereits mehrere Projekte finalisiert und arbeiten insbesondere bei der Kostenplanung eng zusammen. Die Beteiligten sind zuversichtlich, dass die zum Jahreswechsel 2024 / 2025 avisierte Eröffnung unter Einhaltung der ursprünglichen Kosten erfolgen wird. Schon 2025 sollen die ersten Mieter das TWO.ONE beziehen.
Robert Hoffmann
IMMOBILIEN AKTUELL 37 PROJEKTE & VORHABEN
LOVE plus LOFT gleich LOVT
Hines und Union Investment entwickeln den Münchner MediaWorks-Komplex zu einem gemischt genutzten Campus weiter. Im künftigen LOVT sollen sich Mieter, Nachbarn und Besucher begegnen.
Zeitenwenden gibt es nicht nur in der Politik. Auch für ein Industrieareal im Münchner Werksviertel bricht gerade eine neue Ära an. Wurden an dem Standort zunächst Munition und später Anzüge produziert, ließen sich dort in den 1990er-Jahren mehr als 100 Medienunternehmen nieder. Nun soll der weitgehend leerstehende MediaWorks-Komplex als gemischt genutztes Gebäudeensemble mit Büro-, Gastronomie-, Kultur- und Kreativflächen in sein drittes Leben starten.
Für die Revitalisierung sorgen Hines und Union Investment. Die Unternehmen hatten den Gebäudekomplex an der Rosenheimer Straße im Frühjahr 2021 gekauft. Die Gesamtinvestitionssumme wird mit mehr als einer Milliarde Euro angegeben, wovon rund 700 Millionen Euro auf den Erwerb entfielen.
Eingangstor zum Werksviertel
Den Startschuss zur Zeitenwende gaben die Investoren im Frühjahr 2023 mit der Umbenennung des MediaWorks in LOVT Munich. Der neue Name verbinde die Liebe zu
München (Love) mit der Vergangenheit des Standortes als Produktionsstätte (Loft), so die Idee dahinter.
Füllen wollen die neuen Hausherren die 96.000 Quadratmeter Geschossfläche des LOVTs mit einem Mix aus Workspaces, Werk- und Kreativräumen, Sportangeboten, kleinteiligem Gewerbe, Communityflächen, Hochgarten, Kulturbunker und Rooftop-Landschaft.
„Das LOVT wird zum südlichen Eingangstor des Werksviertels und verbindet das gesamte Stadtquartier mit der direkten Nachbarschaft und der Stadt“, kündigt Hines-Immobilien-Geschäftsführer Alexander Möll an. Hergestellt werden soll diese Verbindung durch die parkartig begrünten Höfe und die Dachterrasse, die als Orte der Begegnung nicht nur den Mietern, sondern auch Nachbarn und Besuchern zur Verfügung stehen.
Umfassende ESG-Strategie
Hines ist in München bereits für andere Großprojekte bekannt. Im Stadtteil Neuperlach verwandelte der Projektentwickler einen ehemaligen Allianz-Standort in das nachhaltige und innovative Büro- und Wohnquartier Aer. Zudem will Hines das in Teilen denkmalgeschützte Ensemble der Bürosiedlung Tucherpark im Stadtbezirk Schwabing-Freimann in ein zukunftsfähiges Quartier zum Leben, Arbeiten und Freizeitverbringen umgestalten.



Wie dem Aer und dem Tucherpark liegt auch dem LOVT ein umfassende ESG-Konzept zugrunde. Ein Großteil der Bestandsgebäude bleibt erhalten. Andere Teile werden nachhaltig erneuert, zwei Neubauten in Holzbauweise errichtet, Dächer und Höfe begrünt und ein CO₂-neutraler Betrieb mittels moderner Haustechnik angestrebt. Sogar 60.000 Bienen sollen hier ein neues Zuhause finden. Die Fertigstellung der verschiedenen LOVT-Bauabschnitte soll zwischen 2026 und 2029 erfolgen.
Frank Baecke
IMMOBILIEN AKTUELL 38
PROJEKTE & VORHABEN
Neue Meile
DIE WOHNKOMPANIE Nord baut aktuell eines der größten neuen Wohnquartiere im Herzen Lübecks. Wie es um das ambitionierte Projekt steht und wie eine abgebrannte Güterhalle das Baugeschehen beeinflusst hat.
Über ein Jahrhundert trotzte die alte Güterhalle im Lübecker Stadtteil St. Lorenz der harschen norddeutschen Witterung, bevor sich ihre Zeit dem Ende neigte. Ursprünglich 1905 erbaut, fiel die etwa 400 Meter lange Halle im Jahr 2021 einem Großbrand zum Opfer, welcher sich durch weite Teile der Holz konstruktion fraß. Der Tropfen, der das Fass zum Überlaufen brachte, war die hohe Belastung der Bausubstanz mit Pentachlorphenol. Diese äußerst giftige Chemikalie, welche früher als gängiger Bestandteil in Holzschutzmitteln verwendet wurde, beförderte in Kombination mit den Brandschäden eine geplante Sanierung der maroden Halle endgültig ins Aus.
Dennoch wird das historische Bauwerk Lübeck erhalten bleiben – wenn auch in anderer Form. Das Aalener Unternehmen i Live Group plant eine Rekonstruktion des Bauwerkes, welches sich in Materialität und Volumetrie am Original orientieren soll. Ziel des Unterfangens ist es, Flächen für ein Restaurant, einen Kindergarten sowie Büros zu schaffen, welche ursprünglich für die sanierte Halle vorgesehen waren.
Im Herzen Lübecks
Die Rekonstruktion der Halle ist dabei lediglich Teil eines größeren Projektes, welches aktuell auf dem ehemaligen Güterbahnhof in St. Lorenz realisiert wird. Unter dem Projektnamen Neue Meile revitalisiert DIE WOHNKOMPANIE Nord das rund 80.000 Quadratmeter große Bahnhofsareal, welches es 2017 von der Aurelis Real Estate erwarb. Das innenstadtnahe Gelände ist eine der größten brachliegenden Flächen in Lübeck und wird derzeit zum hochkarätigen Stadtquartier entwickelt. Neben der eingangs erwähnten

Güterhalle sehen die Planungen die Errichtung eines Hotels sowie zahlreicher Stadthäuser, Mietwohnungen und Microappartements vor. Insgesamt entstehen auf dem Areal künftig 339 Wohnungen auf mehreren Baufeldern, welche durch eine drei Hektar umfassende Parkanlage zu einem ansehnlichen Wohnviertel verbunden werden. Die historischen Gebäude wie der denkmalgeschützte Wasserturm wurden in das Konzept integriert und sollen dem Quartier einen besonderen Charme verleihen. Das nachhaltige Konzept der Neuen Meile stellt einen Grundpfeiler der Planung dar und wurde seitens der Deutschen Gesellschaft für Nachhaltiges Bauen mit dem Vorzertifikat für nachhaltige Stadtquartiere in Gold quittiert.
Volle Fahrt voraus
Neben der Nachhaltigkeit und dem integrativen Konzept sticht auch die Geschwindigkeit der Quartiersentwicklung besonders hervor. Vom Spatenstich der ersten beiden Baufelder im Herbst 2022 bis zur feierlichen Grundsteinlegung im Frühjahr 2023 vergingen gerade einmal sieben Monate, was in Anbetracht der Größe des Projektes ein beachtliches Tempo darstellt.
Die auf den ersten beiden Baufeldern errichteten Wohneinheiten konnten im Rahmen eines Forward Deals bereits schlüsselfertig an die künftige Eigentümerin, die Hamburg Team Investment Management GmbH, übergeben werden. Während die Abbrucharbeiten an der alten Güterhalle aktuell noch laufen, rechnet DIE WOHNKOMPANIE mit einer Fertigstellung des Wohnungsbaus im Frühjahr 2025. Die Gewerbeflächen sollen der aktuellen Aussicht nach im Herbst des gleichen Jahres folgen.
Robert Hoffmann
IMMOBILIEN AKTUELL 39
Gläsernes Stadttor
Der Tadao Ando Campus & Tower in Düsseldorf soll Hightech, Natur, Kunst und Vision symbiotisch verbinden. Herzstück des Projektes ist der 105 Meter hohe Hotel-, Gastronomie- und Büroturm mit einem freitragenden Glasprisma.
Es heißt, der japanische Stararchitekt Tadao Ando kröne sein Lebenswerk mit einem Architekturdenkmal für Düsseldorf. In der Tat hat der am Verkehrsknotenpunkt Mörsenbroicher Ei geplante Tadao Ando Campus & Tower in vielerlei Hinsicht das Zeug dazu, ein Lebenswerk zu bekrönen. Das beginnt schon bei der Architektur und setzt sich fort über den ungewöhnlichen Bauplatz, die KI-basierte Gebäudesteuerung und die CO2Neutralität des Projektes bis hin zu der Tatsache, dass Tadao Ando noch nie ein Hochhaus geplant hat. Dabei ist der 105 Meter aufragende Tower das Herzstück. Ein diagonal durch die oberen Etagen geschobenes, auf beiden Seiten auskragendes Glasprisma verleiht dem gläsernen Wolkenkratzer ein spektakuläres Aussehen. „Das Glasprisma wird sich in Richtung Stadtzentrum drehen, mit freiem Blick auf die Natur und das Stadtbild von Düsseldorf“, sagt Tadao Ando. Durch sein besonderes
Raumerlebnis sei das drei Etagen hohe Glasprisma sowohl ein Katalysator für Kreativität als auch ein Ort der Entspannung für Angestellte und Besucher.
„Architektur soll beruhigen“
Doch damit nicht genug. Der Tadao Ando Tower soll auch eines der ersten Hochhäuser in Europa sein, das mit künstlicher Intelligenz gesteuert wird und komplett CO2-neutral ist. Der Bau des 26 Etagen hohen Towers erfolgt in Holzhybrid-Bauweise und im Passivhausstandard. Die zu seinen Füßen liegenden, langgestreckten Neubau-Riegel entstehen aus Holz und erhalten intensiv begrünte Dächer mit Büschen, Bäumen, Gemüsegärten und Bienenvölkern. So entsteht fast jeder überbaute Quadratmeter Erdboden

IMMOBILIEN AKTUELL 40 PROJEKTE & VORHABEN
auf den Dächern und Terrassen neu. Tadao Ando will damit „zeigen, dass der Mensch in der Stadt mit der Natur leben kann. Mein Bau soll eine grüne Oase werden, in der die Menschen zur Ruhe kommen. Meine Architektur soll beruhigen.“
Neben Nachhaltigkeit und modernster Gebäude- und IT-Technik zeichnet sich das Projekt durch seine diversifizierte Nutzung aus. Die beiden Campus-Riegel mit ihren 60.000 Quadratmetern Fläche sind für Büros, Co-Working, Einzelhandel, Kunstgalerien, ein Museum, ein Ärztehaus sowie Schule und Kita vorgesehen. Im Tower entstehen auf 35.000 Quadratmetern ein Hotel, Restaurants, Veranstaltungsflächen und Büroarbeitswelten. Der vierte Baustein des Komplexes, ein rechteckiges Gebäude mit begrüntem Innenhof, bietet auf 12.000 Quadratmetern weitere Büro-, Konferenz- und Gastronomieflächen. Das internationale Ausnahmeprojekt wird eine wegweisende

Vision für künftige Arbeits-, Lebens- und Wohlfühlwelten sein, ist der Investor EuroAtlantic AG überzeugt. Neben modernster Technik tragen dazu die Kunst am und im Bau sowie die vom Schweizer Landschaftsarchitekten Enzo Enea geplanten horizontalen und vertikalen Grünflächen bei. Letztere sind mehr als nur Optik, verbessern sie doch wesentlich das Klima rund um das Mörsenbroicher Ei. Der über einen Hektar große Verkehrsplatz in Düsseldorf verknüpft drei Bundes- und drei Durchgangsstraßen und ist einer der meistbefahrenen und zugestauten Knotenpunke Deutschlands.
Mitten hinein setzen Tadao Ando und Enzo Enea nun ihre grüne Insel. Die Baugenehmigung für das schon jetzt als neues Stadttor im Norden Düsseldorfs bezeichnete Vorhaben wurde im Sommer 2022 erteilt. Die Fertigstellung ist für 2028 geplant.
Frank Baecke
IMMOBILIEN AKTUELL 41
Erneuern statt zerlegen
In Worms saniert der Entwickler Klassikprojekt derzeit den ehemaligen städtischen Schlachthof. Unter dem Motto Heimat für Geschmack soll aus dem denkmalgeschützten Objekt eine moderne Lifestyle-Immobilie werden, die dem geschichtsträchtigen Standort neues Leben einhaucht.
Am Ende des 19. Jahrhunderts standen die traditionsreichen Metzger Worms einem nie dagewesenen Platzproblem gegenüber. Das ursprünglich 1720 in Folge eines Stadtbrandes neuerrichtete Schlachthaus in der Wollstraße war im Laufe der Zeit trotz mehrmaliger Erweiterung zu klein geworden, um den Fleischereibetrieb adäquat zu beherbergen. Es herrschte Platznot.
Ein weiterer Ausbau war wegen hygienischer Bedenken aufgrund benachbarter Gerbereien als für nicht zweckhaft befunden worden, weswegen der damalige Oberbürgermeister Heinrich Köhler bei seinem Amtsantritt 1898 auf die Notwendigkeit eines Neubaus hinwies. Es folgte ein langwieriger Prozess, bis der südlich der Rheinbrücke gelegene Neubau nach Entwürfen von Stadtbaumeister Georg Metzler am 12. August 1912 schließlich feierlich eröffnet werden konnte.
Doch leider war dem Alten Schlachthof eine kürzere Lebensdauer beschert als seinem Vorgänger in der Wollstraße. In den 1970er Jahren verlor der Schlachtbetrieb aufgrund von steigenden Lieferungen aus dem Ausland zunehmend an Bedeutung und wurde eingestellt. Nach kurzzeitigen Zwischennutzungen als Markthalle und Insolvenzen der Betreibergesellschaften lag das historische Gelände seit der Jahrtausendwende brach.
Zweite Blüte für historischen Schlachthof
Nach dem langjährigen Leerstand nimmt sich nun der Düsseldorfer Entwickler Klassikprojekt der Sanierung des etwa 13.000 Quadratmeter umfassenden Geländes an. Unter dem
Namen MATADERO werden die historischen Jugendstilbauten erneuert und in eine Multi-Use-Gewerbeimmobilie für Gastronomie, Handwerk und Events verwandelt.


Getreu dem Motto des Projektes, Heimat für Geschmack, soll in den ehemaligen Industriebauten ein Ansiedlungsraum für Gaststätten und regionale Handwerksbetriebe entstehen, der den künftigen Besuchern eine Lifestyle-Location in besonderem Ambiente bietet. Neben dem Gewerbebereich sehen die Planungen zudem eine 420 Quadratmeter große Veranstaltungsfläche für bis zu 400 Personen, eine 140 Quadratmeter umfassende Kathedrale sowie drei Seminarräume vor, die die Angebotsvielfalt des MATADERO umfangreich ergänzen.
Das Angebot ist vor allem für Hochzeits- und Geburtstagsgesellschaften, Tagungen, Seminare, Ausstellungen sowie Galaabende ausgerichtet, aufgrund der Vielseitigkeit der Räumlichkeiten sind der Fantasie jedoch kaum Grenzen gesetzt.
Rückhalt aus Politik und Bevölkerung
Durch seine Größe sowie die vielfältige und soziale Ausrichtung stellt das MATADERO ein Leuchtturmprojekt für Worms dar und erhält dementsprechend einen starken Rückhalt aus der lokalen Gemeinschaft.
So wird die denkmalgerechte Sanierung durch die Deutsche Stiftung Denkmalschutz mit 58.000 Euro gefördert, während sich der Stadtentwicklungsdezernent der Stadt Worms, Timo Horst, bei den Landesbehörden für eine Beschleunigung des Baugenehmigungsverfahrens eingesetzt hat. Nach Angaben des Unternehmens sind die ersten Rohbauarbeiten bereits im Frühjahr dieses Jahres angelaufen. Einen offiziellen Fertigstellungstermin gibt es hingegen noch nicht.
Robert Hoffmann
IMMOBILIEN AKTUELL 42 PROJEKTE & VORHABEN
So viel Traum
Halle an der Saale hat den Zuschlag für das Zukunftszentrum des Bundes bekommen. Nun gilt es, die Stadt für diese Herausforderung bereit zu machen. Dafür werden auch Investoren gesucht.
auch das Image gleichermaßen. „Im Ergebnis des internationalen Architekturwettbewerbes, der dem Bau des Gebäudes vorausgeht, erhält die Stadt ein städtebauliches Highlight an exponierter Stelle –dem Riebeckplatz, der als Eingangstor der Stadt nahe des Bahnhofes an Attraktivität gewinnt“, sagt Egbert Geier.
Hotels im Fokus
Als Außenseiter gestartet und den Sieg geholt: In Halle (Saale) entsteht in den kommenden Jahren das Zukunftszentrum für Deutsche Einheit und Europäische Transformation, für das sich sechs Städte beworben hatten. „Der Zuschlag war Balsam auf der Seele. Halle war sehr oft in Wettbewerben Zweiter. Jetzt ist die Stadt deutschlandweit wieder auf dem Zettel“, sagt Mark Lange, Geschäftsführer der Stadtmarketing Halle (Saale) GmbH. Bürgermeister Egbert Geier wählt folgende Worte: „Die Standortentscheidung ist eine großartige, um nicht zu sagen: einmalige Nachricht für unsere Stadt, die Region und das Land Sachsen-Anhalt. Das Zukunftszentrum wird erhebliche und starke Impulse für die Weiterentwicklung der Stadt, der Region und des Landes setzen.“ Das Zentrum soll „als langfristiger Katalysator für die kooperative Aufarbeitung und Verarbeitung von individuellen und kollektiven Umbruchs- und Transformationserfahrungen in der Region, in Deutschland und Europa wirken“.
Die Baufertigstellung des Gebäudekomplexes ist für 2028 vorgesehen, das Bundesministerium für Wohnen, Stadtentwicklung und Bauwesen stellt 200 Millionen Euro Investitionskosten zur Verfügung, 200 Arbeitsplätze entstehen. Natürlich sprechen alle nun von der Strahlkraft, die diese Ansiedlung mit sich bringt. Für Bereiche wie Kunst & Kultur, Stadtentwicklung, Wirtschaft, Wissenschaft und
Mit dem neuen Projekt verbinden sich eine Menge Aufgaben für die Stadt. Für bereits geplante innerstädtische Wohnprojekte zeichne sich laut Pressestelle der Stadt ein sehr positives Bild durch die Standortentscheidung ab. „Eine vermehrte Nachfrage besonders bei Einzelgrundstücken und -objekten ist ebenfalls festzustellen“, heißt es. „Zudem nutzt die Stadt die Entscheidung für das Zukunftszentrum für die gezielte Ansprache von Eigentümern, deren Grundstücke einer städtebaulichen Entwicklung bedürfen.“ Doch es braucht noch mehr Investoren: „Bedarfe werden vor allem im Übernachtungsgewerbe, aber auch in den Bereichen Gastronomie und Einzelhandel entstehen. Hier hat die Stadt auf jeden Fall Nachholbedarf.“ Genaue Zahlen und Details gibt es dazu (noch) nicht.

Klar ist: Das Zukunftszentrum ist ein Booster. In jedem dritten Satz der Veröffentlichungen ist von einem großen oder enormen Schub zu lesen. „Wir haben als Unternehmen von Anfang an auf Halle gesetzt. Auch wenn damals die Bevölkerungsprognosen nur bergab zeigten", sagt Heiko Schaar, Geschäftsführer bei dem Projektentwickler ISIHOME Group, und verweist damit auf die Bedeutung der Stadt innerhalb der Region. Natürlich schauen nun alle auf das Dauerprojekt Riebeckplatz, der seit Jahren ein Hauptpunkt der Stadtentwicklung ist und nun in einem so genannten PLANWERKdialog mit Integration aller Stakeholder – auch der Stadtgesellschaft – vorangetrieben wird. Die Stadt Halle passte die Planungen an und diskutierte dazu mit der Bundesregierung. „Den Vorschlag für den Umbau begrüße ich ausdrücklich und unterstütze, dass die Stadt den Bau des Zukunftszentrums für die Neugestaltung des extrem verkehrsdominierten Ortes nutzen will“, so Staatsminister Carsten Schneider, Ostbeauftragter der Bundesregierung. „Wichtig ist, dass der Umbau des Riebeckplatzes den Zeitplan für den Bau des Zukunftszentrums nicht verzögert.“
Ivette Wagner
IMMOBILIEN AKTUELL 43 PROJEKTE & VORHABEN
Kölns neuer Süden
Die Parkstadt Süd in Köln zählt zu den größten Stadtentwicklungsprojekten Deutschlands. Auf 115 Hektar sollen neue Wohn- und Arbeitsquartiere entstehen sowie ein 100 Jahre altes Vorhaben von Konrad Adenauer vollendet werden.
London hat einen, München und Wien haben auch einen. Ebenso Frankfurt am Main, Kiel, Mainz und Köln. Allerdings, der in Köln ist nicht komplett. Die Rede ist von einem Grüngürtel. Das durchgängige System aus Grün- und Freiflächen, das viele Städte seit dem Niederreißen ihrer Festungsanlagen umgibt, verläuft in Köln vom Stadtteil Riehl im Norden halbkreisförmig um die Altstadt herum. Jedoch endet der Innere Grüngürtel, wie er korrekt heißt, im Süden nicht am Rhein, sondern schon im Südwesten an der Luxemburger Straße. Dahinter versperrte Bebauung dem grünen Band den Weg zum Strand. Doch das soll sich nun ändern.
Ein neuer Stadtteil auf 115 Hektar
Die Weiterführung des Inneren Grüngürtels bis zum Rhein ist beschlossene Sache. Damit einher geht eines der größten innerstädtischen Stadtentwicklungsprojekte Deutschlands: die Parkstadt Süd. Auf einem 115 Hektar großen Plangebiet zwischen Köln-Raderberg und Köln-Bayenthal sollen 3.400 Wohnungen für 7.700 Einwohner sowie 4.300 Arbeitsplätze in modernen Büros und Gewerbeeinheiten entstehen, dazu Schulen, Kitas, Spielplätze und Sportflächen.
Der Clou an der Parkstadt Süd ist die Verlängerung des Grüngürtels von der Luxemburger Straße bis zur Südbrücke am Rhein. Durch Abriss und Entsiegelung entsteht eine 26 Hektar große Grünanlage, die sich im Wesentlichen über die Areale des ehemaligen Güterbahnhofes Bonntor, der früheren Dombrauerei und der Großmarkthalle erstreckt. Außerdem hat der Lückenschluss historische Bedeutung. Mit
ihm wird der nach dem Ersten Weltkrieg vom damaligen Kölner Oberbürgermeister Konrad Adenauer veranlasste Umbau des Inneren Festungsringes in einen zusammenhängenden Grüngürtel nach rund 100 Jahren vollendet.
Markthalle wird Quartiers-Mittelpunkt
Eine besondere Rolle in der neuen Parkstadt Süd ist der Großmarkthalle zugedacht. Sie könnte nach dem Umzug der Händler Ende 2025 nach Köln-Marsdorf für alle Bürger geöffnet werden und nach dem Vorbild der Markthallen in Budapest oder Lissabon diverse Lebensmittelhändler, Restaurants und Cafés beherbergen. Am konkreten Nutzungskonzept wird noch gearbeitet. In jedem Fall aber soll die denkmalgeschützte Großmarkthalle als Ort der Begegnung zum lebendigen Mittelpunkt der neuen Parkstadt Süd werden.
Um dieses Herzstück herum entstehen drei nutzungsgemischte Quartiere: das Quartier Marktstadt mit öffentlichen, kulturellen und sozialen und Versorgungsnutzungen, das Quartier Parkstadt mit unterschiedlichen Wohnraumangeboten sowie das Quartier Bildungslandschaft mit Schulen, bildungsbezogenen Einrichtungen und Wohnnutzung. Außerdem sollen Sportflächen und Spielplätze entstehen.
Die Erdarbeiten für den Bau der ersten Häuser starteten im Sommer 2022 an der Sechtemer Straße in KölnRaderberg. Dieser erste Abschnitt der Parkstadt Süd mit 210 Wohnungen soll Ende 2025 bezugsfertig sein. Mit der Gesamtfertigstellung des neuen Stadtteiles rechnet die Stadt Köln im Jahr 2037. Frank Baecke

IMMOBILIEN AKTUELL 44 PROJEKTE & VORHABEN
Lichtspieleffekt
Vis-à-vis der Hamburger Elbphilharmonie entsteht der neue Luxuswohntower
The Lyte. Mit der höchsten Gemeinschaftsdachterrasse der HafenCity und seiner je nach Tageszeit weißen oder goldenen Fassade ist er buchstäblich ein High-Light.
Der großen Worte liest man viele, wenn es um das 60 Meter hohe Wohngebäude The Lyte geht. Von einer neuen Ikone für die Hamburger HafenCity ist die Rede, von stilvollen Wohnungen und einer Welt voller Möglichkeiten, von einem ganz neuen Lebensgefühl.
Nach der Idee des Projektentwicklers DC Developments soll ein „ausgleichender und gleichwohl eleganter Ort des Rückzuges“ entstehen. Was das bedeutet, erläutert Lothar Schubert, geschäftsführender Gesellschafter von DC Developments: „Die HafenCity ist ein Ort, an dem Leben und Metropolenflair zu spüren sind. Mit Betreten des Gebäudes herrscht schlagartig Ruhe und zurückhaltender Luxus. Jede Wohnung ist wie ein Schmuckkästchen, das stilvolle Elemente birgt.“

86 Schmuckkästchen gibt es im The Lyte. Sie sollen Mitte 2024 bezugsfertig sein. Die Interieurs seien zentimetergenau geplant, die Einbaumöbel für jede Wohnung maßgeschneidert entworfen worden, berichtet Randi Mara Schumacher, Geschäftsführerin von PASCH Design. „Im Ergebnis konnten wir Grundrisse sowie Inneneinrichtungen schaffen, die eine effiziente und platzsparende Nutzung garantieren.“ Käufer haben die Wahl zwischen 27 Wohnungstypen mit ein bis fünf Zimmern beziehungsweise mit 43 bis 395 Quadratmetern.
Die Wohnungen (ab 11.200 Euro pro Quadratmeter) erstrecken sich von der vierten bis zur 16. Etage. In den unteren drei Etagen zieht das Kaufhaus Breuninger ein. Bekrönt wird das Gebäude von zwei Penthäusern mit 285 und 395 Quadratmetern Wohnfläche, die sich über zwei Stockwerke erstrecken und je eine eigene Dachterrasse haben.
All das macht The Lyte aber noch nicht einzigartig. Hierfür sorgen zwei weitere Besonderheiten. Zum einen entsteht in 60 Metern Höhe die höchste private Dachterrasse
der HafenCity inklusive Outdoorküche, Loungemöbeln und mediterraner Bepflanzung. Sie steht allen Hausbewohnern zur gemeinschaftlichen Nutzung zur Verfügung. Björn Dahler, geschäftsführender Gesellschafter von DC Developments, spricht von einem „Sharingbereich unter freiem Himmel“ mit einem „atemberaubenden Blick über die Stadt, den Hafen und die Elbphilharmonie“.
Zum anderen verleihen hunderte Licht- und Sonnenschutz-Schiebeelemente der Fassade ein faszinierendes Aussehen. „The Lyte hebt sich vom Häusermeer der HafenCity neben seiner filigranen Form insbesondere durch sein attraktives Lichtspiel ab. Tagsüber in strahlend weißer Erscheinung, schimmert es in der Abendsonne in einem warmen Goldton“, sagt Architekt Franz-Josef Nähring, Geschäftsführer bei kbnk Architekten.
Die 157 Hektar große HafenCity ist Europas größtes innerstädtische Stadtentwicklungsvorhaben. The Lyte entsteht im Überseequartier, das als zentrales Quartier der HafenCity konzipiert ist. Der Wohnturm soll im zweiten Quartal 2024 fertiggestellt werden. Das Gesamtinvestitionsvolumen beläuft sich auf etwa 100 Millionen Euro.
 Frank Baecke
Frank Baecke
IMMOBILIEN AKTUELL 45
Biophiles Design
Nicht weniger als eine neue Ära bei Bürogebäuden soll das ATREEUM im Frankfurter Ostend einläuten. IMMOBILIEN AKTUELL zeigt, mit welchen Innovationen die Projektentwickler dieses Ziel erreichen wollen.

Verändert ein Ereignis oder eine Erfindung die Lebensumstände vieler Menschen, spricht man vom Beginn einer neuen Ära. Luthers Thesenanschlag war so eine Zäsur oder die Erfindung der Glühlampe. Aber kann auch ein innovatives Bürogebäude eine Zeitenwende bewirken? Nichts Geringeres hat sich die OFB Projektentwicklung GmbH mit dem ATREEUM vorgenommen. Der zukunftsweisende Bau entsteht im Frankfurter Ostend an der Hanauer Landstraße 211 und soll im zweiten Quartal 2024 fertiggestellt werden.
Schon zum Projektstart im März 2021 legte der damalige Vorsitzende der Geschäftsführung, Klaus Kirchberger, die Latte hoch: „Zahlreiche Untersuchungen legen nahe, dass eine gesunde Arbeitsumgebung die Mitarbeiter unter anderem zufriedener und weniger krankheitsanfällig macht. Beim ATREEUM setzen wir genau hier an und schaffen eine Arbeitswelt mit hoher Aufenthaltsqualität, welche die Bedürfnisse des Menschen in den Fokus rückt.“ Bei der Erschaffung dieser Arbeitswelt folgt OFB den Prinzipien des biophilen Designs.
Inspiriert von der Natur
Biophilie ist die Liebe zu allem Lebendigen. Übersetzt in Architektur heißt das: eine Designsprache, die von natürlichen Strukturen inspiriert ist, begrünte Dachgärten, die zum Arbeiten im Freien einladen, Balkone, die auf üppig bepflanzte Innenhöfe blicken, und natürliche Materialien für ein gesundes Arbeitsumfeld. Die Pflanzen sollen sich in enger Symbiose mit den Gebäudestrukturen zu einer entschleunigten grünen Oase entwickeln, in der die

Menschen wieder in Einklang mit einer natürlichen Umgebung kommen.
Dieser Gedanke setzt sich konsequent im Nachhaltigkeitskonzept des Gebäudes fort. Alle Pflanzen werden mit Regenwasser aus Retentionsboxen bewässert, Wärmepumpen stellen die Energie zum Heizen und Kühlen bereit, Photovoltaikanlagen liefern hierfür den Grundstrom, und Plattenwärmetauscher beugen Wärmeverlusten vor. Überdies ermöglichen Heiz- und Kühlleitungen in den Decken eine Betonkerntemperierung der Büros, die zusätzlich über raumweise steuerbare Heiz- und Kühldeckensegel verfügen. Neben der innovativen Haustechnik und der gesunden Umgebung besticht das ATREEUM mit wandelbaren Raumstrukturen, die sich für Meetings, Projektarbeit und konzentriertes Arbeiten, aber auch als offene Kommunikationsflächen oder stille Rückzugszonen anordnen lassen.
Neue Gebäudegeneration
Das DGNB-Gold-zertifizierte Büroensemble entsteht auf einem 5.000 Quadratmeter großen Grundstück zwischen EZB und Ostbahnhof. Es umfasst sieben ober- und zwei unterirdische Etagen mit rund 17.900 Quadratmetern Mietfläche. In der Tiefgarage gibt es 219 Stellplätze, die größtenteils mit E-Ladeanschlüssen versehen sind, sowie Fahrradräume. Die OFB-Entwickler betonen, dass sie mit ihrem Gebäudekonzept hinsichtlich Nachhaltigkeit, Umweltbewusstsein und Regenerationsfähigkeit den „Samen für eine neue Generation von Bürogebäuden“ gelegt haben. Das mag stimmen. Ob damit auch eine neue Ära beginnt, wird sich zeigen.
Frank Baecke
IMMOBILIEN AKTUELL 46 PROJEKTE & VORHABEN
ADVERTORIAL
Wärme ist nicht gleich Wärme.
Die Wärmewende wirkt sich direkt auf den Gebäudesektor aus: Dezentrale, individuelle Wärmelösungen sind ein Ansatz zur klimaschonenden Versorgung von Gebäuden.
Um die Klimaneutralität bis 2045 zu erreichen, muss die Wärmewende direkt und kurzfristig angegangen werden, macht Wärme doch den Großteil des deutschen Energieverbrauches aus. Die Wärmewende wird so zum Erfolgsfaktor der Klimaneutralität – und individuelle Wärmelösungen bieten einen gleichzeitig nachhaltigen wie maßgeschneiderten Ansatz zur Energieversorgung von Gebäuden und Quartieren.
Wärmewende als Schlüssel zum Erfolg
Zum Erreichen der Klimaschutzziele muss auch der Gebäudesektor seinen Beitrag leisten: Hauptfaktor mit hohem CO₂-Einsparpotenzial sind die mit fossilen Brennstoffen erzeugte Raumwärme und das Warmwasser. Um hier die Dekarbonisierung voranzutreiben, muss der Gebäudesektor den Anteil der erneuerbaren Energien erhöhen, Abwärmepotenziale abschöpfen und eine Umstellung auf nicht-fossile Brennstoffe erreichen. So kann die Wärmewende gelingen.
Carolin Süß, Geschäftsführerin & Head of Business Solutions Germany bei Vattenfall Energy Solutions GmbH
„Mit unseren individuellen Wärmelösungen heben wir Potenziale vor Ort und stellen somit eine maßgeschneiderte und klimaschonende Versorgungslösung ganz nach Kundenwunsch sicher.“
Individuelle Versorgungslösungen sind gefragt
Hamburg ist nicht Berlin und Tempelhof ist nicht Neukölln –je nach Region, Stadt, Quartier oder gar Objekt ist mit der Umstellung der Wärmeversorgung auch ein Umstieg auf unterschiedliche und manchmal mehrere Wärmequellen verbunden. Für jedes Gebäude sieht das beste Energiekonzept daher anders aus. Individuelle Wärmelösungen sind gefragt: Handelt es sich um einen Neubau oder eine
Bestandsimmobilie? Können Wärmepumpen integriert werden? Wie lassen sich Design und Energieversorgung kombinieren?
Alternative Wärmequellen mit Nachhaltigkeitsfaktor
Ganz weit vorn als klimaschonende Bausteine rangieren Wärmepumpen und dezentrale Versorgungsnetze. Wärmepumpen gewinnen Energie aus der Umwelt und wandeln diese in klimaschonende Wärme um. Mit Ökostrom zahlt dies perfekt auf die Wärmewende ein.
Individuelle Energielösungen für Ihre Immobilie
Die Vattenfall Wärme als starker Partner mit einem breiten Anlagenportfolio bietet Ihnen ein individuelles, maßgeschneidertes Versorgungskonzept, das perfekt zu Ihrem Projekt passt. Profitieren Sie von einem ganzheitlichen und individuellen Energiekonzept aus einer Hand und das vollkommen risikolos, da die Investitionskosten von Vattenfall übernommen werden. Entdecken Sie jetzt Ihre individuelle Wärmelösung. Und das bequem, komfortabel, unkompliziert, umweltschonend und effizient. Ob in Hamburg oder Berlin – Vattenfall ist Ihr Partner für klimaschonende Versorgungslösungen.
Mehr zum Thema dezentrale Wärmelösungen finden Sie hier: waerme.vattenfall.de/waerme/waermecontracting
IMMOBILIEN AKTUELL 47
Benjamin Blocher, Partner für Architektur und Stadtplanung bei blocher partners, über gemischte Konzepte, neues Leben in alten Kaufhäusern und die Nutzung von Erdgeschossen.

IMMOBILIEN AKTUELL 48 SCHWERPUNKT: BESTANDSENTWICKLUNG
„Urbane Gebiete sehen wir sehr positiv“
IMMOBILIEN AKTUELL (IA): Mischnutzungen von Innenstadtquartieren stehen zurzeit hoch im Kurs. Gerade Ihr Projekt in Mannheim zeigt die homogene Verbindung verschiedenster Lebensbereiche in einem Gebäudekomplex. In welchen Kombinationen sehen Sie am ehesten die Zukunft des stationären Handels?
Benjamin Blocher (BB): Gemischte Konzepte tragen wesentlich zur Belebung der Innenstadt bei. Abseits der Bedarfskäufe sind die Menschen anspruchsvoll geworden und suchen nicht nur das Erlebnis, sondern möchten am Puls der Zeit sein. Dazu müssen auch die Städte beitragen. Der Handel kann nicht ohne Stadt – die Stadt kann nicht ohne Handel. Ein wichtiger Punkt für uns als Planer ist die Attraktivität der Erdgeschosse, die den Kunden einen leichten Einstieg gewähren. Darüber hinaus ist Flexibilität gefragt, um die Flächen kuratieren und leicht umgestalten zu können. Die klassischen Sortimente sollten sinnvoll ergänzt werden. Das kann alles sein – von speziellen Service-Angeboten, LifestyleProdukten bis zu regionalen Lebensmitteln. Eine andere Möglichkeit ist die Kombination mit gastronomischen Angeboten. Die Frequenz wird erhöht, die Verweildauer verlängert und idealerweise werden weitere Zielgruppen angesprochen. Klar ist aber: Das Gastronomiekonzept muss wie alle anderen Aspekte auch auf die Authentizität, die jeweilige DNA, einzahlen.
IA: Sie sprachen das Erdgeschoss an. Welche Konzepte ergeben sich für die Untergeschosse in den Gebäuden? Sind hier reine Technikeinheiten oder Tiefgaragen vorgesehen? Würden beispielsweise Fitnessstudios ohne Tageslicht von Kunden angenommen?
BB: Denkbar ist viel, beispielsweise ein Food Market, ein Supermarkt oder auch Ausstellungsflächen
für Kunst, Freizeitangebote wie eine Bowling-Bahn. Voraussetzungen wie Entrauchungs- oder Klimatisierungskonzepte müssen dann natürlich entsprechend der Nutzung geschaffen werden. Auch ein Fitnessstudio ohne Tageslicht ist theoretisch denkbar, wenn es gestalterisch auf die spezielle Situation einzahlt, durch smarte technische Lösungen wie Human Centric Lightning. Grundsätzlich aber ist davon auszugehen, dass die Menschen ein Studio mit Tageslicht bevorzugen.
IA: Sind auch pädagogische Einrichtungen wie Kitas oder Schulen in Ihren Projekten vorgesehen? Der Bedarf dürfte ja gerade in den Innenstädten groß sein. Wenn ja: Müssten diese im Erdgeschoss liegen?
BB: Nein, es geht immer um die Frage der Erreichbarkeit plus Anknüpfung an die Außenräume. Wir haben beispielsweise bei einem gemischtgenutzten Projekt in der Stuttgarter Innenstadt eine Kindertagesstätte im ersten Obergeschoss integriert. Allerdings ist die Freifläche auf dieser Ebene. Insofern ist der Ein- und Ausgang das eine, die zweite Frage ist, wie der Außenbereich gestaltet und sinnvoll angeschlossen werden kann.
IA: Mischnutzungen haben Sie als Schlüssel für moderne Stadtentwicklung aufgezeigt. Sie sind auch eine Frage des Planungsrechtes. Welche Erfahrungen machen Sie mit der Ausweisung urbaner Gebiete und auf welche Probleme stoßen Sie hier regelmäßig?
BB: Wir sehen das sehr positiv, denn die Ausweisung urbaner Gebiete bietet mehr Flexibilität und ermöglicht, ortsspezifischer und individueller zu reagieren. Die bauliche Verdichtung steigt, da die Gebietskategorie bei gleicher Flächengröße mehr
Wohneinheiten erlaubt als das traditionelle Mischgebiet. Gerade auch weil der überbaubare Anteil eines Grundstückes und die zulässige Geschossfläche deutlich höher ist als beim Mischgebiet, muss sehr auf die Sicherung der städtebaulichen architektonischen Qualität geachtet werden.
IA: Sehen Sie Mischnutzungskonzepte in den Nutzungsarten, die von völlig illusorischen Prämissen ausgehen?
Konkreter: Welche Mischung verträgt sich nicht?
BB: Quartiere sind dann nachhaltig, wenn sich Menschen 24 / 7 dort aufhalten wollen. Das bedeutet: In und um mischgenutzten Gebäuden ist immer etwas los; Waren werden ein- und ausgeladen, Kinder schreien, Personen essen und trinken in der Gastronomie, Musik wird gespielt. Bewohner, die viel Wert auf Ruhe legen, könnten daher Mühe haben, in einem Multifunktionsgebäude zu wohnen. Unterschiedliche Mieter oder Nutzer haben verschiedene Anforderungen an dieselbe Immobilie –auch baulich. Beispielsweise haben Restaurants, Kitas und Büros differenzierte bauliche Anforderungen wie Raumhöhe, Belüftung und Abfallentsorgung. Es gibt aber auch Mischungen, die von vorneherein zum Scheitern verurteilt sind, weil sie durch bauliche Verordnungen gar nicht erst realisiert werden können. So zum Beispiel das Stuttgarter Hafengebiet: Die Bestimmungen der Bundesimmissionsschutzverordnung verbieten wegen der Lautstärke den Bau neuer Wohnungen in industriell genutzten Gebieten. Selbst Verkehrskonzepte spielen eine Rolle, da sie über die Festlegung von Form und Qualität der Erschließung innerstädtischer Räume direkten Einfluss auf die Schaffung von Mischung haben oder – im schlechten Fall – Entmischung zusätzlich verstärken können.
Interview: Dr. Ulrich Nagel
IMMOBILIEN AKTUELL 49 SCHWERPUNKT: BESTANDSENTWICKLUNG
The Q
In Nürnberg wird dem legendären Quelle-Areal Leben eingehaucht: Auf 170.000 Quadratmetern entsteht ein gemischt genutztes Quartier – nicht ohne Überraschungen.

Rund 14 Jahre war sie eine der größten leerstehenden Immobilien der Republik: Seit der Insolvenz von Quelle, einst größter Versandhändler Europas, darbte das von Ernst Neufert konzipierte Logistik- und Versandzentrum im Spannungsfeld zwischen Investoren und Politik dahin. Nun rollen die Bagger unter Federführung des Projektentwicklers GERCHGROUP und des Generalplaners kister scheithauer gross (ksg). Bis 2026 soll The Q ein urbanes Areal mit unterschiedlichen Nutzungsformen bieten.
„Der Quelle-Konzern, das deutsche ‚Amazon der Nachkriegszeit‘, hat mit dem Nürnberger Logistik- und Versandzentrum eines der bedeutendsten Baudenkmäler der deutschen Nachkriegsgeschichte geschaffen“, ist Professor Johannes Kister überzeugt. Der geschäftsführende Gesellschafter des Architekturbüros ksg ist verantwortlicher Planer für die Revitalisierung des zwischen 1953 und 1969 entstandenen Baukomplexes in wenigen Kilometern Entfernung zur Nürnberger Altstadt. Die Ursprünge des auf fünf Baukörpern entstehenden Gewerbebaus spiegeln die visionäre Idee des Quelle-Gründers Gustav Schickedanz wider: Erstmalig in der deutschen Wirtschaftsgeschichte kam ein IT-gestütztes System für den Transport und die Kategorisierung von Waren zum Einsatz. Um auch von
außen dieses technologische Novum erleben zu können, wurde ein fassadenweites Fensterband auf 1,50 Meter Höhe angebracht – sichtbar waren also die gleichsam freischwebenden Pakete, nicht die dort beschäftigten Angestellten. Die darüber angebrachten Brüstungen mit einem Band aus gelbem Ziegelstein verstärken den Eindruck der Transportdynamik. So war der Quelle-Bau am Anfang ganz auf das Produkt konzentriert. Fassade, Treppenhäuser und der große Konferenzsaal stehen heute unter Denkmalschutz.
Durch den Wegfall des Produktes im Zuge der Quelle-Insolvenz 2009 stellte sich die Frage nach einer Nachnutzung des Areals, die sich nun am Menschen orientieren sollte. Mehrere Eigentümerwechsel und politische Differenzen zwischen Kommunal- und Landesregierung hüllten den Neufert-Bau jedoch zunächst in einen Dornröschenschlaf. „Es ist dem Nürnberger Oberbürgermeister Dr. Ulrich Maly zu verdanken, dass eine Zerschlagung der Baukörper ebenso wenig infrage kam wie ein vollständiger Abriss“, kommentiert Johannes Kister. 2018 übernahm die Düsseldorfer GERCHGROUP das Projekt – als mittlerweile dritter Investor. Mit dem Ankermieter, der Stadt Nürnberg und ihrem Projekt eines neuen Behördenzentrums auf 42.000 Quadratmeter Fläche, war ein erster Meilenstein im

IMMOBILIEN AKTUELL 50 SCHWERPUNKT: BESTANDSENTWICKLUNG
700 Millionen Euro schweren Investment erreicht. Seitdem ist die Planung eines Mischquartiers mit Büro, Wohnungen, Einzelhandel und Gastronomie auf dem Tisch. Damit rückt die ksg-Ursprungsplanung wieder in den Fokus: „Bei einer Gesamtgröße von ursprünglich 250.000 Quadratmetern Nutzfläche haben wir ja bereits ein Ensemble im Quartiersformat. Flexible Grundrisse gerade bei den Wohnnutzungen lassen mehrere Optionen von Mietwohnungen, Hotels, Seniorenwohnen bis hin zu Studentenapartments zu“, so Johannes Kister.
Herausforderungen im Bestand
Die enorme Deckenhöhe in den Versandhallen war eines der ausschlaggebenden Kriterien für die mögliche Nutzungskonversion des Areals. Wie bei den meisten Bauten bis in die 1990er Jahre gab es jedoch für die neue Nutzung zu wenig Licht. In enger Abstimmung mit dem Denkmalamt wurde ein Einschnitt in die Innenstruktur der Baukörper beschlossen, durch den großzügige Lichthöfe entstehen werden. Die Einschnitte führen auch zu einer Verringerung der Nutzfläche auf rund 170.000 Quadratmeter. Da die Fassade nicht

dämmbar ist, kommt eine Innendämmung zum Einsatz, die in die jeweiligen Raumdecken integriert ist. Johannes Kister betont, dass die Schwierigkeiten im Projekt nicht aus der Entstehungsphase des Baus kommen: „Die meisten Abweichungen sind durch nicht-dokumentierte Umbauten entstanden. Bei Umbauten dieses Volumens und jahrzehntelanger Baugeschichte kommt man um Überraschungen wie abgehängten Geschossdecken oder plötzlich auftretenden Stahlträgern nicht herum.“
Weitere Komplikationen ergeben sich durch neue regulatorische Anforderungen. Die in den 1950ern noch existente Norm Sparsames Bauen führte beispielsweise dazu, dass zwischen den Stahlkonstruktionen gerade einmal acht Zentimeter breite Betonplatten eingesetzt wurden. „Heute wäre eine solche Norm bei den Anforderungen an Schallschutz, Belichtung und Abständen nicht mehr denkbar. Wir brauchen daher bei Umbauten im Bestand eine höhere Flexibilität der Bauordnungen, um der Versuchung eines Abrisses zu entgehen“, sagt Johannes Kister. Durch die Revitalisierung ergibt sich nämlich ein positiver Klimaeffekt: Die CO₂-Emissionen im Projekt The Q wären beim Abriss und Neubau um 160 Prozent höher ausgefallen.
Dr. Ulrich Nagel
IMMOBILIEN AKTUELL 51
Aufgestockt
Studentenapartments über Parkhäusern oder ein Fitnessstudio auf dem Dach eines Supermarktes – neuer Wohnraum auf alten Flächen ist voll im Trend. Lässt sich damit die Wohnungsnot lindern?


Wohnraum in Deutschlands Städten ist knapp –äußerst knapp. Auf Grund verschiedener Faktoren wie Zuwanderung, veränderter Wohnmuster (mehr Single-Haushalte) und seit Jahren zu geringer Bauaktivitäten fehlen nach Schätzungen einer Studie des ARGE-Institutes (Kiel) und des Pestel-Institutes (Hannover) in diesem Jahr 700.000 Wohnungen in Deutschland. Es müssen also tragfähige Lösungsvorschläge her. Nachverdichtung ist daher ein Gebot der Stunde. Hierunter versteht man die Schaffung neuen Wohn- / Nutzraumes auf bereits bebauten Flächen. Das kann etwa durch Konversion einer alten Fabrikanlage geschehen oder durch Aufstockung auf
bereits vorhandenen Immobilien. Insbesondere die Nachverdichtung durch Aufstockung hat ihren Reiz.
Viel Potenzial
Das Potenzial dieser Innenentwicklung ist enorm. Laut einer Studie der TU Darmstadt aus dem Jahr 2019 könnten 1,1 bis 1,5 Millionen Wohneinheiten auf Wohngebäuden der 1950er bis 1990er Jahre aufgestockt werden. Weitere 560.000 Wohnungen könnten geschaffen werden, indem man auf Dachgeschosse von Bürogebäuden baut. Wenn
IMMOBILIEN AKTUELL 52 SCHWERPUNKT: BESTANDSENTWICKLUNG
man eingeschossige Flachdach-Supermärkte aufstocken würde, ließen sich zusätzliche 400.000 Wohneinheiten gewinnen. Allein in Berlin identifizierten die Wissenschaftler 330 (inner-)städtische Lebensmittel- oder Drogerieläden, die sich grundsätzlich für eine Aufstockung eignen würden. 20.000 bis 36.000 Wohnungen könnten hier errichtet werden. Kommunal vorgeschriebene Traufhöhen und Geschossflächenzahlen sind dabei berücksichtigt.
Auch Parkhäuser bieten Potenzial, da sie sich in der Regel in begehrten zentralen Lagen befinden. Einige Konversionsprojekte wie am Berliner Gleisdreieck sind bereits realisiert worden. Im Zusammenspiel mit dem sinkenden Autobedarf in urbanen Lagen ergibt sich ein bundesweites Gesamtpotenzial von rund 20.000 Wohnungen.
Praxisbeispiele
Ein nennenswertes Beispiel ist das innerstädtische Parkhaus in der Hannoveraner Windmühlenstraße. Durch das Architekturbüro Cityförster im Auftrag der hanova Gesellschaft für Bauen und Wohnen wurde das Parkhaus zunächst saniert und dann durch eine Wohnkrone aufgestockt. Auf

dem obersten Stockwerk mit separaten Aufzügen entstanden zwölf Penthouse-Wohnungen mit herrlichem Blick über die Stadt und eigenem, begrünten Innenhof. Auch in der Kölner Magnusstraße wurde ein Parkhaus einer neuen Nutzungsform zugefü hrt, indem Teile des alten, nicht ausgelasteten Gebäudes Umbau und Aufstockung erfuhren. Ergebnis: 31 Wohnungen entstanden und noch immer 250 Parkplätze.
Vorteile
Hervorzuheben ist zunächst ein Vorteil: weniger Bauen auf der grünen Wiese. Noch heute werden durchschnittlich 60 Hektar am Tag zu Siedlungs- und Verkehrsfläche umgewandelt. Geht es nach der Bundesregierung erfolgt bis 2030 eine Reduzierung auf 30 Hektar pro Tag. Nachverdichtung durch Aufstockung könnte zu dieser Zielerreichung einen Beitrag leisten. Aus ökonomischer Sicht bietet Aufstockung ebenfalls manchen Vorzug. Anstelle eines Neubaus w ü rden aufgestockte Wohneinheiten auf bereits erschlossene Infrastruktur zugreifen können. Vom Abwasserrohr bis zur ÖPNV-Verbindung: Alles wäre bereits vorhanden, könnte effizienter genutzt und müsste nicht neu errichtet werden.
Die andere Seite der Medaille
Mehr Wohneinheiten pro Viertel führen naturgemäß zu weniger Parkplätzen für die steigende Anzahl an Anwohnern. Auch der öffentliche Nahverkehr benötigt in manchen Städten einen massiven Ausbau. Ferner wird vielerorts eine Nachverdichtung von den Anwohnern abgelehnt: Versperrte Blicke, monatelange Verkehrsbehinderungen und Baulärm produzieren auch in diesem Segment das vielzitierte Not in my backyard-Prinzip.
Investoren schrecken oft vor den Kosten zurück. Denn selten ist es damit getan, einfach nur ein Stockwerk aufzusatteln. Viele Bestandsimmobilien sind aufgrund von Statik und Bauphysik nicht auf ein oder gar mehrere weitere Stockwerke ausgelegt. Ihre Tragfähigkeit müsste also zunächst ertüchtigt werden. Das jedoch ist mit enormen Kosten verbunden. Weitere Hürden ergeben sich durch allzu starke, bauordnungs- und baurechtliche Regulierungen, etwa wenn es um Abstandsflächen, Trauf- / Firsthöhen oder Bebauungs- und Raumordnungspläne geht.
Die Zukunft der Nachverdichtung
Experten wie die Wissenschaftler von der TU Darmstadt messen der Nachverdichtung durch Aufstockung zukünftig eine entscheidende Rolle bei. Denn wenn Wohnraum immer knapper und neues Bauland sowohl rarer als auch teurer wird, führt an der Nachverdichtung kein Weg vorbei. Ob damit die allgemeine Wohnungsnot, die vor allem sozialverträglichen, bezahlbaren Wohnraum betrifft, bekämpft und ob dieses Potenzial zukünftig ausgeschöpft werden kann, muss sich noch zeigen.
Dr. Ulrich Nagel
IMMOBILIEN AKTUELL 53
SCHWERPUNKT: BESTANDSENTWICKLUNG
„Keine Leistung von der Stange“
Der Verband für Bauen im Bestand (BiB) hat sich auf Initiative der Greyfield Group gegründet. Vorstandsmitglied Nicola Halder-Hass spricht über Ziele, Silodenken und eine Überarbeitung der DIN-Norm.

IMMOBILIEN AKTUELL (IA): „Wir sind der Überzeugung, dass Machen immer besser ist als Nicht-Machen“, heißt es in einem Statement. Warum tut sich die Immobilienbranche so schwer mit dem Thema Bestand?
Nicola Halder-Hass (NHH): Lassen Sie mich zwei Beispiele geben: In ganz vielen Bereichen des Bauens wurden Normen, Richtlinien und Bauordnungen von Neubauplanung abgeleitet. Soll der Bestand saniert werden, bedarf es dafür bisher Abweichungen. Wir wollen, dass Bestandssanierung zur Norm wird, und Abweichungen in dieser Vielzahl im Bauantrag nicht mehr benötigt werden. Zweiter Punkt: Nicht jede Nutzung passt in jede Bestandsimmobilie, das macht die Projektentwicklung kompliziert. Es muss genau geprüft werden, ob die geplante Nutzung zur Entwurfslogik der Bestandsimmobilie passt, ansonsten kann die Umnutzung und Sanierung kostspielig werden. Insgesamt ist die Projektentwicklung komplex bis eine wirtschaftliche, nachhaltige und genehmigungsfähige Planung entstanden ist.
IA: Was möchte der Verband für Bauen im Bestand (BiB) erreichen?
NHH: Vorrangiges Ziel ist es, die Vorbehalte der Immobilienbranche gegenüber dem Bauen im Bestand, die in vielen „Ja, aber…“ geäußert werden, auf eine sachliche Arbeitsgrundlage zu stellen und Lösungswege anzubieten. Der Verein hat das Ziel, dem Thema eine Stimme zu geben. Die ist notwendig, um zielgerichtet und wegweisend die entscheidenden Fortschritte und Marktstandards für den Bestand zu gewährleisten, die für die Erreichung der Klimaziele und Nachhaltigkeitsstrategie der Bundesrepublik notwendig und sinnvoll sind. Der Verband soll zukünftig eine zentrale Plattform darstellen, um die Wege für Bestandsimmobilien zu ebnen. Der BiB wird die notwendige Unterstützung und den Wissenstransfer anbieten.
IA: Wie kam es zur Gründung?
NHH: Die Immobilienbranche ist verantwortlich für den Lebensraum von Millionen von Menschen. Neben der Wirkung von Immobilien auf soziale Faktoren wie Gesundheit, Wohlbefinden und Quartiersqualität sind Gebäude aufgrund der verwendeten Baumaterialien und der eingesetzten technischen Ausrüstung für
einen immens hohen CO₂-Ausstoß verantwortlich. Ein bewusster Umgang mit diesen Ressourcen hat einen enormen Beitrag zum Klimaschutz. Die Fokussierung auf den Bestand bietet die Möglichkeit, graue Emissionen zu vermeiden und vorhandene Substanz sinnvoll zu nutzen. Deswegen hat sich auf Initiative der Greyfield Group der Verband gegründet. Die Gründungsmitglieder bündeln damit Kompetenzen und sind für ein gemeinsames, umfassendes und lebenszyklusbasiertes Verständnis von Bauen im Bestand.
IA: Der Vorstand des BiB wolle „das Silodenken in der Branche durchbrechen, damit die Bauwende schneller kommt“. Was genau heißt das?
NHH: Wir müssen interdisziplinär sämtliche Fachbereiche an den Tisch holen und schauen, wie die Bestandsentwicklung zur Norm und die Neubauten zum Luxus werden, und wir müssen das vorhandene Wissen zum Bauen im Bestand zur Verfügung stellen.
IA: Eine der ersten Aktivitäten war die Erarbeitung einer Leitlinie namens BiB 276. Was verbirgt sich dahinter?
IMMOBILIEN AKTUELL 54 SCHWERPUNKT: BESTANDSENTWICKLUNG
NHH: Wir haben seit der Gründung im Februar dieses Jahres die verschiedenen „Ja, aber…“ identifiziert und in Themenbereichen geclustert. Eines der häufigsten Argumente gegen das Bauen im Bestand ist das „ja, aber die Kosten sind nicht transparent planbar“. Deswegen ist das Thema Kostensicherheit eines der vordringlichsten, für das wir jetzt eine Lösung mit der BiB 276 anbieten. Derzeit werden die Kosten im Bauwesen nach der DIN 276 berechnet. Die Norm ist für den Hochbau von Neubauprojekten erstellt worden und ermöglicht aus Sicht des BiB nur ungenügend die Bestandskostenerfassung. Die Ermittlung der Kosten in der Bestandsentwicklung erfordert zusätzliche Kostengruppen, wie beispielsweise planerische und gutachterliche Bestandsvoruntersuchungen, die Berücksichtigung der laufenden Bewirtschaftung oder Rückbauund Reparaturleistungen. Daher sind wir der Überzeugung, dass es eine Kostengliederung geben muss, die die Besonderheiten und Risiken bei Bestandsprojekten herausstellt und erfasst. Die

BiB 276 deckt diese Besonderheiten ab und lehnt sich dabei an die DIN 276 an. So werden beispielsweise Kostengruppen der neuen BiB der DIN zugeordnet, um nach wie vor in bekannten und anerkannten Strukturen zu planen und zu berichten. Dass diese Zuordnung nicht immer eineindeutig möglich ist, verdeutlicht die Notwendigkeit einer eigenen Kostengliederung für den Bestand. Die BiB 276 versteht sich als händelbare Arbeitstabelle sowie praktische Checkliste, die als roter Faden genutzt werden kann.

IA: Welche Aktivitäten sind für 2024 geplant?








NHH: Die „Ja, aber...“ liegen vor. Die Arbeit ist groß und wir haben zahlreiche neue Verbandsmitglieder für die Erarbeitung der Lösungen gewinnen können. Wir entwickeln derzeit eine Strategie, wann wir welche Themen ‚anpacken‘. Wir werden unter anderem eine Wissensplattform aufbauen. Und wir werden uns auch in den Bereichen des Risikomanagements, des zirkulären Bauens, der Nutzungskonzeption engagieren.
Mehrwert mit Highspeed.
































Wir bringen Ihre Immobilie ans Netz der Zukunft.
Wir sind Ihr regionaler Partner für den Glasfaserausbau.


Von der Quartiersplanung bis zum Hausanschluss. Eine zukunftsfähige Infrastruktur für Immobilien. Die stabile Basis für smartes Gebäudemanagement.

IA: Der Bestand ist durch die aktuellen Umgebungsfaktoren wie hohe Zinsen noch stärker in den Fokus gerückt. Trotzdem haben ja nicht alle Projektentwickler und Planer direkt eine Kompetenzsteigerung. Oder kann jeder Bestandssanierung?
NHH: Bestandsentwicklung ist keine Leistung von der Stange sondern erfordert komplexeres Handeln. Wenn man aber bereit ist, drei Millimeter weiterzugehen, den Bestand zum Ausgangspunkt der Planung zu machen, kann in heutigen Zeiten ein hochinteressantes, nachhaltiges und wirtschaftliches Projekt entstehen.
IA: Welche Schlagzeile würden Sie hinsichtlich der Aufgaben Ihres Verbandes gern lesen wollen?



NHH: Unsere Aufgaben titulieren wir mit den „Ja, aber...“ für die wir, Lösungen gemeinsam mit der Branche entwickeln. Daher wäre meine Lieblingsschlagzeile: Jawohl, Bestandsanierung lohnt sich!
Interview: Ivette Wagner
IMMOBILIEN AKTUELL 55 SCHWERPUNKT:
BESTANDSENTWICKLUNG
030 66765 147 www.dns-net.de immobilienwirtschaft@dns-net.de DNS:NET Internet Service GmbH · Zimmerstr. 23 · 10969 Berlin
Pilz-Power
An der TU Berlin wird seit Jahren an Baustoffen aus Pilzmyzel geforscht. Inzwischen haben die Biotechnologen viele Detailfragen geklärt. Jetzt geht es um die Zulassung und Überführung in die industrielle Produktion. Ein Gespräch mit Dr. Bertram Schmidt, Mitarbeiter und Pilzforscher am Institut für Angewandte und Molekulare Mikrobiologie.
IMMOBILIEN AKTUELL (IA): Müssen wir noch 20 Jahre warten, bis es nachhaltige Baumaterialien aus Pilzen im Baumarkt zu kaufen gibt?
Dr. Bertram Schmidt (BS): Wenn es nach unserem Forschungsteam geht, dann nicht. Unser Ziel ist es, Anlagen zu entwerfen und zulassungsfähige Pilzwerkstoffe in absehbarer Zeit in die Produktion zu überführen.
IA: Was werden das für Baumaterialien sein?

BS: Im Fokus unserer Forschungen stehen Plattenmaterialien mit ähnlichen Eigenschaften wie Bauplatten, aber auch Dämmmaterial für den Innenausbau sowie Verbundmaterialien. Diese können Alternativen zu herkömmlichen, nichtnachhaltigen Baustoffen wie Styropor und Mineralwolle sein.
IA: Welche Grundstoffe verwenden Sie?
BS: Pilze sind filamentöse, also fadenförmig wachsende Mikroorganismen. Sie bilden Fruchtkörper, aber bei uns im Zentrum steht das netzartige Myzel, das eine gewisse Stabilität und Zähigkeit hat. Wir forschen an
holzzersetzenden Pilzen, deren Myzel ins Holz wächst und dort Nährstoffe aufnimmt. Dieses Myzel züchten wir im Labor auf verschiedenen organischen Materialien. Zusammen bilden sie Komposite, die leicht und relativ druckstabil sind. Wir haben bislang mit rund 40 Pilzstämmen geforscht und mit ganz unterschiedlichen organischen Materialien. Denn die Pilze wachsen unter Laborbedingungen nicht nur auf Holzspänen, sondern zum Beispiel auch auf Stroh oder Hanfschäben. Der Zunderschwamm ist aufgrund seiner Eigenschaften unser Lieblingspilz. Als organisches Material verwenden wir gern Hanfschäben, also das zerstoßene holzige Material aus dem Inneren von Hanfstängeln. Denn dafür gibt es wenig Verwendung, außer als Pferdestreu. Für die Plattenwerkstoffe werden die Komposite getrocknet, das Myzel wirkt wie ein Kleber. Die Herstellung ist also keine Raketenwissenschaft, die Detailfragen haben es aber in sich.
IA: Worin liegen die Herausforderungen?
BS: Wenn ein Produkt industriell hergestellt und vermarktet werden soll, muss es reproduzierbare, also
immer gleiche Produkteigenschaften haben. Es geht aber auch um Fragen von Brandschutz, Wasserresistenz, Widerstandsfähigkeit, Elastizität. Mit herkömmlichen, nicht nachhaltigen Lösungen ist das sicher kein Problem, wir wollen aber, dass unsere Materialien, ausschließlich nachwachsend und biologisch abbaubar sind. Deshalb können wir keine ‚Chemie‘ untermischen. Das macht es schwieriger. Man muss die Materialien nach Ende der Lebensdauer gut voneinander trennen oder das Gesamtprodukt – bildlich gesprochen – am Ende geschreddert auf dem Acker unterpflügen können.
IA: Es gibt eine große Erwartungshaltung. Nicht nur bei Ihnen wird daran geforscht. Doch bislang ist wenig in der Praxis angekommen.
BS: Das ist richtig, denn Forschung braucht ihre Zeit, gerade wenn es um neue Materialien geht, für die es noch keine Produktionsanlagen gibt. Auch müssen Zertifizierungen komplett neu gedacht werden. Daher ist unser Ziel, ein echtes Pilzhaus im Jahr 2030 fertiggestellt zu haben. Ein weiterer Grund sind die Rahmenbedingungen. Solange erdölbasierte Baustoffe so billig
IMMOBILIEN AKTUELL 56
BAUEN & ROHSTOFFE
sind und externe Kosten nicht eingepreist werden, sind Pilzmaterialien so schnell nicht konkurrenzfähig. Das ist bei innovativen Dingen oft so, davon lassen wir uns nicht abschrecken. Wir forschen am Zunderschwamm weiter, der eine harte, wasserabweisende Oberfläche bilden kann. Wir wollen die Eigenschaften besser verstehen, die auslösenden Faktoren finden und steuern können. Die Biologie beeinflussen kann nicht jeder, da werden die Materialien dann noch viel interessanter.
IA: Für die von Ihnen genannten Verwendungen gibt es einen riesigen Markt. Wenn solche Materialien am Ende Sand, Erdöl und mineralische Rohstoffe ersetzen sollen, werden riesige Mengen an organischen Materialien gebraucht. Haben sie sich darüber Gedanken gemacht?


BS: Ja, gleich zu Beginn unserer Forschung haben wir die Material-
ströme gemeinsam mit Experten analysiert und sind zu dem Schluss gekommen, dass wir den Weg gehen wollen. Es wird Landwirtschaft gebraucht, das stimmt. Erdöl braucht die nicht. Aber wir wollen ja hin zu nachwachsenden Materialien. Wir müssen dafür neue Quellen erschließen. Sehr viele Reststoffe aus Land- und Forstwirtschaft sind geeignet, um mit unterschiedlichen Pilzen Materialien herzustellen. Wir sind im engen Austausch mit Partnern aus der Landwirtschaft, die landwirtschaftliche Nebenprodukte und Reststoffe vorschlagen, auf die wir selbst nicht kommen würden. Fast alle organischen Materialien aus der Landwirtschaft sind prinzipiell geeignet. Theoretisch würden auch auf Rinderdung Pilze wachsen, nur will niemand eine Platte aus Rinderdung an der Wand. Wir experimentieren daher mit verschiedenen Stoffen, um deren Potenzial auszuloten.
IA: Sie haben bereits eine Art Haus aus Pilzmaterial gebaut. Welche Erfahrungen habe sie gemacht?
BS: Im Rahmen eines Kunstprojektes haben wir vor zwei Jahren im Frankfurter Metzlerpark einen bewohnbaren Pavillon aus Pilzplatten gebaut: MY-CO SPACE. Er ist jetzt in Berlin in der TU-Bibliothek ausgestellt. Er musste allerdings mit einer Plane überspannt werden, um ihn vor Regen zu schützen, denn noch ist unser Material nicht wasserdicht. Wir bekamen durch dieses Projekt viel Aufmerksamkeit und Zuspruch für unsere Forschung und jede Menge Anfragen zu möglichen Anwendungen. Persönlich habe ich für Pilze noch eine andere Verwendung. Ich gehe zu jeder Jahreszeit mit pilzbegeisterten Freunden in den Wald, um Pilze zu sammeln. Die hauen wir uns dann in die Pfanne.
Interview: Mara Kaemmel
IMMOBILIEN AKTUELL 57
BAUEN & ROHSTOFFE
„Immer noch Vorurteile und Skepsis“
In Deutschland fehlen 700.000 Wohnungen. Die Politik fordert technologischen Fortschritt von der Baubranche, damit schneller und kostengünstiger gebaut werden kann. Nasim Fahimian, Abteilungsleiterin Modulares Design bei der Münchener SEMUDO AG, sagt, was vom Modulbau zu erwarten ist.
IMMOBILIEN AKTUELL (IA): Sie sind Anfang 2023 zur SEMUDO AG gewechselt, einem Unternehmen, dass sich für Modulbau engagiert. Was reizt Sie als Architektin an einer Branche, mit der die meisten Menschen gestapelte Container assoziieren?

Nasim Fahimian (NF): Das werde ich oft gefragt, aber für mich liegt die Zukunft im Modulbau. Mit industriell gefertigten Modulen kann schnell und kostengünstiger produziert werden. Die Produktivität liegt bis zu 50 Prozent höher als im konventionellen Bau. Es gilt aber auch zu zeigen, dass mit Modulen nicht nur zweckmäßige und preisgünstige, sondern auch ästhetische und architektonisch ansprechende Häuser gebaut werden können.
IA: Ist Modulbau damit die Lösung für bezahlbaren Wohnraum?
NF: Das hängt natürlich von verschiedenen Faktoren ab. Kürzere Bauzeit und geringere Kosten sind zwei Aspekte, die für den Modulbau
sprechen. Hinzu kommt die Nachhaltigkeit: Durch die effiziente Nutzung von Materialien und die Reduzierung von Bauabfall wird der ökologische Fußabdruck verringert. Außerdem können modulare Gebäude leichter demontiert und umgebaut werden, was zu einer längeren Lebensdauer und einem geringeren Abfallaufkommen führen kann. Die Digitalisierung der Planung und der Einsatz von BIM tragen dazu bei, die Effizienz und Präzision des modularen Wohnungsbaus zu erhöhen.
IA: Das klingt gut, trotzdem wird landauf, landab vor allem konventionell gebaut.
NF: Das ist richtig. Andere Länder sind da schon weiter, dazu gehören Schweden und Japan. Auch die Niederlande hat sich im Bereich des modularen Wohnungsbaus einen Namen gemacht. Obwohl sich die Wahrnehmung von modularem Bauen hierzulande in den letzten Jahren verbessert hat, gibt es immer noch Vorurteile und Skepsis.
Modulbau wird von einigen für minderwertig oder ästhetisch wenig ansprechend gehalten.
IA: Die Befürchtung ist ja, dass der Kostendruck am Ende dazu führt, dass die Städte voller anspruchsloser Klötzer stehen.
NF: Die Gefahr sehe ich. Aber Modulhäuser lassen sich viel individueller gestalten als man denkt. Zwar besteht die Grundstruktur aus standardisierten Modulen, es können aber verschiedene Module kombiniert und angepasst werden, um unterschiedliche Grundrisse, Raumgrößen und architektonische Designs zu ermöglichen. Kunden können aus einer Palette von vorgefertigten Optionen wählen. Mit den Modulen lässt sich vom Tiny-House bis zum Hochhaus alles bauen. Gerade arbeiten wir an einem Projekt für Mikroapartments, damit Studenten eine gute und bezahlbare Bleibe finden. Die verwendeten Materialien bieten großen Gestaltungsspielraum, Holz zum Beispiel.
IMMOBILIEN AKTUELL 58
Individualität ist in jedem Fall eine Herausforderung für den Modulbau. Die modulare Bauweise muss in der Lage sein, individuelle Bedürfnisse zu erfüllen, ohne dabei die Effizienz und Vorteile der Vorfertigung zu verlieren.
IA: An welchen Projekten arbeiten Sie gerade?
NF: Aktuell bearbeiten wir acht Projekte in den Regionen Nord und Süd. Unser Team in Berlin fokussiert sich auf Berlin, Hannover und Schwerin. Im Süden verantworten wir Projekte in Marbach am Neckar, Heilbronn, Wernau und Steinheim. Im März 2023 haben wir unser Projekt in Leverkusen erfolgreich fertiggestellt.
IA: Gibt es aus Ihrer Sicht genug
Produktionskapazität in Deutschland?
NF: In einigen Regionen Deutschlands wurden verstärkt Produktionskapazitäten für den modularen Wohnungsbau geschaffen, unter anderem in Berlin und Brandenburg. Aber bei hoher Nachfrage kann es zu Engpässen kommen. Mit steigender Nachfrage ist zu erwarten, dass die Produktionsinfrastruktur ausgebaut wird. So planen wir zum Beispiel gemeinsam mit der Haubner Group ein neues Werk in Neumark in der Oberpfalz. Der Automatisierungsgrad der Fertigung wird beispielgebend sein.

IA: Sie arbeiten an einem internationalen Partnerpool zur Umsetzung der Plattformtechnologie. Was bedeutet das konkret und wie stellen Sie sich
den Wohnungsbau der Zukunft vor?
NF: Wir sehen uns auf globaler Ebene nach Partnern um, die bei der Entwicklung und Implementierung der Plattformtechnologie unterstützen können. Dieser Partnerpool könnte aus verschiedenen Unternehmen, Organisationen oder Fachleuten bestehen, die über das erforderliche Fachwissen, die Erfahrung oder die Ressourcen verfügen, um das Projekt erfolgreich umzusetzen. Die Zukunft sehen wir in innovativen Veränderungen, zum Beispiel in der Integration von Virtual Reality, Augmented Reality und künstlicher Intelligenz. Diese Technologien können dazu beitragen, Planung, Design und Bau von Wohngebäuden zu optimieren und individuelle Anforderungen besser zu erfüllen.
Interview: Mara Kaemmel
IMMOBILIEN AKTUELL 59
BAUEN & ROHSTOFFE
Schadstoff & Abriss
Mehr als 100 Jahre wurde auf dem zehn Hektar großen Areal in Berlin-Oberschöneweide produziert. Die Firma WESSLING Consulting Engineering untersucht die Gebäude seit 2020 im Auftrag der DIE Deutsche Immobilien Entwicklungs AG (DIEAG) auf Schadstoffe. Von Anfang an ist das Projekt eine gewaltige Herausforderung, entstehen soll hier das neue Gewerbequartier BE-U am Behrens-Ufer.
Mehr als 100 Jahre wurde auf dem Gelände rund um den historischen Peter-Behrens-Bau in Oberschöneweide Industriegeschichte geschrieben. In den Stockwerkfabriken auf dem zehn Hektar großen Areal am Ufer der Spree erfolgte die Produktion von Autos und Flugzeugteilen. Später kamen Fernmeldetechnik, Sendeanlagen, Spezialröhren, Halbleiter, zu DDR-Zeiten dann Fernsehelektronik dazu. Nach der Wende stellte Samsung hier weiter Farbbildröhren her. 2006 kam das endgültige Aus für den Industriestandort. In den nächsten Jahren plant der jetzige Eigentümer, die DIE Deutsche Immobilien Entwicklungs AG (DIEAG), das Gewerbegebiet neu zu beleben. Insbesondere durch eine klimaverträgliche Energieversorgung soll das Vorhaben zu einem Leuchtturmprojekt werden. Doch bevor das mit 1,1 Milliarden Euro kalkulierte Bauvorhaben in Oberschöneweide richtig




Fahrt aufnehmen kann, ist Ulrike Taudien von der Firma WESSLING Consulting Engineering (WCE) gefragt. Sie spürt im Auftrag der DIEAG seit drei Jahren die Schadstoffe auf, die im Laufe der Geschichte in den Gebäuden verbaut worden oder angefallen sind. „Wir haben bislang nichts Unerwartetes gefunden, aber alles, was zu erwarten war“, sagt sie. Und das hat es in sich.
Das kleinste Problem ist der denkmalgeschützte Peter-Behrens-Bau selbst. Hier sind es vor allem bleihaltige Farben, mit denen die Holztüren gestrichen sind. Das Aufarbeiten erfordert besondere Arbeitsschutzmaßnahmen. In einer Halle im Hof dahinter wurden für den Anstrich der Dachbalken Holzschutzmittel verwendet. Die Halle steht unter Denkmalschutz. „Die Balken müssen versiegelt werden“, betont die Schadstoff-Expertin. Und so sehr sie den Denkmalschutz verstehen kann, würde sie dafür


IMMOBILIEN AKTUELL 60 BAUEN & ROHSTOFFE
plädieren, behandelte Holzteile auszutauschen. „Wir wissen, dass diese Teile, wenn sie erhalten bleiben, ewig Aufwand bedeuten. Alles, was wir als Gesellschaft konservieren, hat irgendwann wieder jemand in der Hand.“

Zur größten Schadstoffgruppe auf dem Areal zählt allerdings der krebserregende Asbest. Der einstige Wunderbaustoff findet sich in den Gebäuden am Behrens-Ufer als Wellasbest auf Dächern und an Fassaden, in Schächten und Ummantelungen. Dort, wo die Bagger bereits die Werkhallen aus DDR-Zeiten niederreißen, liegen Säcke voller asbesthaltiger Teile, die später auf Deponien endgelagert
von Holzfaserplatten in den Trümmerhaufen findet, kann das Material nicht wiederverwendet werden und landet als Betonabfall ebenfalls auf einer Deponie. Auch verölte Maschinenteile können nicht einfach auf den Schrott und müssen extra gelagert werden. „Da es in Berlin nur begrenzte Kapazität auf Deponien gibt, muss der Rest auf Deponien anderer Bundesländer gefahren werden – und das ist teuer.“ Die Kosten für die Schadstoffanalyse sind mit rund 200.000 Euro eher ein kleiner Posten im Gesamtbudget. Der Abriss und die Entsorgung kosten das Zehnfache, schätzt Vassilios Lasos, Diplom-Ingenieur und Berater bei WCE.



werden. Auf dem Gelände wurden darüber hinaus Teerpappen auf Dächern verbaut, Schächte und Klimakanäle mit Mineral- und Glasfaserwolle gedämmt, Wände mit Styropor beklebt und Polyuretan-Schäume zum Abdichten von Betonfugen verwendet. Teile der Fußböden sind mit Öl kontaminiert.
Auf dem Gelände lässt sich gut erkennen, welche Herausforderung der Rückbau von Bestandsgebäuden heute ist. Zum einen müssen Schadstoffe einzeln separiert, aber auch die alten Baustoffe möglichst sortenrein getrennt werden. So finden sich hier neben den Haufen mit Säcken voller Asbest, Mineral- und Glaswolle sowie Polyuretan-Schaum, auch Berge von Betontrümmern. „Auf so einer Abrissbaustelle fällt eine Menge Material an. Die Frage ist dann immer, wie viel sich davon wirklich recyceln lässt.“ Wenn Ulrike Taudien nach dem Abriss Teerpappe, Asbestreste oder Reste



Doch die Auftraggeber sind an einer genauen Analyse interessiert. Zum einen sind Schadstoffgutachten Pflicht, zum anderen können auf deren Basis die Entsorgungskosten genau kalkuliert werden. „Wenn Abrissfirmen unerwartet auf Schadstoffe stoßen, dann werden Nachtragszahlungen fällig.“ Nicht nur die Gebäude auf dem Areal sind mit Schadstoffen belastet, sondern auch das Grundwasser. Es ist mit Flurkohlenwasserstoffen (FCKW) kontaminiert. Bereits kurz nach der Wende wurde das ehemalige Werk für Fernsehelektronik als eine der Schadstoffquellen identifiziert. Seit den 2000er Jahren wird das Grundwasser im Umfeld saniert. Laut der Senatsverwaltung belief sich das Investment bis Ende 2018 auf 3,8 Millionen Euro, rund 50 Tonnen FCKW entfernte man. Die Grundwassersanierung läuft derzeit auf dem Areal weiter.
Mara Kaemmel
IMMOBILIEN AKTUELL 61 BAUEN & ROHSTOFFE
Investors neuer Liebling
Sozialimmobilien mausern sich zu einer eigenen Assetklasse, die weitgehend konjunkturunabhängig ist und daher stabile Cashflows verspricht. Doch welche Einrichtungen gelten überhaupt als Sozialimmobilien und gibt es wirklich kaum Risiken?
Steigende Nachfrage, geringes Risiko, stabiler Cashflow – Sozialimmobilien scheinen nur Vorteile zu bieten. Obendrein liefern Studien zu dieser Anlageklasse beruhigende Prognosen. Im Frühjahrsgutachten Immobilienwirtschaft 2023 konstatiert der Rat der Immobilienweisen zum Beispiel: „Pflegeimmobilien und Servicewohnen für Senioren sind aufgrund des demografischen Wandels nachfrageseitig sehr stabil. Ihre hohe Auslastung und die im Gesundheits- und Sozialbereich üblichen langfristigen Mietverträge minimieren das Investitionsrisiko.”
Kein Wunder also, dass Pflegeheime und Seniorenresidenzen, aber auch Reha-Kliniken, Ärztehäuser und medizinische Versorgungszentren hoch im Kurs stehen. Laut einer Umfrage von Cushman & Wakefield sind bereits
76 Prozent der befragten Investoren und Projektentwickler im deutschen Gesundheitsimmobilienmarkt engagiert. Weitere sechs Prozent arbeiten an einem Markteinstieg.
Dazu zählt Dr. Matthias E. Lollert. Der Finanzvorstand der GOLDEN AGE AG will mindestens 100 Millionen Euro in Sozialimmobilien investieren – pro Jahr. „Bislang waren wir für Dritte tätig. Jetzt bauen wir mit einer neuen Strategie unseren eigenen Bestand auf“, sagt der CFO. Die neue Strategie lautet: Weg vom Pflegebereich, für den es in jedem Bundesland ein anderes Gesetz gibt, hin zum Servicewohnen. „Viele Menschen wollen auch im Alter selbstbestimmt leben. Darum bauen wir klassische Wohnungen, aber barrierefrei, rollstuhlgerecht und auf Senioren ausgerichtet. Das heißt, es wird Gemeinschaftsräume und Bibliotheken geben, vor

IMMOBILIEN AKTUELL 62
allem aber kooperieren wir mit Pflege- und Service-Dienstleistern. So können die Mieter benötigte Services modulartig vor Ort in Anspruch nehmen“, erläutert Dr. Matthias E. Lollert sein Konzept.
Aussichtsreiche Assetklasse
Gesundheits- und Pflegeimmobilien, Rehabilitationseinrichtungen und seniorengerechter Wohnraum entwickeln sich durch den demografischen Wandel vom Nischenmarkt zur aussichtsreichen Assetklasse. Laut BNP Paribas Real Estate leben bereits in zwölf Millionen Haushalten pflegebedürftige Menschen, aber nur eine Million Wohnungen sind barrierefrei beziehungsweise altersgerecht gestaltet – ein großer Markt für Projektentwickler und Investoren. Auch betreutes Wohnen und ähnliche Konzepte bieten Renditechancen für alle, die bezahlbaren Wohnraum und ebensolche Services anbieten können.

Doch es gibt noch einen weiteren Aspekt, der Sozialimmobilien für Investoren interessant macht: Sie eignen sich bestens für den Aufbau ESG-konformer Portfolios, da es sich um Immobilien mit gesellschaftlichem Nutzen handelt. Laut BNP Paribas Real Estate gibt es bereits einen „Run“ auf entsprechende Objekte in dieser Assetklasse.
Apropos Assetklasse: Was zählt eigentlich zu den Sozialimmobilien und was nicht? Darüber herrscht noch keine Einigkeit in der Branche. Die Begriffserklärungen reichen von Sozialwohnungen über Einrichtungen für Gesundheit, Pflege und Betreutes Wohnen bis hin zu Immobilien der öffentlichen Infrastruktur. „Wir arbeiten noch an einer Definition“, sagt Dominik Barton, CEO der Barton Group. Mit „Wir“ meint er die von der Barton Group und audere Gesellschaftsimmobilien gegründete Initiative Immobilien der öffentlichen Infrastruktur. Sie will Transparenz
in diesem Marktbereich schaffen. Dominik Barton selbst unterscheidet Immobilien der öffentlichen Infrastruktur übrigens in Sozialimmobilien und Immobilien der öffentlichen Verwaltung.
Dass auch Letztere, sprich Ämter, Feuerwachen, Schulen und so weiter, ein interessantes Investment sein können, zeigt der Investitionsstau von rund 150 Milliarden Euro. Den Kommunen fehlen die Mittel, um ihre öffentlichen Gebäude zu modernisieren oder gar neue zu bauen, etwa Bibliotheken oder Kitas. Hier bieten sich Gelegenheiten für Investoren, schließlich ist die öffentliche Hand als Projektpartner und langfristiger Mieter ein Garant für Stabilität in unsicheren Zeiten.
Die größten Risiken für Investoren
Bleibt die Frage: Wie risikoarm sind Immobilien der öffentlichen Infrastruktur wirklich? Laut Cushman & Wakefield sehen Investoren in der Betreiberabhängigkeit, der Betreiberqualität und der Refinanzierungsstruktur die größten Risiken. CBRE verweist zudem auf knappes Bauland, Lieferengpässe und steigende Bau-, Lohn und Energiekosten, wodurch sich die Entstehungs- und Betriebskosten insbesondere für Pflegeheime so verteuerten, dass sich deren Neubau und Betrieb oft nur mit staatlichen Zuschüssen rechne. BNP Paribas Real Estate beobachtet darüber hinaus, dass die Pandemie und die Rekordinflation den Betreibern kostenseitig zugesetzt haben.
Aufgrund dieser Gemengelage kommen Investoren nicht um genaueste Analysen herum. Doch die Mühe lohnt sich, generieren Sozialimmobilien doch langfristige und sichere Cashflows, von der Möglichkeit zur PortfolioDiversifizierung unter ESG-Aspekten ganz abgesehen.
Frank Baecke
IMMOBILIEN AKTUELL 63 SCHWERPUNKT: NEUE ASSETKLASSEN
Immer weiter?
Life Science ist auf dem Vormarsch. Prognostiziert werden hohe Bedarfe. Allerdings könnte diese Assetklasse ausgebremst werden durch pausierende oder abgesagte Projektentwicklungen. Investoren finden Angebote auch im Ausland.

In Mainz ist Life Science schon seit Jahren ein großes Thema, doch die Aufmerksamkeit wird nun deutschlandweit immer größer. Im Juli 2023 verkündete das Startup LigniLabs in das Auftaktgebäude LAB 1 am neuen Biotechnologie- und Life Science-Standort am Stadteingang einzuziehen. Die J. Molitor Immobilien GmbH, die G.L. Kayser Immobilien GmbH und die IGM Immobilien Gesellschaft Mainz mbH entwickeln gemeinsam die Laborflächen namens Innovationlabz in direkter Nachbarschaft zu Universität, Hochschule und namhaften Forschungsinstituten. Die Fertigstellung ist für 2025 geplant. LigniLabs arbeitet dort an einem biotechnologischen Fungizid, dessen Wirkstoff die Rebstock-Pilzkrankheit Esca im Zaum halten soll. Durch ein kleines Bohrloch wird der in Mikrokügelchen verkapselte Wirkstoff in den Rebstamm injiziert. Der Pilz stirbt durch die Aufnahme ab. „Das LAB 1 ist nur der Auftakt. Wir entwickeln mit Hochdruck weitere Laborgebäude, um die hohe Nachfrage schnellstmöglich zu bedienen“, sagt Molitor-Geschäftsführer F. Albrecht Graf von Pfeil. Der Bauantrag für das LAB 2 mit rund 8.000 Quadratmetern ist bereits eingereicht.
Die BEOS AG kaufte für den Spezial-AIF BEOS Light Industrial Germany I einen mehr als 5.200 Quadratmeter großen Life Science-Neubau im Technologiepark Adlershof im Südosten Berlins, der 2023 fertiggestellt wurde. Es ist eine Sale-and-Lease-Back-Transaktion, bei der das Biotechnologie-Unternehmen SCIENION einen Mietvertrag über 15 Jahre abschloss. Das Unternehmen produziert am Hauptsitz Dispensiersysteme, mit denen Flüssigkeiten im Nanound Picoliterbereich aufgetragen werden. Zur Anwendung
IMMOBILIEN AKTUELL 64 Bremen Hamburg Berl n Potsdam Rostock Magdeburg Leipz g Dresden Göt t ngen Gießen Marburg Wiesbaden Mainz He delberg Nürnberg Stut tgar t Düsseldor f Frank fur t am Main Frank fur t am Main München am Main Rüsse sheim Hof heim Bad Homburg Hanau München Kirchhe m P aneg g Neur ed sman ng Hallbergmoos Unterschleißheim Garching Köln DEUT SCHL A NDW E IT R EGI S TR IE RTE LIFE SCIE NCE S & TECH- A B SCHLÜS S E 2 018 – 2 02 2 A bschluss: 2018 2019 2020 2021 202 2 A nzahl A bschlüsse: 1 – 2 3 – 10 11 – 20 über 20
Bremen Hamburg Berlin Pot sdam Ros tock Magdeburg Leipzig Dresden Göt tingen Gießen Marburg Wiesbaden Mainz Heidelberg Nürnberg Stut t gar t Düsseldor f Frank fur t am Main Frank fur t am Main München am Main Rüsselshe m Hof heim Bad Homburg Hanau München Kirchheim Planeg g Neuried Isman ng Hallbergmoos Unterschleißheim Garching Köln S CHL A NDW E I T R EG I S T R IE R T E LIFE S CIE NCE S & T ECH- A B S CHLÜ S S E 2 0 18 – 2 02 2 A bschluss: 2018 2019 2020 2021 202 2 A nz ahl A bschlüsse: 1 – 2 3 – 10 11 – 20 über 20 Bremen Hamburg Berlin Pot sdam Ros tock Magdeburg Le pz g Dresden Göt t ngen Gießen Marburg W esbaden Mainz Heidelberg Nürnberg Stut gar t Düsseldor f Frank fur t am Main Frank fur t am Main München am Main Rüsselsheim Hof heim Bad Homburg Hanau München Kirchheim Planeg g Neur ed Ismaning Hallbergmoos Unterschle ßheim Garching Köln U T S CHL A NDW E I T R EG I S T R IE R T E LIFE S CIE NCE S & T ECH- A B S CHLÜ S S E 2 0 18 – 2 02 2 A bschluss: 2018 2019 2020 2021 202 2 A nz ahl A bschlüsse: 1 – 2 3 – 10 11 – 20 über 20 Deutschlandweit registrierte Science- & Tech-Abschlüsse 2018 bis 2020 Quelle: Colliers Market Intelligence & Foresight
kommt das beispielsweise bei Schwangerschaftsteststreifen oder Allergietests. Man wolle zum weiteren Ausbau des wachsenden Biomedizin-Clusters vor Ort beitragen, heißt es von SCIENION. Die DEUTSCHE FINANCE GROUP platzierte einen Alternativen Investmentfonds: Privatanleger und finanzstarke institutionelle Investoren glauben hier an zwei Projektentwicklungen für Labor-Büro-Gebäude mit einer Gesamtnettomietfläche von etwa 63.200 Quadratmetern sowie an die Weiterentwicklung des innovativen Life Science-Campus Boynton Yards im amerikanischen Boston. Es lassen sich noch mehr Investments finden. Life Science ist als Assetklasse und Diversifikationsmöglichkeit in den Köpfen der Immobilienbranche angekommen. Die Nachfrage steigt stetig. Die Wirtschaftsförderung Jena –das Zentrum für Life Science in Mitteldeutschland – reagierte und veröffentlichte einen Labormarktbericht. Bis Ende 2023 entstehen in der thüringischen Stadt knapp 9.000 Quadratmeter Laborflächen. Für die nächsten fünf Jahre sagt der Bericht einen Bedarf von 12.000 Quadratmetern voraus. Dazu braucht es Flächen für Neuansiedlungen, um die Dynamik des Standortes weiterzuentwickeln. Neben den erhöhten Anforderungen, die unter anderem spezielle Deckenhöhen für Abluftanlagen oder Deckentraglasten beinhalten, sind integrierte, urbane Lagen erwünscht – auch, um Kontakt zu anderen Nutzungen und der gewollten, damit einhergehenden Vernetzung gerecht zu werden.





Das Analysehaus Colliers veröffentlichte zur Life Science-Thematik ein White Paper. 2022 betrug der Flächenumsatz deutschlandweit mit 302.000 Quadratmetern rund


70 Prozent mehr als noch 2018, heißt es darin. Nur etwa 43 Prozent der Mietvertragsabschlüsse erfolgten im Bestand, was klar für die bereits erwähnten speziellen Anforderungen spricht. Was daraus folgt? Life Science ist auf Neubau angewiesen. „Bis 2025 werden nach aktuellem Kenntnisstand nur etwa 330.000 Quadratmeter fertiggestellt. Dies in Kombination mit einer steigenden Nachfrage könnte zu einer starken Angebotsknappheit führen“, sagt Christian Kadel, Head of Capital Markets von Colliers in Deutschland. Nutzer und Mieter seien grundsätzlich bereit, höhere Mieten zu zahlen, die aufgrund der Rentabilität des Sektors leistbar sind. Wichtigstes Argument: der Wettbewerb um die besten Talente. Dazu kommt eine hohe ESG- und SmartBuilding-Konformität.
Die große Nachfrage ruft laut Colliers zunehmend spezialisierte Projektentwickler und Investoren auf den Plan. „Das Risiko einzelner Nutzer, nach kurzer Zeit zu scheitern, reduziert sich für den Entwickler und Eigentümer aufgrund der Wachstumsdynamik der Branche, des Nachfrageüberhanges insbesondere innerhalb etablierter Cluster und der hohen Bindung des Nutzers an seine Fläche, die er oft mit Eigen- oder Fördermitteln ausgestattet hat.“ Momentan gibt es eine starke Fokussierung auf die Top7-Städte und das jeweilige Umland. Die Großräume München, Berlin, Frankfurt am Main und Hamburg sind gesetzt, Städte wie Düsseldorf, Köln und Stuttgart nehmen die Entwicklung seit 2021 mit. Flankiert von Universitätsstädten wie Leipzig, Jena oder Heidelberg. Und eben Mainz.
Ivette Wagner
IMMOBILIEN AKTUELL 65 SCHWERPUNKT: NEUE ASSETKLASSEN www.bosch-einfach-heizen.de Technik fürs Leben Noch Fragen: bit.ly/bosch-bt oder QR-Code scannen: Nachhaltigkeit für jedes Zuhause Einfach alles aus einer Hand. Komfort Luftreiniger Air 4000/6000 Energie Wallbox Power Charge 7000i Smart Energiemanager Wärmepumpe CS 5800/6800i AW Wärme
„Berlin muss den Vergleich mit dem Silicon Valley nicht scheuen“
Gabriel Khodzitski, CEO und Gründer der PREA Group, beschäftigt sich seit Jahren mit Rechenzentren. Mit seinem Beratungs- und Dienstleistungsunternehmen, das mittels künstlicher Intelligenz arbeitet, analysiert er für alle Marktaktivitäten der Immobilienbranche Mikrolagen.

IMMOBILIEN AKTUELL (IA): Bisher galt immer Frankfurt am Main als der Standort für Rechenzentren, in welchen Regionen gibt es noch Potenzial?
Gabriel Khodzitski (GK): In Deutschland ist Berlin nach Frankfurt der Datacenter-Standort mit dem größten Entwicklungspotenzial. Mittel- bis langfristig spricht vieles dafür, deutsche Rechenzentren verstärkt in der Nähe von Berlin zu entwickeln – sowohl unternehmenseigene Immobilien als auch anmietbare Co-Locations. Dieselben Vorteile, die die Finanzindustrie einst in Frankfurt vorfand, gelten wiederum für den ‚neuen‘ Rechenzentrum-Standort Berlin. Die Vorteile der Hauptstadt liegen auf der Hand, unter anderem mit der direkten Anbindung
an den größten FinTech-Standort Deutschlands. Generell braucht Berlin den direkten Vergleich mit dem Silicon Valley, Mumbai oder Tel Aviv nicht mehr zu scheuen und lockt zunehmend internationale Großkonzernen wie Tesla in seine Metropolregion und die Speckg ürtel. Zudem profitiert es von der Nähe zu Osteuropa. Gegenüber Frankfurt bietet Berlin auch einen standortbezogenen Sicherheitsvorteil: Es gilt nicht als Gefahrengebiet für Erdbeben.
IA: Was spricht für Deutschland?
GK: Für Datacenter spielen die Themen Sicherheit und Leistungsstabilität eine enorm wichtige Rolle. Deutschland zeichnet sich vor allem
durch die Infrastruktur der Stromversorgung und die hohen Anschlussleistungen aus. Neben dem großen Vorteil, dass sich der weltgrößte Internetknoten in Frankfurt am Main befindet, punktet Deutschland mit seinen hohen Datenschutzstandards. Abstriche muss die Bundesrepublik bei den hohen Strompreisen machen, kann dafür jedoch höchste Standards bei der Rechtssicherheit und der Nähe zu Kundenunternehmen setzen.
IA: Rechenzentren rücken immer mehr in den Fokus institutioneller Investoren: Dient das ausschließlich zur Diversifikation?
GK: Rechenzentren gelten auf dem internationalen Markt nicht mehr
IMMOBILIEN AKTUELL 66 SCHWERPUNKT: NEUE ASSETKLASSEN
SCHWERPUNKT:
als neue Assetklasse. Obwohl es in Deutschland etwas länger gedauert hat, haben sich weltweit die größten REITs bereits seit Jahren auf Datacenter-Projekte fokussiert, da die Transaktionsvolumina schnell eine Milliarde oder mehr erreichen können. Datacenter bieten Investoren attraktive Nutzer mit solider Bonität und langfristigem Ertragspotenzial. Die Mieter sind stark an die Immobilien und Standorte gebunden, da sie erhebliche Investitionen in ihre spezifische IT-Infrastruktur getätigt haben. Aufgrund der hohen Kosten durch Ausfallzeiten sind Umzüge äußerst unwahrscheinlich. Dies verleiht Datacentern eine hohe Cashflow-Sicherheit.
IA: Wie hoch sind die Renditen?
GK: Die Renditen liegen im Bereich von vier bis fünf Prozent.
IA: Wie viel Bedarf besteht in Deutschland an Rechenzentren?
GK: Bis 2030 wird sich das Datenvolumen um das 30-fache erhöhen, wodurch der Bedarf an zusätzlichen Datacenter-Kapazitäten jährlich um
30 Prozent steigen wird. Im internationalen Vergleich hinkt Deutschland in einigen Grundpfeilern der DatenInfrastruktur hinterher, etwa bei der Downloadgeschwindigkeit und dem Glasfaseranteil. Dennoch ist Deutschland bereits heute der zweitgrößte Markt für Connected Cars nach China. Dies verdeutlicht das enorme Entwicklungspotenzial, das Deutschland in den kommenden Jahren hat.
IA: Bei der Ladekapazität von E-Fahrzeugen kommt Deutschland bereits an seine Grenzen: Wie soll das dann erst mit Rechenzentren werden?
GK: Der wesentliche Unterschied zwischen Ladesäulen und Rechenzentren liegt darin, dass Rechenzentren die Energie punktuell an einem einzigen Ort beziehen, während E-Ladesäulen eine weit verzweigte Infrastruktur voraussetzen, die flächendeckend zu einer erhöhten Netzbelastung führt. Aktuell wird daran gearbeitet, die benötigte Energie direkt auf dem DatacenterGrundstück zu erzeugen, beispielsweise durch moderne Brennstoffzellen, was eine eigenständige Versorgung bedeutet.
Mega Megawatt
Der Bedarf an Rechenzentren steigt weiter, immer mehr Player drängen auf den deutschen Markt. Neben den klassischen gewinnen weitere Standorte an Aufmerksamkeit.
Im Juni 2023, der deutsche Immobilienmarkt in Starre verfangen, verkündet CloudHQ bereits den zweiten Deal des Jahres: Der Entwickler und Betreiber von hochskalierbaren Hyperscale-Datacentern erwirbt ein Industriegelände in Offenbach und damit das vierte Projekt in Deutschland. Ab Sommer 2024 entsteht auf einem 50.000 Quadratmeter großen Grundstück ein Rechenzentrum mit 92 Megawatt IT-Last und einem Investitionsvolumen von über einer Milliarde Euro. Es klingt fast zu schön: Damit es glatt läuft, hat das Unternehmen bereits im Vorfeld alles mit der Stadt Offenbach abgesprochen, die Umweltstandards sind klar, neue Grünflächen gehören zur Planung, die Abwärme kommt der städtischen Fernwärmeversorgung zugute. Peter Knapp, Executive Vice President von CloudHQ
IA: Rechenzentren gelten gemeinhin als kompliziert für die Nachbarschaft, weil sehr laut und von starker Hitze begleitet: Wie können Nachbarn überzeugt werden?
GK: Moderne Datacenter tragen eine Verantwortung, den Herausforderungen der Zukunft gerecht zu werden. Das bedeutet, effizient und nachhaltig mit der benötigten Energie umzugehen und die Abwärme idealerweise an die direkte Nachbarschaft oder umliegende Quartiere zurückzuführen, um einen sozial gerechten Zugang zur Energie- und Wärmeversorgung zu ermöglichen. Das PREA-Projekt Bluestar, das in Berlin umgesetzt wird, ermöglicht zum Beispiel die Rückführung von 240.000 Megawattstunden Abwärme pro Jahr. Mit dieser Menge kann man etwa 25.000 75-Quadratmeter-Wohnungen klimaneutral beheizen und mit warmem Wasser versorgen. Da 100 Prozent des bezogenen Stromes aus erneuerbaren Energien stammen, lassen sich dadurch rund 66.000 Tonnen CO₂ pro Jahr einsparen.
Interview: Ivette Wagner
Germany, nennt das „Ausspielen von Vorteilen“ eines inhabergeführten und spezialisierten Unternehmens. Dazu gehören Dialogbereitschaft, direkte Verhandlungen und kurze Wege. Damit sei man „unter den regulatorischen Anforderungen des Energieeffizienzgesetzes und des Themas ESG hervorragend positioniert, um in Deutschland von dem dynamisch wachsenden Markt für Cloud Computing und der digitalen Transformation überproportional zu profitieren“. So selbstbewusst, so gut. Savills untersuchte als Beratungsunternehmen in seiner Impact-Studie 13 Immobilienmärkte – darunter Australien, China, Frankreich, Großbritannien, Indien, Japan, Kanada, Südkorea und natürlich Deutschland – und sieht neben Pflegeimmobilien und Studentenwohnen auch sehr viel Potenzial bei Rechenzentren. Demnach werden allein in diesen Ländern in den nächsten zehn Jahren rund 1,2 Milliarden Quadratmeter Fläche benötigt, um die wachsende Nachfrage nach diesen „alternativen“ Immobiliensektoren zu befriedigen. Bedeutet: bis 2033 circa 17 Millionen Pflegeheimbetten, 110.000 Megawatt Rechenzentrumskapazität sowie 18 Millionen Betten in Studierendenwohnheimen. „Die Investitionen in diese Assetklassen verzeichnen in den letzten zehn Jahren weltweit ein durchschnittliches jährliches Wachstum von 17 Prozent, während es bei den gesamten gewerblichen Immobilieninvestitionen bei etwa sieben Prozent lag. Wir wissen, dass momentan viel Kapital darauf wartet, in diese Märkte investiert zu werden. Allerdings mangelt es aktuell
IMMOBILIEN AKTUELL 67
NEUE ASSETKLASSEN
an entsprechenden Portfolios, die das in großem Umfang ermöglichen“, sagt Marcus Roberts, Head of Europe Operational Capital Markets bei Savills. Bereits 2021 hatte eine Studie des Research Centers for Financial Services der Steinbeis Hochschule im Auftrag der Landesbank BadenWürttemberg ergeben, dass 80 Prozent der befragten Investoren Rechenzentren für ein wichtiges Thema halten, 95 Prozent gingen damals bereits davon aus, dass Investitionen in diesem Bereich in den kommenden zehn Jahren am stärksten im Fokus stehen werden.
Zum einen steht auch für Rechenzentren positiv zu Buche, dass sie weitgehend unabhängig von Konjunkturzyklen sind, dazu kommen stabile Renditen. Nicht zu vernachlässigen ist laut den Experten von Savills der Fakt der Wärmeerzeugung und damit ein verstärkter Nachhaltigkeitsaspekt. Darauf Wert legt auch PREA, die eines der größten Rechenzentren in Berlin bauen und dafür eine DGNB-Platin-Zertifizierung anstreben: In Lichtenberg soll für etwa eine Milliarde Euro bis 2026 Bluestar entstehen mit „energieeffizienter Kühlung, dem Einsatz erneuerbarer Energien und einer sorgfältigen Nutzung der Abwärme“ sowie einer Leistung von 100 Megawatt. Dahinter steht das niederländische Family Office Van Caem. Mit der Leistung von Bluestar können rund zehn Millionen Office-Arbeitsplätze mit IT, Software und Daten versorgt werden. Insgesamt umfasst die Datacenter-Entwicklung von PREA 30.000 Quadratmeter flexibel aufteilbare IT-Fläche, die bei Bedarf real geteilt werden kann. Gabriel Khodzitski, CEO von PREA (siehe Interview auf Seite 70), sagt: „Der Wachstumstrend bei Rechenzentren ist ungebrochen. Insbesondere die Nachfrage nach Cloud-Diensten, der Boom des E-Commerce und des mobilen Arbeitens führt weltweit zu einem massiven Bedarf an IT-Kapazitäten. Die Digitalisierung ist einer der Anker der Wettbewerbsfähigkeit. Dieser Trend wird anhalten und da dieser Bedarf nicht über die bereits existierenden Rechenzentren gedeckt werden kann,
ergeben sich hier attraktive Investitionsmöglichkeiten für Investoren.“


Der Entwickler CyrusOne baut in Hanau: Da, wo früher ein Industriegebiet war, wird ein Campus mit zwei Gebäuden und insgesamt 18.000 Quadratmetern technischer Fläche sowie einer IT-Kapazität von 54 Megawatt entstehen. Mit der BREEAM-Zertifizierung Very Good, mit 94 Prozent Wiederverwertung des gesamten Abbruchmaterials, mit der Inbetriebnahme 2025.

Großer Appetit auf die Assetklasse

„Wir haben früh erkannt, dass uns die Ansiedlung von Rechenzentren dabei hilft, die Zukunft unserer Stadt nachhaltig wirtschaftlich erfolgreich aufzustellen, um Wohlstand für die Bürgerinnen und Bürger langfristig zu gewährleisten“, sagt Hanaus Oberbürgermeister Claus Kaminsky. Carl von Hessen, Head of Data Center Investments bei Aquila Capital, brachte es in einem Handelsblatt-Interview auf den Punkt: „Die Investoren haben großen Appetit auf die Assetklasse Rechenzentrum.“
Bremsen könnten diese Erfolgsaussichten – wie in fast allen Bereichen – die Fachkräfte. Eine Studie von BCS, für die mehr als 3.000 Experten befragt worden, zeigt, dass 96 Prozent davon ausgehen, dass es zu einem weiteren Rückgang des Personalangebotes kommen wird. Im Sommer 2022 waren dies lediglich 91 Prozent. „Wir arbeiten in einem internationalen Umfeld und suchen auch international nach Verstärkung. Weil die Branche aber global boomt, ist es schwierig, geeignetes Personal außerhalb von Deutschland zu finden“, sagt Dr. Alexandra Thorer, General Manager von BCS Germany. Die Lösung könnte die Förderung branchenfremder Arbeitskräfte sein. Dazu komme ein Mangel an qualifizierten Bauunternehmen, der ebenfalls gelöst werden muss.
 Ivette Wagner
Ivette Wagner
IMMOBILIEN AKTUELL 68 SCHWERPUNKT:
ASSETKLASSEN
NEUE
Quelle: PwC Datacenter Outlook 2021
Quartier als neue Assetklasse?
IMMOBILIEN AKTUELL (IA): Wird das Quartier zu einer neuen Assetklasse?
Alexander von Erdély (AvE): Wir sehen, dass immer mehr Projektentwickler und Investoren ein Interesse an großen Entwicklungen zeigen, bei denen nicht nur verschiedene Immobilien und Nutzungsklassen kombiniert werden, sondern bei denen auch der öffentliche Raum und das erfolgreiche langfristige Management eines solchen Quartiers eine Rolle spielen. So erwarten viele Investoren, durch das Management eines Quartiers Werte realisieren zu können, die über die Summe der einzelnen Werte hinausgehen. Zudem bietet die Vielschichtigkeit eine wichtige Diversifikation, bei der das Investment nicht von einer einzelnen Nutzungsklasse abhängt. Wir können aber auch jenseits von großen Quartieren den Trend beobachten, dass Investoren auf Beimischungen größeren Wert legen. Beispielsweise Gastronomie und Fitnessstudio im Büro und Wohnen mit ein wenig Einzelhandel und einer Kindertagesstätte. Die Grenzen der Assetklassen verschwimmen. Ob es das Quartier als eigenständige Assetklasse geben wird, ist deswegen unklar.

IA: Wie definiert sich ein Quartier?
AvE: Der Quartiersbegriff ist von vielen unterschiedlichen Perspektiven
geprägt. Quartiere sind grundsätzlich multidimensional zu verstehen. Sie sollten funktional in den umliegenden Stadtraum integriert sein und ihre einzelnen Bestandteile müssen miteinander verknüpft sein. Wichtig bei der Definition ist deswegen, dass bei dem Erfolg von Quartieren zunächst der langfristige Einfluss auf die Bevölkerung sowie die Städte im Mittelpunkt steht. Ein derart erfolgreicher urbaner Raum wird sich dann auch für die Investoren rentieren. Für den Erfolg ist aber vor allem die Anordnung der Nutzungen wichtig, damit sich diese im Idealfall ergänzen und nicht gegenseitig behindern. Vergleichbar zum Sortiment im Supermarkt, das regelmäßig immer in einer bestimmten, wohl durchdachten Anordnung zu finden ist.
IA: In den letzten Jahren ist das Wort eher zu einem Vermarktungsbegriff geworden, oft fehlte es dann bei näherer Betrachtung an Substanz. Würden Sie dem zustimmen?
AvE: Ja, diese Entwicklung beobachten wir bereits seit einigen Jahren. Die Gefahr dabei ist eine Überstrapazierung des Begriffes, der zu einer Ermüdung führen kann. Dabei brauchen wir als Gesellschaft bei der Entwicklung lebenswerter Quartiere einen langen Atem. In Kopenhagen begann man vor
50 Jahren die Stadt umzubauen. Und erst seit einigen Jahren gilt die Stadt nun als eine der lebenswertesten der Welt.
IA: Aktuell stehen viele Baukräne still: Quartiere sind sehr komplex, auch schon in der Planung. Glauben Sie, dass die derzeitigen Umgebungsvariablen das Quartier in das Hintertreffen geraten lassen?
AvE: Nein, davon gehe ich nicht aus. Zwar sind Investoren am Immobilienmarkt zurückhaltender geworden – gerade auch bei großvolumigen Investments. Aber das ist nur eine Momentaufnahme. Hochwertige Produkte, die sich durch Diversifikation, Nachhaltigkeit und Vielseitigkeit auszeichnen, können sogar von einem anspruchsvoller werdenden Kapital profitieren. Investoren und Entwickler, die auf Quartiere setzen, wissen von Anfang an, dass es sich um langfristige Investments handelt, bei denen das Management nach der Fertigstellung eine große Rolle spielt und die ihre Stärken oft erst nach vielen Jahren richtig entfalten. Dieses Kapital ist mehr an langfristigen und nachhaltigen Renditen interessiert und muss deshalb eben nicht beim ersten rauen Wind gleich die Segel reffen oder den Kurs ändern.
Interview: Ivette Wagner
IMMOBILIEN AKTUELL 69 SCHWERPUNKT: NEUE ASSETKLASSEN
Alexander von Erdély, CEO des Immobiliendienstleistungs- und InvestmentUnternehmens CBRE, beantwortet diese Frage und definiert den Begriff, der oft überstrapaziert wird.
„Wir beteiligen uns an der Stadtreparatur“
Chris-Norman Sauer, Acquisitions Director Germany bei Premier Inn, spricht über Investitionen in die einzelnen Standorte, über die Expansion, das Silverlining, den Vorteil von Konversionen und über Berlin als Destination.



IMMOBILIEN AKTUELL (IA): 2016 wurde das erste Premier Inn in Deutschland eröffnet. Wie sieht die Expansionsstrategie für 2024 aus?
Chris-Norman Sauer (CNS): Für 2024 haben wir derzeit knapp zehn Projekte in der Pipeline, fünf davon sind Bestandshäuser, die wir zu Premier Inns machen, drei sind klassische Developments. Damit steuern wir auf insgesamt 60 Häuser in Deutschland mit über 11.000 Betten zu. Wir sind ein stark gerateter Partner, da wir finanzund eigenkapitalstark sind und kaufen auch weiter ein.
IA: Was macht einen Standort für Ihr Unternehmen interessant?
CNS: Wir haben für Deutschland 75 Städte definiert, die für uns in Frage kommen. Dazu gehören natürlich die Top7, aber auch kleinere, wie Flensburg, Konstanz, Münster und Bonn. In Hamburg haben wir momentan sechs Häuser, sehen dort aber auch noch Potenzial. In Rosenheim eröffnen wir 2024, in Lübeck eröffnet im gleichen Jahr das zweite Haus. Im Fokus sind zentrale Lagen in den Innenstädten, in Dienstleistungs- und Büroquartieren, an Messegeländen oder Verkehrsknotenpunkten. Neubau und Konversionen kommen für uns gleichermaßen in Frage, genau wie Kauf und Miete. Wir benötigen zwischen 100 und 400 Zimmer und eine Bruttogeschossfläche zwischen 3.500 und 12.000 Quadratmetern.
IMMOBILIEN AKTUELL
70 MACHER & MÄRKTE
IA: Die Hotelbranche hat harte Zeiten hinter sich. Wie schauen Sie derzeit auf den Markt?
CNS: 2023 lief und läuft sehr gut. Das zeigt sich an den hohen Average Room Rates (ARR) und der guten Auslastung. Natürlich müssen alle Akteure sehr stark auf die Inflationsspirale aus steigenden Löhnen, Lebensmittelpreisen und Energiekosten schauen. Es ist wichtig, dass die Bottomline nicht abschmilzt. Wir müssen uns sehr stark der Digitalisierung und der Prozessoptimierung widmen. Uns als Premier Inn helfen dabei die Skaleneffekte, die wir allein durch unsere Größe haben.
IA: Mitte Juni 2023 eröffnete in Dresden das 50. Premier Inn in Deutschland. Neben der Jubiläumszahl hat das Projekt noch eine ganz andere Besonderheit: Das Haus war früher ein Kaufhaus. Was genau wurde da gemacht?
CNS: Das Haus befindet sich direkt im Zentrum auf einer der großen Einkaufsstraßen. Früher befand sich dort ein Bekleidungskaufhaus. Das wurde abgerissen, diese Lücke mit einem Neubau geschlossen. Es ist ein klassisches Mixed-Use-Konzept: Die Rezeption ist in der fünften Etage, die Zimmer darunter. Im Erdgeschoss gibt es Retailflächen. Premier Inn sieht sich bei ähnlichen Entwicklungen und auch bei Bestandssanierungen als Partner der Städte, und wir beteiligen uns auch als Investor aktiv an der Stadtreparatur.
IA: Ist Bestandskonversion das Prozedere der Zukunft?
CNS: Für uns ist sie vor allem die Chance, unsere Vorstellung von Expansion umzusetzen. Zudem zahlt sie auf eine nachhaltige Entwicklung des Unternehmens und der Standorte ein. Im Neubau müssen wir drei oder vier Jahre warten, bis Häuser eröffnen können. Bei Bestandsgebäuden brauchen wir im Idealfall nur wenige Monate bis dahin.
IA: Wie schwierig ist es in der aktuellen Situation Neubauentwicklungen zu akquirieren?
CNS: Die Immobilienbranche ist derzeit schwer gebeutelt, und das trifft
vor allem Developer, bei denen wir wohl noch einige Insolvenzen sehen werden. Baukosten, Finanzierungen und vor allem die Exitfaktoren haben sich stark verändert. Für uns ist der Grundstückskauf derzeit interessanter geworden, wenn wir dann gleichzeitig auch als Investor auftreten. Es gibt wieder die Möglichkeit eine Exklusivität für Ankaufprüfungen zu vereinbaren. Außerdem gibt es keine langen Schlangen mehr. Wir haben also häufig wieder Zeit für eine intensive und detaillierte Due Diligence. Wir sehen das Silverlining, wir sehen aber auch, wie schwierig es für Developer ist zu rechnen.
IA: Das Problem ist also das Pricing?
CNS: Für uns nur zum Teil, da wir anders herangehen als institutionelle Investoren und die Projektentwickler. Es muss natürlich in die Renditestrategie passen, wir sind aber als vertikal integrierter Konzern flexibler. Vor allem, wenn wir selbst entwickeln, betreiben und langfristig halten, sieht diese Mischkalkulation anders aus, als wenn an jeder Stelle eine weitere Partei mitverdienen muss. Allerdings müssen auch wir viele Angebote ablehnen, weil sie sich für uns noch nicht rechnen. Die Grundstückskaufpreise sind oftmals nicht genug gesunken, um die anderen Effekte wieder auszugleichen.
IA: Berlin ist eine der ImmobilienHochburgen Deutschlands: Premier Inn hat dort bereits vier Projekte, ein weiteres ist im Bau. Wie sexy ist die Hauptstadt für Ihr Unternehmen?
CNS: In Berlin setzen wir derzeit noch zwei Konversionen um, dann haben wir sechs Häuser. Wir können uns aber deutlich mehr vorstellen. Es ist ein sehr guter Markt, mit einer starken Performance, immerhin mit etwa 30 Millionen Übernachtungen im Jahr. Uns interessieren natürlich Standorte in der Innenstadt, aber auch Stadtteillagen wie Spandau. In Köpenick wird es ebenfalls ein Projekt geben, da ist der Vertrag bereits unterzeichnet und die Neuentwicklung hat begonnen, das Haus eröffnen wir aber erst in etwa zwei bis drei Jahren.
Interview: Ivette Wagner www.premierinn.de


IMMOBILIEN AKTUELL 71 MACHER & MÄRKTE
Schrumpfung
Im Gespräch mit dem Immobilienökonom
Professor Dr. Günter Vornholz wird das wenig beachtete Phänomen des Leerstandes thematisiert. Er befürchtet eine Abwärtsspirale und abgehängte Regionen.

IMMOBILIEN AKTUELL (IA): Sie waren seit 2011 als Professor an der EZB Business School tätig und arbeiten seit diesem Jahr als Analyst und selbständiger Berater für die Immobilienwirtschaft. Während landauf, landab der Wohnungsmangel beklagt und Neubau gefordert wird, befassen Sie sich derzeit mit dem Leerstand. Hat Deutschland da ein Problem?
Prof. Günter Vornholz (GV): Ja, ein gesamtdeutsches: Mangel auf der einen Seite, Leerstand auf der anderen. Es gibt einzelne Regionen, in denen besonders viel Wohnraum leer steht, im Osten wie im Westen. Der Westharz, das Saarland und der Bayerische Wald sind Beispiele sowie vor allem ländliche Regionen im Osten. Spitzenreiter ist Sachsen-Anhalt. Aber auch Städte wie Frankfurt an der Oder sind betroffen. Dort liegt der Leerstand bei mehr als neun Prozent. empirica weist einen Leerstand von 607.000 marktaktiven Geschosswohnungen in Deutschland aus. Da sind aber zum Beispiel Ein- und Zweifamilienhäuser nicht erfasst und auch keine auf Dauer leerstehenden Plattenbauten. Ich schätze, der Leerstand liegt eher im Bereich von 1,5 Millionen Wohneinheiten. Genaueren Aufschluss werden die Zahlen des Zensus 2022 liefern.
IA: Die Bevölkerung in Deutschland wächst. Können diese Regionen davon profitieren?
GV: Danach sieht es langfristig nicht aus, eher nach einer Abwärtsspirale. Der demografische Wandel wird zu weiterem Leerstand führen, wenn man eine normale Migration unterstellt, die Anzahl der Haushalte ab 2040
sinkt. Und es kommt noch dicker. Sogar in schrumpfenden Regionen wird neu gebaut. Moderne Wohnungen und Einfamilienhäuser finden Abnehmer. Zurück bleiben leere Bestandswohnungen. Die Schere zwischen Angebot und Nachfrage steigt also weiter – und mit diesem Problem werden weit mehr Regionen konfrontiert sein als heute. Das heißt: Immer mehr Regionen werden zu schrumpfenden Regionen mit steigenden Leerständen.
IA: Bereits im Herbst 2018 wurde eine Kommission namens Gleichwertige Lebensverhältnisse gegründet. Hat die Politik die Leerstandsproblematik ausreichend im Blick?
GV: Nein, vieles steht nur auf dem Papier. Behördenansiedlungen zum Beispiel haben bislang einen marginalen Effekt. Der Breitbandausbau kommt voran, aber langsam.
IA: Welche Lösungsansätze sehen Sie?
GV: Das 49 Euro-Ticket ist zumindest ein Ansatz, Menschen aus den teuren Großstädten zu einem Wohnungswechsel in ländlichere Regionen mit preisgünstigem Wohnraum zu bewegen. Auch für Geflüchtete wäre hier Wohnraum vorhanden. Unternehmen fänden bei einer Ansiedlung preisgünstigen Wohnraum für Mitarbeiter, anders als in Großstädten. Mit dem Pfund kann man wuchern. Es gibt Stellschrauben, die Wohnungsunternehmen selbst nutzen sollten: sanieren, modernisieren, Wohnungen bedarfsgerecht umbauen. Allerdings können in Regionen mit geringer Nachfrage nur Mieten erzielt werden, die erheblich niedriger liegen als in begehrten Regionen und Großstädten. Steigende Anforderungen, Baukosten und Zinsen sowie gleichzeitig steigender Leerstand schränken die Investitionsfähigkeit ein. Und wir wissen jetzt noch nicht, wie sich das Gebäudeenergiegesetz auswirken wird. Klimagerechten Gebäudebestand gibt es nicht umsonst. Es steht am Ende die Frage, ob jemand bereit ist, die alten Wohnungen in schrumpfenden Regionen abzureißen und wer die Kosten trägt. Vielleicht wird ein großes Programm gebraucht wie beim Stadtumbau Ost. Derzeit werden Wohnungsunternehmen mit diesem Problem allein gelassen.
Interview: Mara Kaemmel
IMMOBILIEN AKTUELL 72 MACHER & MÄRKTE
Mit Schweizer Präzision
Die Swiss Property AG ist spezialisiert auf mehrgeschossigen Holzwohnungsbau mit eigener Software-Technologie und damit neuerdings auch auf dem deutschen Markt aktiv. Welche Pläne sie hier verfolgt.


Noch führt Holz auf den Baustellen in Deutschland eher ein Nischendasein. Zwar liegt die Holzbauquote, also die Anzahl der genehmigten Wohnhäuser, die überwiegend mit dem natürlichen Rohstoff errichtet werden, bei Ein- und Zweifamilienhäusern derzeit bei 26 Prozent. Beim mehrgeschossigen Wohnungsbau, so das Bundeslandwirtschaftsministerium, erreichte sie aber noch nicht einmal die Marke von fünf Prozent. Dass der Bund dieses Potenzial mit einer Holzbauinitiative schließen will, ist Wasser auf die Mühlen der Swiss Property AG.
Anfang 2014 gegründet, sieht sich das Unternehmen aus Zürich als Spezialist für das Bauen mehrgeschossiger Wohngebäude mit Holz. Als Referenz dienen unter anderem bereits realisierte Um- und Neubauvorhaben mit Fokus auf Eigentumswohnungen in den Schweizer Gemeinden Andermatt und Göschenen. „Der Schweizer Holzbau ist in Europa führend und wird im Zuge einer nachhaltigkeitsorientierten Weiterentwicklung der Immobilienbranche enorm an Relevanz gewinnen“, ist CEO Johannes May überzeugt.
Seit Frühjahr 2023 agiert Swiss Property auch mit einer eigenen Niederlassung in Deutschland. Von MünchenBogenhausen aus will der Entwickler seine langfristige Wachstumsstrategie vorantreiben und dabei ebenfalls das Produktportfolio erweitern. So soll insbesondere institutionellen Investoren die Beteiligung an Projekten und Holzbauimmobilien in Form von Club-Deals und Immobilienfonds ermöglicht werden. Verantwortlich für die deutsche Expansion zeichnen Henrik Fillibeck und Axel Trescher, beides langjährige Immobilien-Investmentprofis. Henrik Fillibeck, zuvor Sprecher des Vorstandes bei Catella Real Estate, sagt: „Holzwohnungsbau ist in Deutschland noch unterrepräsentiert. Mit Erfahrung und Know-how sowie
unserer Schweizer Unternehmenskultur haben wir eine hervorragende relative Wettbewerbsposition.“
Nach eigenen Angaben betreut Swiss Property fertiggestellte und laufende Projekte mit einem Gesamtvolumen von 630 Millionen Euro. Das deutsche Premierenvorhaben befindet sich im Frankfurter Nordend-West. Es handelt sich um die energetische Generalsanierung eines Mehrfamilienhauses mit zehn Wohnungen aus dem Jahr 1957. Im Hof soll zudem ein pavillonartiger, vierstöckiger Anbau in Holzbauweise entstehen, der die Wohnräume des Bestandes erweitert. Vertikale Holzlamellen im Bereich der Fassadenöffnungen gehören ebenso zum Konzept wie eine Begrünung der Gebäudehülle. Die Fertigstellung erfolgt nach aktuellem Stand im Sommer 2025. Verschiedene weitere Projekte und Grundstücke im süddeutschen Raum – also genau dort, wo die Holzbauquote bei Wohngebäuden in Deutschland vergleichsweise hoch ist – werden derzeit geprüft. Dabei immer im Fokus: „eine signifikante Reduzierung von grauen Emissionen bereits bei der Errichtung“, so Henrik Fillibeck. Neben Projektentwicklungen gehören strategische Partnerschaften und Joint Ventures, Immobilienmarketing und -verkauf zum Geschäftsmodell des Holzbauers, der sich überdies einen aktiven Beitrag zur Digitalisierung in der Bauindustrie auf die Fahnen geschrieben hat. Dazu stellt Swiss Property unter der Marke vyzn eine browserbasierte Onlineplattform bereit. Diese soll den manuellen Aufwand für die Planung zukunftsfähiger Gebäude um bis zu 50 Prozent reduzieren. Etwa, indem sie bei Projekten die einzelnen Anwendungen beteiligter Experten zu Energie, Statik und Schallschutz in einem Referenzmodell integriert. Ein Leitspruch: „Ganzheitliche Optimierung auf Basis gemeinsamer Daten.“ Matthias Klöppel
IMMOBILIEN AKTUELL 73 MACHER & MÄRKTE
Die Renaissance der Makler
Immobilien verkaufen sich nicht mehr von allein, denn Finanzierungen sind teurer und Käufer rarer geworden. Jetzt sind wieder Makler mit Verkäufertugenden, Marktkenntnis und Zugang zu Interessenten gefragt.

Für Sparer waren die raschen Zinsanhebungen der EZB ein Segen, für Immobilienverkäufer und Kaufinteressenten ein Fluch. Der inzwischen auf den höchsten Stand seit 15 Jahren gestiegene Leitzins hat die Kreditnachfrage und das Transaktionsgeschehen kräftig ausgebremst. Nach JLL-Berechnungen sank die Zahl der Transaktionen 2022 um 41 Prozent gegenüber dem Vorjahr. Hinzu kommt: Durch die gesunkene Nachfrage fallen die Immobilienpreise. Bis zu zehn Prozent Rückgang prognostiziert das Deutsche Institut für Wirtschaftsforschung (DIW) für 2023.
Makler gewinnen Marktanteile
In dieser Situation schlägt die Stunde der Makler. Viele Eigentümer, die ihre Immobilien zunächst privat anboten, mussten feststellen, dass die Vermarktung nicht mehr so einfach ist wie gedacht – und beauftragten einen Makler.
„Der Makler-Marktanteil an den zum Verkauf angebotenen Wohnimmobilien legte im ersten Quartal 2023 gegenüber dem Vorjahresquartal deutlich zu“, sagt Professor
Stephan Kippes, Leiter des IVD-Marktforschungsinstitutes. „Im Durchschnitt der Top7-Immobilienmetropolen wurden 79 Prozent der Immobilien zwischen Januar und März 2023 über den Makler angeboten, im Vorjahreszeitraum waren es noch 76 Prozent.“
Nicht nur in den Top7, auch bundesweit steigt die Maklerquote. Bis Ende Mai war sie laut einer Analyse von Sprengnetter auf 68,1 Prozent geklettert. „Nachdem der Markt Ende 2022 mit Anzeigen von Privatverkäufern überschwemmt wurde, ist das eine klare Trendwende“, kommentiert COO Christian Sauerborn die Entwicklung.
Konsolidierungswelle erwartet
Doch der steigenden Zahl an Verkaufsaufträgen steht eine sinkende Zahl an Kaufinteressenten gegenüber. Wegen der rasant gestiegenen Finanzierungskosten können sich immer weniger Menschen eine Immobilie leisten. Für freiberufliche Makler, kleine Vermittlerbüros und junge PropTechs wird es daher deutlich schwieriger, sich gegen Wettbewerber mit
MACHER & MÄRKTE
vielen Niederlassungen und großem Kundenstamm wie Engel & Völkers, VON POLL IMMOBILIEN oder RE/MAX zu behaupten. Die Kleinen müssen nicht nur mit weniger Abschlüssen klarkommen, sondern wegen sinkender Immobilienpreise auch mit niedrigeren Provisionen.

Obendrein drängen neue Konkurrenten auf den deutschen Markt, etwa das in den USA ansässige weltgrößte Maklernetzwerk Keller Williams, das bis zu 100 Center in Deutschland plant, der Schweizer Hybridmakler Neho, der nur 1,75 Prozent Provision von Käufer und Verkäufer verlangt, oder das französische Maklernetzwerk SAFTI Group, das 2022 mehr als 26.000 Transaktionen abwickelte. Marktbeobachter rechnen daher mit einer Konsolidierungswelle unter den kleinen Vermittlerbüros.
Die Strategien der Maklerunternehmen
Die veränderte Marktlage erfordert neue Strategien. Der Frankfurter Makler und Wertgutachter Ronny Kazyska rät kleinen Büros, einen zweiten Geschäftsbereich aufzubauen, der unabhängig vom Vermittlungsgeschäft stabile Umsätze generiert, etwa durch eine Weiterbildung zum Sachverständigen für Immobilienbewertung. Auch der Wiedereinstieg in das Mietgeschäft könnte ein zweites Standbein sein, denn der Mietwohnungsmarkt boomt.
Eine weitere Strategie sind Gemeinschaftsgeschäfte, bei denen sich Makler ihre Objekte und Kaufinteressenten gegenseitig zugänglich machen. So können sie mehr Objekte mit weniger Aufwand vermitteln und trotz geteilter Provisionen von schnelleren und häufigeren Abschlüssen
profitieren. Die Zusammenarbeit erfolgt über CRM-Lösungen, wie sie etwa der Softwareentwickler onOffice anbietet. Über diese Plattform teilten Makler 2022 rund 7.000 Immobilien. Von Januar bis Juli 2023 waren es schon 15.200. Eine andere Strategie verfolgt RE/MAX Germany. Das Unternehmen steigerte 2022 sein Vermittlungsvolumen durch mehr Standorte. Zudem bildet es seine Makler zu Modernisierungsexperten weiter. RE/MAX Germany-CEO Kurt Friedl erklärt: „Die Modernisierungsberatung bedeutet eine Aufwertung des Geschäftsmodells des Maklers, denn er vermittelt nicht mehr nur Immobilien, sondern zusätzlich die komplette energetische Sanierung.“ Und energetisch sanierte Immobilien verkauften sich schneller und teurer. Die David Borck Immobiliengesellschaft fokussiert sich auf Service und Mehrwert. „Wir wollen, dass die Kunden den besten Service genießen und sich gut beraten und gut aufgehoben fühlen“, betont Inhaberin Carin Rothmann. Der Mehrwert für den Kunden stehe stets im Vordergrund. Dieser Ansatz brachte dem Unternehmen im Mai 2023 bereits das siebte Top-Makler-Siegel des Focus Immobilienreportes ein. VON POLL IMMOBILIEN wiederum investierte 2022 siebenstellig in die digitale Transformation und konnte so die Auftragsquote und die Kundenzufriedenheit steigern. „Hybridmakler und traditioneller Makler verschmelzen zunehmend“, konstatiert Chief Digital Officer Wolfram Gast. Die Weiterentwicklung von einem traditionellen zu einem digitalen und agilen Unternehmen garantiere die nötige Wettbewerbsfähigkeit. Wolfram Gast ist überzeugt: Neben der persönlichen Beratung ist der Einsatz innovativer Technologien „der neue Standard bei der Immobilienvermittlung“.
Frank Baecke
IMMOBILIEN AKTUELL 75
& MÄRKTE
MACHER
85,1 83,0 80,5 76,7 76,4 75,5 74,6 83,6 75,3 76,4 76,2 73,0 72,7 72,4 Berlin Düsseldorf München Hamburg Stuttgart Köln Frankfurt a. M. +5,4% +1,8% +10,2% +0,7% +4,7% +3,8% +3,1%
Quelle: IMV, IVD-Institut 0 20 40 60 80 100 2022 2023
Makler-Anteil bei Wohnimmobilien zum Kauf in den Big7 Angabe in Prozent, jeweils 1. Jahresquartal (Jan. – Mrz.)
IMMOBILÉROS – DER Podcast für die Immobilienbranche
IMMOBILÉROS versammelt alle sieben Tage das Who is Who der Immobilienwirtschaft vor dem Mikrofon und diskutiert die brennendsten Fragen. Vier spannende Podcasts des laufenden Jahres möchten wir Ihnen hier kurz vorstellen.
notiert von Pierre Pawlik
Dieter Becken, geschäftsführender Gesellschafter der Becken Holding GmbH, analysiert gemeinsam mit IMMOBILÉRO Michael Rücker die aktuelle Krisenlage und erläutert, was getan werden muss, damit die Immobilienbranche wieder auf die Beine kommt: „Wann es wieder aufwärts geht? Vor 2025 wird gar nichts passieren. Es gibt wichtige Voraussetzungen, die zunächst erfüllt sein müssen. Es geht erst dann weiter, wenn sich die Zinsen verändern, die Inflationsrate eine andere ist und die Baukosten sich wieder stabilisieren. Es wird weitergehen, davon bin ich sehr wohl überzeugt. Das wird aber zwei bis vier Jahre dauern – das ist Fakt.“


Zukunftstrends der Projektentwicklung
Mit Alexander Sälzle (links im Bild) und Roderick Rauert (rechts) von der Münchner Bauwerk Capital GmbH & Co. KG taucht Michael Rücker tiefer in das Thema Projektentwicklung ein und fokussiert mit den Branchenkennern auf die drei großen Zukunftstrends im Development. Anhand konkreter Bauwerk-Projekte geht es um:
• neue Raumkonzepte in der Architektur,
• das Bauen mit Holz und
• energieautarke Büroimmobilien.


IMMOBILIEN AKTUELL 76 MACHER & MÄRKTE
„Wir steuern auf eine Wohnungsnot zu, wie sie noch nie dagewesen ist“
Dr. Alexander Rosa-Alscher, Gründer der ROSA-ALSCHER Group, blickt mit IMMOBILÉRA Ivette Wagner im Podcast meinungsstark auf das, was in Deutschland nicht funktioniert:


„Wenn der Staat sich einschaltet, dann läuft das schief. Ich kenne keinen einzigen Fall, wo der Staat ordentlich gearbeitet hat. Wenn Sie sich mal die Tendenzen anschauen mit der Sozialgerechten Bodennutzung (SoBoN) in München – das hilft keinem Investor. Der kann für sein Geld weder das Grundstück kaufen, noch kann er die Baukosten bezahlen. Und wenn wir in sozialistisch-kommunistische Strukturen abschweifen, dann blockieren wir die Investments.“
Nachhaltigkeit in der Immobilienbranche
Den Satz „Jetzt haben wir das fertig, das Projekt der Nachhaltigkeit“, werde man so wohl nie hören, sagt Mareike Haak, Standortkoordinatorin Westfalen und Nachhaltigkeitsbeauftragte Nordrhein-Westfalen bei Drees & Sommer (links im Bild) im Gespräch mit Ivette Wagner. Gemeinsam klären sie die Frage, warum es in Deutschland mit den hehren Zielen – nicht nur bei Mareike Haas‘ Herzensangelegenheit, der Nachhaltigkeit – nicht so wirklich funktionieren will. Entsprechend geht es um:
• die Umsetzung der Nachhaltigkeit in der Immobilienbranche und die damit verbundenen Probleme,

• Cradle to Cradle,
• ein Plädoyer gegen den Abriss und
• Stranded Assets.

IMMOBILIEN AKTUELL 77 MACHER & MÄRKTE
„Wir sind nicht die Leibeigenen der Politik.“
www.immobileros.de Jetzt reinhören!
Wachablösung und Investitionshunger
Auf dem Markt für Gesundheitsimmobilien steigt das Betreute Wohnen immer mehr in der Gunst der Investoren – auf Kosten des Platzhirsches. Doch auch diese Nutzungsart kämpft mit dem riesigen Delta zwischen Angebot und Nachfrage.
So viel Zuhause wie möglich, so viel Betreuung wie nötig: Die Nachfrage nach seniorengerechten Einrichtungen mit Serviceleistungen ist bundesweit unverändert hoch und nimmt weiter zu. Auf dem Markt für Gesundheitsimmobilien führt dieser Trend dazu, dass sich dieser Objekttyp immer größere Marktanteile erobert. Nach Angaben von Cushman & Wakefield entfiel auf das Betreute Wohnen im ersten Jahresviertel 2023 ein Transaktionsvolumen von knapp 190 Millionen Euro. Für klassische Pflegeheime, dem dominierenden Subsegment innerhalb der Assetklasse, seien es etwa 75 Millionen Euro gewesen. Damit hätten Seniorenwohnungen mit Betreuung den Bereich Pflegeheime als umsatzstärkste Nutzungsart der Gesundheitsimmobilien abgelöst.
Nun sind Quartalszahlen nur eine Momentaufnahme, sie stehen aber symptomatisch für den seit längerer Zeit zu beobachtenden Bedeutungsgewinn des Betreuten Wohnens. Einen weiteren Beleg dafür liefert eine Umfrage des auf stationäre Pflegeimmobilien spezialisierten Bestandshalters Cureus GmbH. Danach halten 43 Prozent der kommunalpolitischen Entscheider das Betreute Wohnen für die geeignetste Immobilienart, um in ihrem Landkreis respektive ihrer kreisfreien Stadt den Bedarf an Pflegeplätzen zu decken. Lediglich 31 Prozent ziehen die stationäre Pflege vor.

Kein Betreiber – weniger Risiko
„Die heutige Senioren-Generation ist sehr aktiv und setzt auf ein selbstbestimmtes Leben“, begründet Christina Kainz, Co-Gründerin des noch jungen Anbieters lively, die zunehmende Präferenz für offene Senioren-Wohnkonzepte. Im Hinblick auf das Transaktionsgeschehen sehen Marktbeobachter einen weiteren Grund in der geringeren Abhängigkeit von Betreibern. „Einige Investoren haben aufgrund der temporären Entwicklungen und Herausforderungen für Pflegeunternehmen Vorbehalte gegenüber Betreiberimmobilien“, sagt Jochen Zeeh, Geschäftsführer der Beratungsfirma IMMOTISS. Fälle wie die Insolvenz
der Bremer Convivio Gruppe, die mehr als 100 Standorte im Portfolio hat, haben die Unsicherheit seit Anfang 2023 wachsen lassen. Gleichwohl, so Jochen Zeeh, gebe es am Markt auch ein großes Interesse durch andere Betreiber, von Pleiten betroffene Objekte zu vergleichbaren Konditionen zu übernehmen. Dass Angebote des Betreuten Wohnens derzeit besser zu den Risikoprofilen vieler Investoren passen, liegt darüber hinaus an ihrer Drittverwendungsfähigkeit. So sind für intelligent konzipierte Objekte Nachnutzungen aus dem Hotel-, Wohn- und Gesundheitsbereich meist ohne Weiteres denkbar.
Nachfragedruck und Versorgungslücke
Die wachsende Beliebtheit des Betreuten Wohnens hängt auch mit Deutschlands fast auf dem Kopf stehender Alterspyramide zusammen. Weitere Spezialimmobilien zur Pflege und Betreuung älterer Menschen werden schlichtweg dringend benötigt – und das noch auf Jahrzehnte hin. So geht das Statistische Bundesamt davon aus, dass die Zahl der Menschen über 67 hierzulande von 16,5 Millionen im Jahr 2022 auf 21 Millionen bis 2040 zunehmen wird, die der über 80-Jährigen sogar von sechs auf zehn Millionen.
„Der Versorgungsengpass wird sich weiter verschärfen, denn der demografische Wandel trifft auf ein stagnierendes Angebot an Seniorenimmobilien und eine veränderte Pflegesituation“, warnt Jochen Zeeh von IMMOTISS. Ihm zufolge besteht schon jetzt eine Versorgungslücke von 385.000 Einheiten für hilfsbedürftige Menschen. Bundesweit rund 555.000 Einheiten für Betreutes Wohnen sowie etwa 915.000 stationären Pflegeplätzen stünden demnach gut 1,85 Millionen Frauen und Männer über 65 Jahre mit
IMMOBILIEN AKTUELL 78 MACHER & MÄRKTE
Pflegebedarf gegenüber. „Und das ist noch konservativ gerechnet“, so Jochen Zeeh. „Es gibt unglaublich viel zu tun.“

Die Daten von bulwiengesa bestätigen diese Einschätzung. „Seit 2019 wurden im Schnitt jährlich rund 7.500 Pflegeplätze in 90 Pflegeeinrichtungen sowie 4.000 Wohneinheiten im Servicewohnen in etwa 200 Wohnanlagen fertiggestellt“, berichtet Projektleiterin Sabine Hirtreiter. Erforderlich seien indes bis 2040 pro Jahr zusätzliche 20.700 Pflegeplätze respektive 26.1000 Seniorenwohnungen mit Betreuung. Diese Lücke zu füllen, erscheine angesichts der momentanen Zäsur in der Neubauaktivität nicht realisierbar. Hinzu käme laut Sabine Hirtreiter, dass neue Einrichtungen oft nicht dort entstehen würden, wo der Bedarf am höchsten sei, sondern dort, wo Bauen noch rentabel sei.

Der Staat muss fördern
Zur Verkleinerung des Deltas zwischen Angebot und Nachfrage, bedarf es laut vielen Akteuren des Gesundheitsimmobilienmarktes weitreichender Unterstützung durch den Staat. „Der Bund muss für konkrete Lösungsvorschläge und finanzierbare Alternativen sorgen“, fordert Sebastian Deppe, Managing Partner von NAI apollo healthcare, „sonst laufen wir sehenden Auges in ein massives gesellschaftliches Problem hinein.“ Eine solche Alternative könnte eine Mindestquote für den Bau seniorengerechter Wohnungen bei der Ausweisung neuer Baugebiete sein, wie sie IMMOTISS-Chef Jochen Zeeh für vorstellbar hält. Am wirksamsten seien für ihn aber, die Refinanzierung der Baukosten zu stützen und Betreiber durch zügige Zuschüsse im Hinblick auf Inflation und Energiekosten zu stabilisieren.
 Matthias Klöppel
Matthias Klöppel
IMMOBILIEN AKTUELL 79 MACHER & MÄRKTE
IMMOTISS-Geschäftsführer Jochen Zeeh
Transaktionsvolumen und Spitzenrendite Gesundheitsimmobilien in Deutschland
Grafik: Cushman & Wakefield
„Neue Projekte sollen alte Problemlagen reparieren“
Die DLE Land Development GmbH erleichtert Bauträgern und Wohnungsunternehmen den Zugang zu Bauland, indem sie große, gemischt-genutzte Grundstücke erwirbt, parzelliert und bis zur Baureife entwickelt. Ein Gespräch mit Geschäftsführer
Dr. Simon Kempf über den Entwicklermarkt.

IMMOBILIEN AKTUELL (IA): Wie schätzen Sie den deutschen Entwicklermarkt aktuell ein?
Simon Kempf (SK): Projektentwickler in Deutschland haben es zurzeit nicht leicht. Zu den hohen Grundstücks- und Baukosten, dem Ukrainekrieg, der Inflation, dem Fachkräftemangel und der lange unklaren Förderkulisse kommen die massiv gestiegenen Finanzierungskosten, die Rezession, zunehmende Regulierung und abwartende Endinvestoren hinzu. Es gibt viele Gründe, warum die Zahl der Baugenehmigungen für Wohnungen so stark eingebrochen ist – lange Zeit wurden die Probleme ja vom NullZins-Niveau überdeckt. In der jetzigen Marktsituation profitieren wir als DLE Land Development davon, nicht von Fremdkapital abhängig zu sein. Denn
IMMOBILIEN AKTUELL 80 MACHER & MÄRKTE
eigentlich ist jetzt der richtige Zeitpunkt, die Weichen für Wohnungsbau, Zukunftsfähigkeit und Nachhaltigkeit zu stellen. Wir jedenfalls wollen neue Projekte entwickeln und großflächige Grundstücke für bis zu 200 Millionen Euro kaufen.
IA: Wie lassen sich denn neue Wohnquartiere in Wachstumsregionen entwickeln?
SK: Der Wohnraumbedarf wird in den Metropolen und im Umfeld wachstumsstarker Städte weiter zunehmen, nicht zuletzt aufgrund der demografischen Entwicklung. Die Nachfrage ist da, auch weil die Bevölkerungszahl mit fast 84 Millionen so hoch ist wie noch nie. Großes Flächenpotenzial für neue Wohnquartiere sehen wir vor allem in Konversionen früherer Industrie- und Gewerbeareale und Umwidmungen von geplanten Gewerbegebieten in zahlreichen deutschen Städten und Speckgürteln. Entscheidend für erfolgreiche Projektentwicklungen sind die passende Lage, ein standortgerechtes Quartierskonzept, eine gute Anwohnerkommunikation und die enge Abstimmung mit den Kommunen. Wenn dann noch schnell und effizient gebaut werden kann, lassen sich viele Projekte auch zu tragbaren Kosten realisieren. Generell wäre ein Abbau der zahlreichen Hemmnisse auf allen politischen Ebenen natürlich sehr förderlich für den Bau neuer Wohnungen.
IA: Was wünschen sich Städte und Kommunen, welche Konzepte und Ideen sind gefragt?
SK: Insbesondere bei größeren Quartiers- und Landentwicklungen wünschen sich viele Kommunen heute einen Mehrwert für die Gemeinde. Sie legen besonderen Wert auf Nutzungsmischung, Qualität, Klimaresistenz und Nachhaltigkeit. Auf den Wunschlisten der Kommunen stehen häufig Kitas, Schulen, öffentliche Plätze, medizinische Versorgung, Einkaufsmöglichkeiten oder auch Feuerwehren, wie zum Beispiel bei unserem 56 Hektar großen Projekt Königspark in Königs Wusterhausen bei Berlin. Nicht selten sollen neue Projekte alte Problemlagen ‚reparieren‘, etwa durch Ortskernentwicklung, Entsieglung, lokale Identitätsstiftung oder Entsorgung von Altlasten. Natürlich müssen dabei am
Ende Anforderungen und Wirtschaftlichkeit in Einklang stehen.
IA: Was macht nachhaltige Quartiere aus?

SK: Häufig wird Nachhaltigkeit auf ökologische Aspekte reduziert, dabei machen mehrere Aspekte nachhaltige Quartiere aus. Sicherlich müssen sie einen möglichst kleinen CO₂-Fußabdruck haben, basierend auf zielführenden Wasser-, Energie-, Baustoff-, Verkehrs- und Nutzungskonzepten. Was aus unserer Perspektive jedoch ebenfalls wesentlich für nachhaltige Quartiere und Projektentwicklungen ist, sind die Themen Anpassbarkeit und Aufenthaltsqualität. Nachhaltige Quartiere müssen lange genutzt werden und sich im Laufe der Jahrzehnte auch weiterentwickeln können – mehr Wohnen, weniger Gewerbe beispielsweise. Deshalb sind urbane Gebiete prädestiniert für möglichst nachhaltige Quartiere.
IA: Welche Regionen und Lagen sind für Sie als großflächigen Landentwickler interessant?
SK: Als DLE Land Development sind wir bundesweit aktiv, derzeit mit 42 Projekten und einer Entwicklungsfläche von rund vier Millionen
Quadratmetern Bruttogeschossfläche, was bis zu 30.000 Wohneinheiten entspricht. Wir erwerben große, gemischt-genutzte Grundstücke, entwickeln diese bis zur Baureife und geben sie dann parzelliert an Bauträger und Wohnungsunternehmen weiter. Unsere Projektpipeline umfasst unter anderem Projekte in Berlin, Königs Wusterhausen, Frankfurt am Main, Duisburg, Kerpen und Fürstenfeldbruck. Insofern sind für uns alle Regionen in Deutschland mit positiver demografischer und wirtschaftlicher Prognose interessant. Wir schauen uns die Nachfrage, das Angebot, die infrastrukturellen Herausforderungen und eventuelle Altlasten genau an. Da wir großflächig entwickeln, ist uns die Erreichbarkeit wichtiger als die Lage.
IA: Wann wird der Immobilienmarkt in Deutschland die Talsohle durchschritten haben?
SK: Der deutsche Immobilienmarkt wird auf absehbare Zeit schwierig bleiben. Vor Mitte 2024 hat sich auch der Transaktionsmarkt noch nicht wiedergefunden. Die Bautätigkeit wird anlaufen, wenn die Rahmenbedingungen für alle beteiligten Akteure wieder kalkulierbar sind.
Interview: Frank Baecke
IMMOBILIEN AKTUELL 81
& MÄRKTE
MACHER
Neu-Erfindung
Sinkende Umsätze, steigende Leerstände und fehlende Großabschlüsse – die schwierige Lage am Büromarkt geht nicht nur auf das Konto der aktuellen Rezession. Auch die Bedeutung der Arbeit und die Anforderungen an nachhaltige und zeitgemäß ausgestattete Office-Flächen wandeln sich rasant.
Der Markt für Büroimmobilien ist in raues Fahrwasser geraten. Neue Arbeitsmodelle, gewachsene Ansprüche der Nutzer, ein zunehmender Fokus auf Klima- und Nachhaltigkeitsstandards sowie ein schwieriges konjunkturelles Umfeld sorgen dafür, dass viele Kennzahlen am Büromarkt zurzeit nach unten zeigen.
Zwar sind die Büromieten bundesweit nach einer Studie des Institutes der deutschen Wirtschaft (IW) gegenüber dem Vorjahr um 5,9 Prozent gestiegen, unter Berücksichtigung der Inflationsrate ergibt sich aber ebenfalls ein realer Rückgang. Viele Büroimmobilien sind inzwischen zu wahren „Ladenhütern“ geworden – jedes vierte einschlägige Inserat ist 38 Wochen auf dem Markt. Vor allem Vermieter, deren Objekte im städtischen Umland oder im ländlichen Raum liegen, haben es zunehmend schwerer, diese an die Unternehmen zu bringen. Hier ermittelte das IW, dass es bei jeder vierten inserierten Büroimmobilie fast neun Monate dauert, bis ein Besitzerwechsel zustande kommt. Auf der anderen Seite hat sich an den sieben wichtigsten deutschen Bürostandorten die Tendenz sinkender Flächenumsätze verfestigt. Wie das Maklernetzwerk German Property Partners (GPP) analysierte, lag im ersten Halbjahr 2023 der Flächenumsatz der Top7 mit 1,11 Millionen Quadratmetern um 39 Prozent unter dem des Vorjahreszeitraumes. Die Eigennutzerquote sank von 13 auf vier Prozent. Hier gilt Small is beautiful: Der Trend geht eindeutig zur Anmietung kleinerer Flächen; Großverträge über 10.000 Quadratmeter werden derzeit so gut wie nicht mehr abgeschlossen.
Neue Normalität: Büro wird vom Arbeitszum Begegnungsort
Als Ursache für diese Entwicklung sieht GPP-Sprecher Andreas Rehberg neben der wirtschaftlichen Großwetterlage vor allem die Veränderungen in der Arbeitswelt, wodurch sich die Anforderungen an Büros innerhalb der zurückliegenden zwei bis drei Jahre deutlich verändert haben. IWImmobilienexperte Professor Michael Voigtländer bestätigt das: „Spätestens seit der Pandemie arbeiten wir anders als früher.“ Corona hat das Homeoffice endgültig salonfähig gemacht. Nach IW-Beobachtungen geht inzwischen jeder vierte Mitarbeiter mindestens einmal pro Woche vom heimischen Schreibtisch aus seinen Tätigkeiten nach. Im Gegenzug sank
die Auslastung der Büroflächen in Deutschland deutlich, wie der Workplace-Berater Combine Consulting ermittelte. Sie lag im Jahr 2022 bei rund 41 Prozent und damit 19 Prozent niedriger als vor Corona. Vor allem gemeinsame Besprechungsräume fristen nur noch ein Schattendasein. Ihre Auslastung sank von 40 auf nur noch sieben Prozent. Stichwort New Work: Nicht allein Homeoffice, sondern auch andere Arbeitsformen der Zukunft wie Co-Working, Hotdesking, Remote Work oder Jobsharing haben einen Paradigmenwechsel in Bezug auf Geschäftsmodelle und Arbeitsbedingungen eingeläutet– mit gravierenden Auswirkungen auf Größe, Ausstattung und Raumkonzepte von Büros. Diese wandeln sich zunehmend vom Arbeitszum Begegnungsort. Arbeitgeber stehen also zunehmend vor der Herausforderung, ihren Beschäftigten im Büro ein passendes Umfeld zu bieten, in dem diese bestmöglich kommunizieren sowie kreativ und kooperativ tätig sein können.
Hochpreisige Innenstadt oder Aufschwung für die Randlagen?
Neben einem gut ausgestatteten Büro schätzen Mitarbeiter am Arbeitsort eine attraktive Umgebung mit guter Anbindung an öffentliche Verkehrsmittel beziehungsweise nahe gelegene Parkmöglichkeiten. Dank ihrer Zentralität und guten Erreichbarkeit, aber auch ihrer vielseitigen Infrastruktur und ihrem Angebot an Service-, Einkaufs- und Freizeitmöglichkeiten punkten hier nach wie vor hochpreisige Innenstadtlagen mit hochwertigen Gebäuden. „Viele Unternehmen setzen bewusst auf Qualität und wollen daher nach wie vor in die Innenstädte, obwohl dort die Bau- und Ausbaukosten stark gestiegen sind“, beschreibt Andreas Rehberg die Situation. „Indem sie sich verkleinern, können sie sich einen besseren Standort leisten.“ Daran hätten selbst Mieten auf neuen Höchstniveaus bisher nichts geändert.
Die Tendenz, dass Firmen zunehmend ihre Standorte in Richtung ihrer Mitarbeiter und damit an den Stadtrand und ins Umland verlagern, kann GPP nicht bestätigen. Eine solche Entwicklung hatte das ifo Institut für Wirtschaftsforschung nach Auswertung von rund 502.000 Immobilienangeboten für 50 deutsche Metropolregionen vermutet.
IMMOBILIEN AKTUELL 82
BÜRO & LOGISTIK
Die Wissenschaftler ermittelten gestiegene Mietpreise für Büros an den Stadträndern (plus elf Prozent) und in den Speckgürteln der Büro-Metropolen (plus 15 Prozent) und leiteten daraus eine gewachsene Nachfrage nach Büroflächen in diesen Lagen ab.
Wie geht es weiter?
Die meisten Analysten sind sich einig, dass Leerstände und Renditen zunächst weiter ansteigen werden, bevor sich ab 2024 erste Konsolidierungstendenzen zeigen werden – zumindest an den fünf deutschen Top-Büromärkten. Diese Erwartung äußern beispielsweise die an der gif / CRESConsensus-Büromarktprognose für das erste Quartal 2023 beteiligten Researcher. Ab 2024 werden in den Top5 – Berlin,
Düsseldorf, Frankfurt am Main, Hamburg und München –stabile Spitzenmieten und Renditen dafür sorgen, dass sich die Kapitalwerte für Büroimmobilien wieder konsolidieren, nachdem sie im bisherigen Verlauf des Jahres 2023 nachgegeben hatten. Grüne und nachhaltige Bürogebäude sind und bleiben Trumpf: Wie CBRE herausgefunden hat, erwirtschaften Büroimmobilien mit einer Green Building-Zertifizierung europaweit etwa sechs Prozent höhere Mieten und verzeichnen einen um zwei Prozent niedrigeren Leerstand. Gerade deutsche Standorte haben hier aber noch Nachholbedarf: Lediglich Frankfurt am Main liegt mit 20 Prozent Green-Building-zertifizierter Gebäude im europäischen Durchschnitt. In Berlin (sieben Prozent), Düsseldorf und Hamburg (jeweils acht Prozent) sowie München (neun Prozent) ist deren Anteil deutlich geringer.
 Jörn Glasner
Jörn Glasner
IMMOBILIEN AKTUELL 83
Weckruf
Die Büroflächen in Europas Metropolen sind deutlich in die Jahre gekommen. In den wichtigsten Märkten des Kontinentes drohen bis Ende dieses Jahrzehntes drei Viertel aller Bürogebäude zu veralten – es sei denn, sie werden modernisiert oder es werden neue Nutzungsarten für sie gefunden.
Die Ergebnisse der aktuellen Studie von Cushman & Wakefield, die dies herausgefunden hat, können Büro-Eigentümer als Aufforderung zum Handeln verstehen. Der global tätige Immobiliendienstleister hatte insgesamt 218 Millionen Quadratmeter Bürofläche in elf europäischen Ländern und 14 Metropol-Märkten – von Madrid bis Warschau und von Mailand bis Stockholm –untersucht und herausgefunden, dass sich der Büromarkt mit wachsendem Tempo in drei Segmente aufspaltet. Da sind zum einen die modern ausgestatteten Flächen, die zeitgemäßen Ansprüchen genügen und deshalb auf anhaltend starke Nachfrage treffen. 24 Prozent aller Objekte fallen in diese Kategorie. Am anderen Ende gelten rund 14 Prozent schon heute in vielerlei Hinsicht als veraltet und entsprechen nicht mehr den geforderten Standards.
Besonderes Augenmerk richtet die Studie auf das dazwischen liegende Segment, das mit 62 Prozent den Löwenanteil des untersuchten Bestandes bildet. Objekte dieser Art sind mehr oder weniger deutlich in die Jahre gekommen und müssen demzufolge neu positioniert werden, um sie langfristig erfolgreich am Markt zu halten. Aufgrund ihrer

unzureichenden Ausstattung verfehlen sie aktuell die Bedürfnisse potenzieller Nutzer. Außerdem erfüllen sie Kriterien der Nachhaltigkeit nicht oder nur teilweise, was insbesondere vor dem Hintergrund steigender Anforderungen auf diesem Sektor problematisch ist. Die Studie empfiehlt hier eine objektive Bewertung der Chancen und Risiken, woraus sich tragfähige Strategien zur Neupositionierung ableiten sollten. Diese können neben der Umnutzung aller oder eines Teiles der Räume für andere Zwecke, beispielsweise Wohnen, Industrie, Life Science oder Healthcare, auch in einer stärkeren lokalen Vernetzung durch gemeinschaftsorientierte Angebote und Veranstaltungen liegen.
Zusammen mit den 14 Prozent bereits heute als veraltet geltender Objekte genügen also 76 Prozent des Bestandes in den wichtigsten europäischen Metropolmärkten derzeit nicht den Ansprüchen an moderne Büroflächen. Rund die Hälfte der europäischen Büros ist mehr als 30 Jahre alt. Lediglich 14 Prozent wurden in den zurückliegenden zehn Jahren gebaut oder zumindest grundlegend modernisiert. Besonders hoch ist der Anteil der Flächen, die bereits seit drei Jahrzehnten oder länger am Markt sind, in Mailand, Stockholm und Paris. Im Gegensatz dazu verfügen die Metropolen des Ostens wie Warschau, Prag und Budapest über einen deutlich moderneren Bürobestand.
James Young, Head of Investor Services für die Regionen Europa, Naher Osten, Afrika sowie Asien / Pazifik bei Cushman & Wakefield, sieht den Bürosektor vor einem „kritischen Kapitel der notwendigen Anpassung, Entwicklung und Neukalibrierung“. In ganz Europa gäbe es eine starke Nachfrage nach Büros. „Aber die Nutzer bestimmen den Markt und konzentrieren sich zunehmend auf die besten Arbeitsplätze. Für Eigentümer älterer, qualitativ schwächerer Immobilien ist es keine Strategie, nichts zu tun. Denn nur Vermieter, die in die Nachhaltigkeit, Ausstattung, Aufenthaltsqualität und die Einbindung ihrer Immobilien in das lokale Umfeld investieren, werden sinkende Erträge vermeiden können“, so der Immobilienexperte.
Jörn Glasner
IMMOBILIEN AKTUELL 84
BÜRO & LOGISTIK
„Klassiker kommen nie aus der Mode“
Felix Meyen, Geschäftsführer der HIH Invest Real Estate GmbH, spricht über Qualitätsanforderungen der Office-Mieter, die zunehmende Bedeutung von Bestand und attraktive Deals in schwierigen Zeiten.

IMMOBILIEN AKTUELL (IA): Officeimmobilien sind ein Klassiker, kommt der nun aus der Mode?
Felix Meyen (FM): Büroimmobilien werden immer benötigt, und Klassiker kommen nie aus der Mode. Doch die Zeiten für das Investment sind definitiv anspruchsvoller geworden. Während des Booms hat der Markt nahezu alle Flächen absorbiert. Heute gehen sowohl Investoren als auch Mieter sehr viel selektiver vor.
IA: ‚Nah an der Immobilie‘ lautet einer der Slogans der HIH. Was muss denn diese Immobilie haben, damit Sie Ihre Aufmerksamkeit bekommt?
FM: Generell nehmen die Qualitätsanforderungen der Mieter zu. Das spielt eine zentrale Rolle in unseren Ankaufsentscheidungen. Wir setzen auf zeitgemäße und energieeffiziente Büroimmobilien in attraktiven Lagen. Dabei haben wir nicht nur die Top7Städte im Blick, sondern auch weitere prosperierende, wirtschaftsstarke Standorte. Gerade Universitätsstädte wie Freiburg, Münster oder Erlangen weisen sehr hohe Vermietungsstände bei geringer Volatilität auf. Die Mieter in solchen Städten haben oft eine starke
Bindung an ihren Standort und es wird sehr bedarfsorientiert gebaut.
IA: Es gibt einen sehr großen Gap zwischen neuen und modernen sowie alten Flächen. Welche Rolle spielen bei Ihnen Revitalisierungen?
FM: In unseren Poolfonds spielen sie kaum eine Rolle, nur junge Immobilien im Portfolio sind. Doch bei einigen Individualmandaten, die wir betreuen, sind Revitalisierungen durchaus ein Thema. Kreativität, Marktkenntnis und Erfahrung braucht es, um Bestandsimmobilien an die veränderten Nutzerbedürfnisse anzupassen. Das Asset Management ist in diesen Zeiten sehr stark gefordert. Auf der anderen Seite wird es in den kommenden Jahren viel weniger Neubaufertigstellungen geben, sodass Mietinteressenten auf revitalisierte Bestandsimmobilien ausweichen werden.
IA: Institutionelle Investoren sind momentan sehr vorsichtig, wenn man die Transaktionszahlen im Office-Bereich anschaut. Was braucht es, damit sich das wieder ändert?
FM: Wenn sich die Preise für Büroimmobilien auf einem Niveau
eingependelt haben, die den Investoren attraktive Renditen gewähren, werden wir wieder mehr Transaktionen sehen. Solange die Preisfindung anhält, beobachten wir die Marktaktivitäten sehr genau, denn es ergeben sich auch in der jetzigen Marktphase durchaus Opportunitäten für günstige und attraktive Office-Deals. Ein großer Vorteil ist, dass wir eigenkapitalstark agieren können. Entsprechend sind wir etwas unabhängiger vom Fremdkapital, das mit den Zinserhöhungen deutlich teurer geworden ist.
IA: Welche Bedeutung hat die Drittverwendungsmöglichkeit?
FM: Generell bekommt Flexibilität einen immer höheren Stellenwert. Auf flexiblen Flächen lassen sich nicht nur verschiedene Bürokonzepte umsetzen, also etwa New Work, Großraum oder Einzelbüros. Zugleich steigt damit auch die Drittverwendungsfähigkeit. Im Grunde ist sie ein weiteres Qualitätsmerkmal eines Assets. Diese Faktoren helfen, den Kreis potenzieller Mieter zu erweitern – und darauf kommt es an.
Interview: Ivette Wagner
IMMOBILIEN AKTUELL 85 BÜRO & LOGISTIK
Aufschwung adé
Die Sonderkonjunktur auf dem Markt für Logistikimmobilien ist vorbei – trotz hoher Nachfrage. Die Deals mit Lagerhallen und Verteilzentren entwickeln sich verhalten, der Neubau stagniert. Die Frage ist nun, wie lang die Durststrecke wird.
Zwei Dutzend Betonpfeiler ragen in den blauen Himmel. Es sind die ersten Stützen des künftigen Gebäudes, seine Dimensionen lassen sich bereits erahnen. Im Herzen von Deutschlands einzigem Tiefwasserhafen, dem JadeWeserPort in Wilhelmshaven, feierte P3 Logistic Parks Mitte Juli 2023 den Baustart für einen neuen P3 Park, bestehend aus drei Logistikhallen, je zwölf Meter hoch, mit zusammen 17 ebenerdigen Toren und 111 Überladebrücken. Die vermietbare Gesamtfläche: 140.000 Quadratmeter. „Wir bauen zum ersten Mal an der Küste“, so Sönke Kewitz bei der Zeremonie, Geschäftsführer des Entwicklers, Eigentümers und langfristigen Investors, der nach eigener Darstellung mehr als zwei Millionen Quadratmeter Fläche im Eigentum hat. Die schrittweise Umsetzung soll bis Anfang 2025 erfolgt sein.
Zurückhaltung in puncto Baustarts
Das Großvorhaben ist eines der rar gesäten Beispiele für den Neubaustart einer Logistikimmobilie. Laut Kuno Neumeier, CEO des Beratungsunternehmens Logivest, sei die Nachfrage nach Logistikflächen zwar nahezu ungebrochen, aber „durch die wirtschaftliche Unsicherheit und die gestiegenen Kosten haben Bestandsimmobilien an Relevanz gewonnen“. Spekulativen Neubau gebe es fast nicht mehr. Logivest zählte für das erste Halbjahr 2022
rund 2,1 Millionen Quadratmeter Neubauvolumen auf dem Markt für Logistikimmobilien, Basis sei der Zeitpunkt des Baustartes. Nach dem Abfall der Neubauzahlen im vierten Quartal 2022 auf unter 750.000 Quadratmeter und damit auf das niedrigste Niveau der vergangenen fünf Jahre habe die Bautätigkeit pro Jahresviertel immerhin auf circa eine Million Quadratmeter zugelegt.

Ein weiteres Projekt, das 2023 in die Realisierung ging, ist der Mittelweser Park in Estorf. Die Investmentfirma BentallGreenOak und der Entwickler thirteen seven aus Aachen errichten in der niedersächsischen Gemeinde bis Herbst 2024 insgesamt zwölf Hallen mit 127.000 Quadratmetern Logistikfläche. Die Joint Venture-Partner streben für die Neubauten höchste ökologische Standards an, etwa eine DGNB-Zertifizierung in Platin sowie die EffizienzhausStufe 40. Stichworte hierzu sind Photovoltaik, Dachbegrünung, Regenwasserversickerung, LED-Beleuchtung sowie eine naturnahe Begrünung von fünf Hektar.
Knappes Angebot hemmt Transaktionen
Dass jedoch nicht mehr alle Logistik-Neubauvorhaben vorangetrieben werden, lässt sich vor allem auf die erschwerten Rahmenbedingungen bei der Finanzierung und im Verkauf zurückführen. „Aufgrund der nach wie vor steigenden Zinsen und der anhaltenden Preisfindungsphase zeigen sich Investoren zurückhaltend und selektiver“, erläutert der Sprecher des Gewerbeimmobilien-Netzwerkes German Property Partners (GPP), Andreas Rehberg. Resultat sei ein wachsender Angebotsmangel, der wiederum ein erlahmtes Transaktionsgeschehen nach sich ziehe.
Die Experten von CBRE ermittelten für das erste Halbjahr 2023 einen Flächenumsatz mit deutschen Logistikimmobilien von rund 2,1 Millionen Euro. Das Vorjahresergebnis sei damit um mehr als die Hälfte verfehlt worden. Im Neubausegment betrage das Minus sogar 67 Prozent. „Die Logistik-Überkonjunktur, die während der Pandemie durch den E-Commerce und durch Pufferlager entstand, ist zu Ende“, ordnet Rainer Koepke, Head of Industrial & Logistics bei CBRE, die Researchdaten ein. Immer noch seien die Lager gut gefüllt und die Leerstände in den Top-Lagen im Ein-Prozent-Bereich.
BÜRO & LOGISTIK
Die enorme Flächennot zeigt sich besonders in den etablierten Ballungszentren und führt dazu, dass Unternehmen verstärkt in Regionen außerhalb der Metropolen ausweichen. „Gebiete, die für sie einst nicht infrage kamen, geraten nun zunehmend in den Fokus“, sagt Sarina Schekahn. Die Logistik-Vermietungschefin bei JLL verweist unter anderem auf den Aconlog Logistikpark Greven, den die WM Group unlängst zu gut zwei Dritteln angemietet hat. Die Anlage umfasst insgesamt 70.000 Quadratmeter Nutzfläche, verteilt über drei Gebäude, soll nahezu ohne fossile Energieträger auskommen und im Frühjahr 2024 vollendet sein. Verantwortlich zeichnen die bauwo Grundstücksgesellschaft mbH aus Hannover und die Kölner Aconlog Projektentwicklung GmbH. Das Projekt steht exemplarisch für das zumindest im Großraum Münster / Osnabrück florierende LogistikGeschäft. Laut Logivest startete hier in den ersten sechs Monaten 2023 der Neubau von circa 190.000 Quadratmetern Mietfläche, nach lediglich rund 70.000 Quadratmetern im Vorjahreszeitraum.
Prognose: Zunehmende Investmenttätigkeit

Auch wenn der Logistikimmobilienmarkt 2023 voraussichtlich nicht an die Erfolge der vergangenen Jahre anknüpfen wird – 2021 stand noch ein Flächenumsatz von über acht


Millionen Quadratmetern zu Buche –, sehen Branchenkenner zumindest eine gewisse Stabilisierung. Positiv bewerten lasse sich der Ausblick auf die Pipeline, die gut gefüllt ist, so Logivest-CEO Kuno Neumeier: „Der Markt hat alle Optionen, viele spannende Projekte sind geplant.“
Mut machen auch Aussagen wie die von Markus Kroner, Geschäftsführer von Alcaro Invest: „Wir wollen weiter moderat wachsen und planen sowohl Zukäufe als auch selektive Verkäufe.“ Im Blick hat das bundesweit aktive Unternehmen neben kleineren Projekten und Revitalisierungen vorrangig die Entwicklung und Vermietung bereits begonnener Logistik- und Gewerbevorhaben wie dem Log Plaza Frankfurt an der Oder.
Einschätzungen von GPP zufolge erfährt das Transaktionsgeschehen in nächster Zeit wieder mehr Dynamik, sofern ein stabiles Zinsniveau mehr Planungssicherheit schafft. Logistikimmobilien seien nach wie vor „eine Assetklasse mit viel Potenzial“, betont Sprecher Andreas Rehberg. Trends wie die Rückkehr zur Lagerhaltung wegen gestörter Lieferketten, die Rückverlagerung von Produktionsanlagen nach Deutschland und der perspektivisch weiterwachsende Onlinehandel erhöhten den Bedarf an modernen Logistikflächen. Zudem würden Energiewende, Digitalisierung und Elektromobilität industrielle Umstrukturierungen forcieren. Andreas Rehberg ist sich sicher: „Hiervon profitieren Logistikimmobilien in besonderem Maße.“
IMMOBILIEN AKTUELL 87 BÜRO & LOGISTIK
Ivette Wagner, Matthias Klöppel
Neubauvolumen im Jahresvergleich
Quelle: Loginvest GmbH
Knoten geplatzt
DISTRIBUTION ALS LEBENSADER DER WIRTSCHAFT
Eine Logistikimmobilie ist nicht mehr nur ein Gebäude mit einer Aufgabe, sondern wird zu einem Allrounder. Bei GARBE wird von einer Evolution gesprochen.
LOGISTIKIMMOBILIEN ALS INFRASTRUKTURKNOTENPUNKTE | DISTRIBUTION
Es klingt fast zu einfach: Logistikimmobilien werden zu Infrastrukturhubs. Mit Distribution als prägendem Merkmal, Photovoltaik, Windkraft, Batteriespeicher, Wasserstoff- und Nahwärmeproduktion, Breitbandausbau und Rechenzentrum. Von einer Evolution sprechen die Ex perten von GARBE Industrial Real Estate. Die Argumenta tion ist dabei logisch: Bestand nutzen und ihn bereit für die Zukunft machen. GARBE schätzt, dass es in Deutschland ab Baujahr 2000 zwischen 22.000 und 24.000 moderne Logistikimmobilien gibt, deren Größe steigt. „Man muss sich das enorme Potenzial vor Augen führen, dass rund 24.000 solcher PV-Anlagen mit sich bringen. Dazu kommen weitere Dachflächen anderer Nutzungsarten ab 5.000 Qua dratmetern. Dann sind wir sogar bei 32.500 Dächern. Alles zusammengerechnet kommen wir auf rund 382,5 Millionen Quadratmeter Brutto-Dachfläche“, sagt Jan Dietrich Hem pel, Geschäftsführer von GARBE Industrial Real Estate.

Für ihn heißt das: Es geht um den Ausbau von Infras trukturhubs. Diese Knotenpunkte sind Allrounder. Bei GARBE, die, wo möglich Photovoltaik installieren, wird an noch viel mehr gedacht. In Prüfung befinden sich die Nutzung von Paneelen und Folien für Fassaden sowie Technologien für die Integration von Windkraftanlagen. „Enormes Potenzial liegt außerdem in der Wasserstofferzeugung sowie in der Batteriespeicherung von Strom“, sagt Tobias Kassner, Leiter Research und Mitglied der Geschäftsleitung bei GARBE Industrial Real Estate. Rein technisch seien die meisten dieser Technologien bereits etabliert. „Das zeigt das Beispiel Elektrolyse: Die Technik ist schon da, das Problem ist die Wirtschaftlichkeit. Bei Wasserstoff muss man erst eine umfassende Infrastruktur aufbauen und Skaleneffekte erzeugen, die Politik dafür ein entsprechendes Rahmenwerk liefern und der Wille zur Umsetzung deutlich gemacht werden, um diese Technik am Markt zu etablieren.“ Allerdings schränkt er direkt ein: „Die Vision einer Immobilie auf voller Ausbaustufe wird ehrlicherweise noch ein paar Jahre dauern.“ Trotzdem: Der Blick geht nach vorn. Visionen warten
Bildquelle: GARBE Industrial Real Estate
auf Umsetzung. Dafür hat das Hamburger Unternehmen Gesellschaften gegründet, die sich damit beschäftigen (GARBE Infrastructure und NDC-GARBE Data Centers Europe). Knowhow wird in Zeiten von reduzierten Flächen immer wichtiger. Wie kann also Wasserstoff produziert, wie ein Datencenter genutzt werden? Doch nicht nur der rein technische Ansatz, die Nutzung des Bestandes und damit sehr viel mehr ESG-Strategie als gewöhnlich, spielt eine Rolle: „Punkte wie die Stromerzeugung können auch eine Gemeinde von einem Logistikprojekt überzeugen, weil es eben jetzt nicht mehr nur um Logistik, sondern um kritische Infrastruktur geht, die im besten Sinne nachhaltig ist. So nutzen wir jeden Quadratmeter besser, sowohl auf grünen Flächen als auch auf Brownfields“, sagt Jan Dietrich Hempel. Heißt: mehr Akzeptanz für Logistik und damit auch mehr Flächen.
 Ivette Wagner
Ivette Wagner
IMMOBILIEN AKTUELL 88 BÜRO & LOGISTIK
Doppelpack an der A24
Im mecklenburgischen Wittenburg wachsen gleich zwei große Logistikzentren direkt an der Autobahn. Sie stehen exemplarisch für die neue alte Realität auf dem Hamburger Markt.
Auch wenn sie nur etwa 240 Kilometer lang ist, hat sie für den Warengüterverkehr in Deutschland eine große Bedeutung: die A24 – verbindet sie mit Hamburg und Berlin doch die beiden größten Städte des Landes miteinander. Genau dieser Umstand macht sie nicht zuletzt für Logistikansiedlungen interessant. Kommunen wie die Stadt Wittenburg, gelegen etwa auf halber Strecke der Autobahn, gehören zu den Profiteuren. Gleich zwei riesige Logistikprojekte befinden sich in dem 6.400 Einwohner zählenden Ort in der baulichen Umsetzung, räumlich getrennt durch die A24.
Auf einem rund sieben Hektar großen Grundstück nördlich der Transitstraße lässt die Deutsche Logistik Holding (DLH) einen Logistikcampus mit insgesamt rund 30.500 Quadratmetern Hallen- und ergänzender Bürofläche entstehen. Der Neubau wird in drei Abschnitte aufgeteilt und biete „individuelle Flexibilität für verschiedene Nutzungskonzepte und Flächenbedürfnisse“, so die Tochter der Zech Group, die sich nach eigener Darstellung in positiven und konstruktiven Gesprächen mit potenziellen Mietern befindet (Stand: Ende Juli).


Energieversorgung ohne CO₂-Emissionen
Das Objekt soll über alle Anforderungen eines modernen Logistikzentrums verfügen und mit diversen ESG-Highlights punkten. So wird die DLH das Dach vollflächig mit einer Photovoltaikanlage versehen, sodass im Zusammenspiel mit einer Luft-Wärmepumpe ein klimaneutraler Betrieb ermöglicht werde, heißt es. Neben dem Energieeffizienzstandard KfW 55 strebt das Unternehmen auch eine DGNB-Zertifizierung in Gold an. „Mit diesem Campus werden unsere Expansionsaktivitäten im hohen Norden weiter untermauert“, sagt Christoph Telker, einer der Geschäftsführer der DLH. Der Projektentwickler feierte im März 2023 die Grundsteinlegung für das Vorhaben. Spätestens Anfang 2024 erfolgt voraussichtlich die Fertigstellung.
In einem gleichermaßen rasanten Tempo agiert der Logistik-Spezialist Panattoni auf einem ehemals agrarwirtschaftlich genutzten Areal südlich der A24. Dem Baustart für ein neues Logistikzentrum im Frühjahr 2023 folgte Mitte Juli schon das Richtfest. Zum Jahreswechsel 2023 / 2024
soll der Neubau mit rund 36.500 Quadratmetern Gesamtnutzfläche vollendet sein. Panattoni errichtet die Immobilie für die Kühne + Nagel International AG, die wiederum eine Nutzung als globales Ersatzteillager für ein Unternehmen aus dem Bereich der erneuerbaren Energien vorsieht. Zu den Maßnahmen im Sinne der Nachhaltigkeit zählen unter anderem die Installation von Gründächern, Luft-WasserWärmepumpen sowie ein smartes EnergiemanagementSystem. Auch Panattoni erhofft sich eine Auszeichnung mit dem DGNB-Gold-Zertifikat.
Hamburger Logistikmarkt hält sich wacker
Dass die beiden Projekte entlang der A24 in die Höhe wachsen, liegt neben den Standortvorteilen auch an der Flächenknappheit im nahegelegenen Hamburg, wie die Geschäftsführer der Realogis Immobilien Hamburg GmbH, Stefan Imken und Jörg Lojewski, konstatieren. Durch den Grundstücksmangel seien Unternehmen gezwungen, in die Peripherie auszuweichen, beispielsweise auch entlang der Autobahnen 7 in Richtung Flensburg und 1 in Richtung Bremen.
Im ersten Halbjahr 2023 erzielte die Metropolregion Hamburg laut Realogis einen Flächenumsatz von 220.000 Quadratmetern mit Industrie- und Logistikimmobilien. Das entspreche einem zweistelligen Rückgang gegenüber dem Vorjahreszeitraum, sei aber dennoch als „leicht überdurchschnittliches Ergebnis“ einzuordnen. In Hamburg, sagt Jörg Lojewski, treffen „kaum verfügbare Flächen und hohe Baukosten“ auf eine „weiterhin dynamische Nachfrage nach hochwertigen Logistikflächen“. Diese sollen sich durch „Nachhaltigkeit und die Einhaltung von ESG-Kriterien“ auszeichnen und mit ihren ressourcenschonenden Konzepten für Entlastung bei den Energiekosten sorgen. Die im Bau befindlichen Logistikparks in Wittenburg belegen dieses Ziel eindrucksvoll.
Matthias Klöppel
IMMOBILIEN AKTUELL 89 BÜRO & LOGISTIK
Zwischen Einbruch und Aufbruch
Gesunkene Umsätze und gestiegene Betriebskosten belasten den Einzelhandel, mitunter bis zur Insolvenz. Zugleich ergeben sich nach den Pandemiejahren vielerorts Möglichkeiten für Anmietungen und Neueröffnungen mit frischen Konzepten.
„Die Zahl der Ladengeschäfte in Deutschland nimmt auch 2023 weiter ab“, sagt Alexander von Preen, Präsident des Handelsverbandes Deutschland (HDE). Die Spitzenorganisation des deutschen Einzelhandels prognostiziert für das laufende Jahr einen Rückgang der Ladenzahl um rund 9.000 auf bundesweit noch 311.000 Geschäfte. Zum Vergleich: Von 2015 bis 2019 sank die Zahl der Läden pro Jahr um 5.000, von 2020 bis 2022 jährlich um 11.000.
„Angesichts der Zahlen der letzten Jahre müssen in allen Innenstädten und bei der Politik alle Alarmglocken
läuten. Denn ohne erfolgreichen Einzelhandel haben die Stadtzentren kaum Zukunftsperspektiven“, warnt der HDE-Präsident.

Widrige Rahmenbedingungen
In der Tat steht der Handel vor großen Herausforderungen. Die erhoffte Erholung nach den Pandemiejahren wird seit 2022 von der hohen Inflation und dem Kaufkraftverlust der Privathaushalte gebremst. Neben den Umsatzeinbußen müssen die Einzelhändler gestiegene Einkaufspreise, höhere Kosten für Heizung, Klimatisierung und Beleuchtung, die Konkurrenz durch Onlinehändler sowie Indexmieten verkraften. Etliche bleiben dabei auf der Strecke.
Die Liste derer, die allein im ersten Halbjahr 2023 ein Insolvenz- oder Schutzschirmverfahren beantragen mussten, reicht von Modehändlern wie TK Fashion und Peek & Cloppenburg über Damenmode-Anbieter wie Gerry Weber und Hallhuber oder Schuhfilialisten wie Reno, Görtz und Salamander bis hin zum Kaufhauskonzern Galeria Karstadt Kaufhof.
Doch es gibt Licht am Horizont. Die Einzelhandelsumsätze haben sich laut ZIA Zentraler Immobilien Ausschuss e.V. in den vergangenen beiden Jahren dank der Aufholeffekte nach Corona positiv entwickelt. Die Passantenfrequenz steigt vor allem in den A-Städten wieder an. Auch die nach dem
IMMOBILIEN AKTUELL 90
Beginn des Ukrainekrieges eingetrübte Konsumstimmung hat sich deutlich aufgehellt. Ein Übriges tun die staatlichen Hilfen für Verbraucher und Unternehmen.
Chancen auf neue Anmietungen
Vor diesem Hintergrund kehrt das Vertrauen der Handelsunternehmen in die Märkte zurück, was sich in zunehmenden Filialeröffnungen widerspiegelt. „Viele Unternehmen nutzen die Chancen, die sich auf dem Immobilienmarkt für neue Anmietungen ergeben“, berichtet der ZIA in seinem Frühjahrsgutachten 2023. Fachmarktzentren, Quartierslagen, Toplagen in Oberzentren sowie die Stadtzentren von Mittelstädten würden von den Expansionsverantwortlichen im Handel weiterhin positiv bewertet. Zwar hätten viele Geschäfte schließen müssen, doch gebe es neue Mieter und Konzepte, die das Angebot der Städte „sogar vielfältiger machen“.
So geschehen zum Beispiel im ehemaligen Galeria Kaufhof in Cottbus. Nachdem die Warenhauskette ihren Mietvertrag im März 2023 gekündigt hatte, mietete die Dortmunder TEH Textilhandel GmbH – bekannt für Modehäuser unter dem Namen aachener – rund 12.000 Quadratmeter Fläche für zehn Jahre. Auf den übrigen 10.000 Quadratmetern des Hauses sollen Drogerie- und Lebensmitteleinzelhandel sowie der Bürgerservices der Stadt Cottbus und die Stadtbibliothek angesiedelt werden.
Innenstädte im Wandel
Ähnliches vollzieht sich derzeit in vielen Städten, wie eine Studie der DZ Hyp AG zur Nachfrage nach Büro- und
Einzelhandelsflächen ergab. Demnach zieht sich der klassische Handel (Mode, Schuhe, Warenhäuser) aus den Innenstädten zurück. Die leerstehenden Flächen erobern Mieter, die zuvor eher in Randlagen anzutreffen waren: Discounter, Billigshops, Handyläden, Nagelstudios und Barbershops. Hinzu kommen Formate, die bisher selten in den Citys vertreten waren, etwa Möbel (IKEA), Autos (Polestar) und Fahrräder (Genesis).
Ein weiterer Trend ist die Umwandlung leerstehender Warenhäuser in Mixed-Use-Objekte, in denen neben Handelsflächen künftig auch Büros, Hotels, Wohnungen und Fitnessstudios zu finden sind. Beobachten lässt sich dieser Wandel unter anderem in der Leipziger Fußgängerzone. Das dortige ehemalige Karstadt-Warenhaus wird derzeit zu einem multifunktionalen Büro- und Geschäftsensemble mit Einzelhandel und Gastronomie umgebaut.
Nach Einschätzung der DZ Hyp-Studienautoren hat der stationäre Einzelhandel dann eine Zukunft, wenn er sich im Wettbewerb mit dem E-Commerce nicht allein auf eine attraktive Innenstadtlage verlässt. Hinzu kommen müssten Digitalisierung, verzahnte Vertriebskanäle, nachhaltige Sortimente und preisgünstige Angebote. Letztere ließen sich zum Beispiel durch Selbstbedienungskonzepte realisieren, die zugleich eine Antwort auf den Personalmangel seien.
Für HDE-Präsident Alexander von Preen ist der Handel nicht nur Versorger der Bevölkerung, sondern auch „Pfleger des Kulturraumes Innenstadt“. Darum setzt sich der HDE für eine Gründungsoffensive ein. Neuansiedlungen und Gründungen bräuchten optimale Bedingungen. So sollte es neben schnellen Genehmigungsprozessen für Umbauten und Umwidmungen auch flächendeckend Ansiedlungsmanager geben. Dann ließen sich die Lücken in den Stadtzentren schnell wieder schließen.
Frank Baecke
Die Einkaufsmeilen sind wieder so voll wie vor Corona Abweichung in % gegenüber 2019, 10-Tages-Mittelwert
IMMOBILIEN AKTUELL 91 SCHWERPUNKT:
EINZELHANDEL
Quelle:
01.20 01.20 01.21 01.21 01.22 01.22 01.23 40 20 0 -20 -40 -60 -80 -100
Passantenfrequenz (Durchschnitt 5 Einkaufsstraßen)
hystreet.com /
Destatis Stand Januar 2023
Berlin (Kurfürstendamm Nordseite), Frankfurt (Große Bockenheimer Str.), Hamburg (Spitalerstr.), Köln (Schildergasse), München (Neuhauser Str.)
Ja und nein
Shoppingcenter gehören zu den meistdiskutierten Immobilien. Sind sie nun aus der Zeit gefallen oder nicht?
Sie sind groß, jeder kennt sie, früher waren sie Schauplatz für Cliquentreffen oder Drehorte für Serien. Die Ausflüge dorthin waren beliebt, galten als Hobby. Malls waren einfach nur gut. Heute nennt sich das Gute: Aufenthaltsqualität. An der wird gefeilt, weil unter anderem PwC „die fehlende Berücksichtigung der Ansprüche an den Mietermix als einen wesentlichen Grund für den Misserfolg von Shoppingcentern identifiziert“. Für die PwC-Studie 2023: Herausforderungen für Einzelhandelsimmobilien und Perspektiven für Shoppingcenter wurden Besucher wie auch Betreiber befragt. Erstere frequentieren vor allem Lebensmittelgeschäfte, Drogerien, Bäckereien und Feinkostläden, üben also ganz klassischen Bedarfseinkauf aus. Daran sind aber nicht nur der Online-Handel oder die Pandemie Schuld.
Die Attraktivität der früheren Tempel wich mit der Einzigartigkeit. Filialisten machten sich breit, es war eigentlich egal, wo man einkaufte: Das Sortiment unterschied sich nicht wesentlich. Nur: Was bedeutet das? Aengevelt Research verweist darauf, dass „die Einzelhandelsstandorte ihren Modernisierungskurs weiter fortsetzen müssen, um auf Dauer gegenüber dem Online-Handel konkurrenzfähig zu bleiben“. Dies könne geschehen durch Mixed-Use-Konzepte mit Mischungen aus Einzelhandel, Dienstleistungen, Gastronomie, Freizeit und Wohnen, Erlebniseinkaufskonzepten,
flexiblen Konzepten wie Pop-Up-Stores, um auf kurzfristige Trends reagieren zu können, sowie für Einzelhändler selbst den Auf- und Ausbau des Multi-Channel-Vertriebes. In der PwC-Studie werden dazu noch „ansprechend gestaltete (Außen-)Flächen“ benannt.
Individuell muss es sein. So kombiniert das Düsseldorfer Unternehmen Schwitzke & Partner für den StreetwearAnbieter LIVE FAST DIE YOUNG im Flagship-Store im denkmalgeschützten Haus in Berlin Coolness mit Gastronomie. Ein edelstahlummantelter Kassentresen im Eingangsbereich bildet „den Auftakt zu einer einzigartigen kontrastreichen Customer Journey“. Die denkmalgeschützten Holzböden und vertäfelten Wände blieben, genau wie die historisch doppelflügelige Tür. Mittendrin: das erste LFDY-Café mit einem drei Meter langen Tresen aus grünem Marmor. Das Shoppingcenter Boulevard Berlin in Steglitz-Zehlendorf sortierte die über 50 Shops im Erd-und im Untergeschoss neu. „Die größte Veränderung erfahren die erste und zweite Etage. Nach jahrelangem Leerstand und vielen Überlegungen, wie die Flächen sinnvoll genutzt werden könnten, entstehen hier nun Büroräume für bis zu 3.000 Mitarbeiterinnen und Mitarbeiter“, so Centermanagerin Anja Schieban.
Erstaunlich ist der Fakt, dass sich in der PwC- Studie eine große Uneinigkeit der Betreiber zeigt. 66 Prozent von jenen, die sich für eine Zukunftsfähigkeit aussprechen, glauben, dass Shoppingcenter immer beliebt sein werden. 80 Prozent derer, die sich gegen eine Zukunftsfähigkeit entschieden haben, glauben, dass der Konsum vermehrt über den OnlineHandel laufen wird. Und das wiederum führt zu sinkender Fluktuation. 62 Prozent alle befragten Betreiber halten eine reine Einzelhandelsnutzung für nicht mehr zukunftsfähig. Eine richtig befriedigende Antwort findet sich auf die Frage, welche Zukunftschancen Shoppingcenter haben, allerdings nirgendwo. Zu sehen sind unterschiedliche Versuche.
Einzelhandelstransaktionsvolumen nach Nutzungsart Transaktionsvolumen (Einzelhandelsimmobilien) in Deutschland
2022: 9,43 Mrd. Euro
H1 2023: 2,62 Mrd. Euro
Geschäftshäuser Fachmarktzentren Supermärkte Shopping-Center Fachmärkte Warenhäuser
IMMOBILIEN AKTUELL 92 SCHWERPUNKT: EINZELHANDEL
Quelle: JLL
7 % 31 % 29 % 11 % 9 % 13 % 7 % 10 % 6 % 21 % 13 % 43 %
Immerhin: Aengevelt wertet die gesamtwirtschaftlichen Rahmenbedingungen für die Erholung des privaten Konsums als sehr positiv. „Damit kann auch der stationäre Einzelhandel steigende Umsätze erwarten. Das sind gute Nachrichten für die Handelsimmobilien und die Innenstädte, die wieder belebter werden“, fasst Lars Rehbein von Aengevelt Research zusammen. Dem kann Hans-Peter Kneip zustimmen. Der Vorstand der Deutschen EuroShop (DES), einem Shoppingcenter-Investor, verzeichnete für das erste Halbjahr 2023 mehr Kundenfrequenz und höhere Umsätze. Das Unternehmen kaufte Anfang 2023 Anteile an sechs
Shoppingcentern, was für Vertrauen in die Assetklasse spricht. Auch wenn seit 2020 keine neue Mall mehr gebaut wurde und die Leerstandsquote bei mehr als zehn Prozent liegt und damit höher als in anderen Assetklassen. Sarah Hoffmann, Head of Retail Investment bei JLL Germany, sagt: „Nachdem Fachmarktprodukte in den vergangenen Jahren der Liebling der Investoren waren, zeigt sich zunehmend, dass auch Shopping-Center wieder auf den Kauflisten stehen.“ Das lässt hoffen. Auch wenn die Rendite laut dem Beratungshaus für die Assetklasse bei fünf Prozent verharrt. Ivette Wagner

SCHWERPUNKT:
EINZELHANDEL
SCHWERPUNKT: EINZELHANDEL
Super Märkte
Der Lebensmitteleinzelhandel hat sich als krisenresilient erwiesen und bleibt damit ein attraktives Investment. Um die Performance der Immobilien zu stabilisieren, sind jedoch neue Konzepte und Nutzungsformen gefragt.
Auch die Retail-Sparte kann sich der wirtschaftlichen Großwetterlage nicht entziehen. Mit einem Transaktionsvolumen von knapp 2,6 Milliarden Euro bis zur Jahresmitte 2023 blieben die Retail-Investments um 36 Prozent hinter dem Vorjahresergebnis zurück, meldete BNP Paribas Real Estate.
Der Rückgang bedeutet allerdings nicht, dass Einzelhandelsobjekte unattraktiv geworden sind. Im Gegenteil. Trotz des verhaltenen Marktgeschehens legten die
Spitzenrenditen laut BNP Paribas Real Estate über alle Objektarten und Städte hinweg zu. Im Segment der Supermärkte und Discounter ging es in den ersten sechs Monaten um 20 Basispunkte auf 4,7 Prozent nach oben (2022: 4,3 Prozent, 2021: 3,6 Prozent). Colliers sagt für das Gesamtjahr 2023 eine Bruttoanfangsrendite für Fachmärkte mit Lebensmittelschwerpunkt von fünf Prozent voraus.
Dass Handelsimmobilien weiterhin attraktiv sind, belegt auch der Hahn Retail Real Estate Report 2022 / 2023. 64 Prozent der Befragten wollen tendenziell zukaufen. Im Fokus stehen lebensmittelgeankerte Handelsimmobilien und discountorientierte Fachmärkte. Ihnen wird wegen ihrer relativ konjunkturunabhängigen und onlineresistenten Sortimente eine besonders stabile Entwicklung zugetraut. Um diese zu gewährleisten, setzen die Lebensmittelhändler auf neue Konzepte und Nutzungsformen.
Vollsortimenter lenken zum Beispiel die Aufmerksamkeit der Kunden auf die eigenen Preiseinstiegs- und Handelsmarken. EDEKA wirbt sogar mit dem Slogan: „In jedem EDEKA steckt ein Discounter“. Hintergrund ist, dass viele Verbraucher wegen gestiegener Energiekosten und hoher Inflation auf preisgünstige Produkte und Marken

SCHWERPUNKT: EINZELHANDEL
ausweichen. Gleichzeitig bauen die Vollsortimenter ihre Angebote an frischen, regionalen, veganen und Bio-Produkten aus, um sich von den Discountern abzusetzen.

Wachsen mit neuen Konzepten
Neben Sortimenten und Preisen sind Marktgrößen und Nutzungskonzepte wichtige Faktoren für stabiles Umsatzwachstum. EDEKA zum Beispiel bespielt die gesamte Klaviatur: von großen E Centern mit 2.500 bis 4.000 Quadratmetern Verkaufsfläche über Verbrauchermärkte mit 1.000 bis 2.500 Quadratmetern bis hin zu kleinflächigen Kompaktmärkten für die städtische Nahversorgung mit weniger als 900 Quadratmetern.
Dass es noch kleiner geht, zeigt Tegut mit seinen teo-Minimärkten, die auf nur 50 Quadratmetern rund 950 Artikel des täglichen Bedarfes bieten. Laut Thomas Stäb, Geschäftsleiter Vertrieb, schließt das Konzept nicht nur Nahversorgungslücken, sondern entspricht auch heutigen Lebensgewohnheiten. „Sie können ihren Einkauf wesentlich flexibler in die Zwischenräume ihres Tagesablaufes
integrieren“, erklärt Thomas Stäb. Die videoüberwachten Shops benötigen kein Personal und sind rund um die Uhr sieben Tage die Woche geöffnet. Die Kunden scannen ihre Einkäufe selbst und zahlen per Karte oder App.
Digitalisiert wird auch bei anderen Anbietern. Rewe zum Beispiel investiert in Bestandserfassungs-Apps, digitale Preisschilder und Kassenlos-Systeme. Zudem gibt es in Berlin, München und Köln erste Rewe Pick & Go-Märkte. Hier werden Artikel, die in den Wagen gelegt werden, von Kameras und Sensoren erfasst und beim Hinausgehen automatisch abgerechnet. Das Anstehen an der Kasse entfällt. Eine App macht es möglich.
Dank Miniaturisierung und Digitalisierung kehren auch die Dorfläden zurück. Bis zu 700 Stück will der 2018 gestartete Online-Supermarkt myEnso bundesweit unter dem Namen Tante Enso eröffnen. Rund 20 gibt es bereits. Ländliche Orte können sich bei myEnso um solch einen Mini-Supermarkt bewerben. Er wird errichtet, sobald mindestens 300 Menschen einen Genossenschaftsanteil gekauft haben. Ein Tante Enso-Laden hält auf 150 bis 200 Quadratmetern rund 3.000 Artikel parat. Weitere Produkte können im Online-Supermarkt myEnso bestellt und im Laden abgeholt werden. Dieser ist 24 / 7 geöffnet. Die Einkäufe werden selbst gescannt und mit Karte bezahlt.
Innenstadtfilialen: klein, aber fein
Wachstumschancen bieten auch die Citys. In Fußgängerzonen und Shoppingcentern gibt es nach der Coronakrise etlichen Leerstand. Lidl hat für Innenstadtfilialen ein Konzept für kleinere Flächen im Bestand entwickelt. Ende Januar 2023 eröffnete eine solche Filiale im Leipziger CityEinkaufszentrum Höfe am Brühl. EDEKA will Mitte 2024 in der Münchner Innenstadt eine Filiale in einem ehemaligen Conrad Elektronik-Markt eröffnen. Rewe zog 2022 ins Jenaer Einkaufszentrum Neue Mitte. Auch Aldi Nord richtete im Vorjahr Innenstadtfilialen in Berlin, Essen und Recklinghausen ein, unter anderem in ehemaligen Kaufhofund Karstadt-Häusern.

Aus Investorensicht bleiben Lebensmittelmärkte interessant. Laut Patrick Brinker, Head of Real Estate Investment Management bei Hauck Aufhäuser Lampe, korrigieren sich die Preise gerade infolge der Zinsentwicklung und der abwartenden Haltung der Investoren. „Damit bieten sich attraktive Einstiegsgelegenheiten“, so der Experte. Spätestens, wenn sich das Zinsniveau stabilisiert, würden Nachfrage und Kaufpreise wieder ansteigen.
Frank Baecke
IMMOBILIEN AKTUELL 95
Gastbeitrag von Markus Lewe, Präsident des Deutschen Städtetages und Oberbürgermeister der Stadt Münster

Innenstadt: Wohnzimmer für alle?
Geht es um die Innenstadt, wird es emotional: Es gibt wohl keinen Ort der Stadt, an dem so viele Menschen genau beobachten, was sich verändert. Leerstände, Schmuddelecken, Neu- und Umbauprojekte, Ruhestörung oder ‚nix los‘ – all das wird lebhaft von der Stadtgesellschaft diskutiert. Für viele Bewohnerinnen und Bewohner ist die Innenstadt Identifikationsfläche, Teil des Gefühls, in der Stadt zu Hause zu sein – ein Wohnzimmer für alle mitten im urbanen Raum. Kann es nicht so bleiben?
Wandel ist nicht neu, Wandel ist Zeichen von Stadtentwicklung, Wandel wird es geben müssen. Das wird am Beispiel des Handels deutlich. Wir brauchen eine Verkehrswende, wir müssen die Städte vor Überhitzung schützen, dem Klimawandel anpassen und uns auf extreme Wetterereignisse vorbereiten. Städte sind Experten des Wandels, der Transformation und stets offen für Neues. Es liegt auf der Hand: Innenstädte müssen sich neu erfinden.
Die Erwartungen haben sich allerdings kaum verändert: In zentralen Lagen spielt sich das Leben ab, hier treffen unterschiedliche Menschen aufeinander. Die Innenstadt ist Bühne und Treffpunkt, traditioneller Marktplatz und Schmelztiegel vieler Kulturen und Lebensentwürfe. Historische und besondere Bauwerke, belebte Flaniermeilen und Einkaufsstraßen mit vielen Begegnungen und Erlebnissen – das verbinden viele Menschen mit der City und vielen Stadtteilzentren. Gerade dort, wo in den vergangenen
Jahrzehnten das Einkaufen im Mittelpunkt stand, findet ein Wandel statt. Geschäfte, selbst in hochwertigen Lagen, stehen leer. Kaufhäuser und Einkaufszentren suchen neue Nutzungen. Der große Boom des Einzelhandels ist vorbei. Dafür ist das Online-Angebot zu stark geworden: Es ist einfach und bequem, vom Sofa zu Hause aus shoppen zu gehen. Natürlich kämpfen wir um alteingesessene Einzelhändler. Wir wollen Möglichkeiten schaffen, dass das Besondere, das haptisch Erlebbare, bleibt, dass es in besonderer Weise für Menschen attraktiv wird, in der Innenstadt einzukaufen. Wir wissen aber, dass das nicht ausreicht. Die Corona-Pandemie hat diese Entwicklung beschleunigt. Gleichzeitig haben wir während der Lockdowns deutlich gespürt, dass wir soziale Begegnungen und Erlebnisse brauchen.
In der Stadtmitte muss es Erlebnisse geben, die es anderswo nicht gibt. Wir wollen lebendige Städte, wir wollen Städte für Jung und Alt, für Familien, zum Leben und zum Wohnen. Wir wollen, dass der öffentliche Raum Platz bietet, auch für Erholung und Regeneration. Wir wollen Kultur, Bildung, Leben, Wohnen und Arbeiten miteinander verbinden. Bibliotheken, Kitas, Schulen und Universitätsstandorte beleben zentrale Lagen, weil sie Menschen in die Mitte holen. Co-Working-Spaces, Werkstätten von Handwerkern und Popup-Stores bringen mehr Vielfalt. Mehr Grünflächen, verbunden mit Sportmöglichkeiten und Plätzen für Entspannung, machen die Zentren nicht nur attraktiver, sondern auch widerstandsfähiger gegen den Klimawandel. Perspektivisch darf das Auto nicht mehr den Takt vorgeben. Wir wollen den Menschen den öffentlichen Raum zurückgeben. Die Städte machen sich auf den Weg, gemeinsam mit der Stadtgesellschaft, der Kunst- und Kulturszene, aber auch mit dem Einzelhandel, neue Konzepte auf den Weg zu bringen.
Darüber hinaus muss es möglich werden, dass wieder mehr Menschen im Zentrum wohnen können. Warum nicht Theaterbühne, Handwerk und Wohnungen unter ein Dach bringen? Das braucht gute Planung und mutige Investoren. Bei Bauprojekten in Stadtzentren werden wir verstärkt das Umwidmen und Sanieren bestehender Immobilien erleben. Das ist ein Beitrag für mehr Nachhaltigkeit, denn: Wo weniger neu gebaut und mehr bestehende Gebäude umgewidmet und saniert werden, sparen wir Rohstoffe und produzieren weniger schädliche Klimagase. Das ist wichtig, weil Bauund Materialpreise steigen.
Umso stärker sind Bund und Länder in der Pflicht, die Stadtentwicklung mit den etablierten Förderprogrammen zu unterstützen und weiter auszubauen. Klar ist: Für Städte muss es einfacher werden, die Förderprogramme zu nutzen. Die Umwidmung von Geschäftshäusern in Wohnraum oder gemischt genutzte Gebäude ist immer noch ein bürokratisch aufwändiger Akt. Also: Mehr Mittel, aktive Immobilienwirtschaft, kreative Konzepte und handlungsfähige Kommunen sind der Garant dafür, dass wir vor Ort Ressourcen bündeln und Prozesse beschleunigen können. Dann können aus guten Plänen auch schneller gute Projekte werden.
IMMOBILIEN AKTUELL 96 KOMMENTAR
Das finanzieren wir ...
Wohnimmobilien
Spezialimmobilien



„Wohnen am Bayerischen Bahnhof“ in Leipzig Zentrum-Süd. Ein Premium-Wohnprojekt der Stadtbau Wohnprojekte GmbH.
Baulandentwicklung
Kindertagesstätte mit gefördertem Wohnraum. Ein Projekt der Zwergenland Grundstück gGmbH & Co. KG.

Büroimmobilien
Löwitz Quartier - Quartiersentwicklung am Leipziger Hauptbahnhof. Joint Venture von OTTO WULFF, HAMBURG TEAM und HASPA PeB. Ein Konsortium von Hamburger Sparkasse und Sparkasse Leipzig.


Moderner Büroneubau in attraktiver Citylage in Leipzig als neuer Hauptsitz der Unite Group. Errichtet von der OFB Projektentwicklung GmbH. Eine DGNB Gold Zertifizierung wird angestrebt.




Mehr Informationen zu unserem Leistungsspektrum finden Sie unter: www.s-firmenkunden.de

Das sind wir – Team Gewerbliche Immobilien
IMMOBILIEN AKTUELL 97
Wenn's ums Geschäft geht: Wir sind Ihr starker Partner!
©bloomimages
Top-Deal Leasing
Klaus Busch von CoRE Solutions zeigt die Vorteile von Immobilienleasing auf und hält den Pflegemarkt für eine der Assetklassen, die massiv daran partizipieren können.

IMMOBILIEN AKTUELL (IA): Während der Pandemie gab es einen Einbruch, für 2022 registrierte der Bundesverband Deutscher Leasing-Unternehmen e.V. (BDL) wieder Immobilienleasing-Neuinvestitionen von über einer Milliarde Euro. Warum boomt das Leasing?
Klaus Busch (KB): Gegen Ende der Pandemie und mit Beginn des Ukraine-Krieges sind die Kosten gestiegen und damit auch bei vielen Unternehmen der Liquiditätsbedarf. Mit Immobilienleasing kann das Kapital,
das in eigenen Objekten steckt, für das eigentliche Geschäft nutzbar gemacht werden. Hinzu kommt: Trotz Konjunktureintrübung sind einige Unternehmen noch auf Wachstumskurs, etwa in der Logistik- oder der Pharmabranche. Sie können mit Immobilienleasing viel gebundenes Kapital freisetzen und für die Expansion verwenden.
IA: Welche Rolle spielen dabei Nachhaltigkeit und geänderte Arbeitsumgebungen?
KB: Das sind ebenfalls Faktoren, die die Nachfrage nach Immobilienleasing anheizen, weil sie enorme Investitionen in Unternehmensimmobilien erforderlich machen. Mit neuer Wärmedämmung, einer Photovoltaik-Anlage auf dem Dach, Elektrolademöglichkeiten in der Tiefgarage oder Sozialräumen machen Unternehmen sich und ihre Immobilien fit für die Zukunft. Die finanziellen Mittel für diese Investitionen können Unternehmen aus den eigenen Immobilien gewinnen, ohne sie aus der Hand geben zu müssen.
IMMOBILIEN AKTUELL 98 KAPITAL & INVEST
IA: Sind die Leasingraten im Officebereich günstiger als Mieten?
KB: Das lässt sich pauschal nicht sagen, denn die Höhe der Leasingraten legen wir für jeden Vertrag individuell mit dem Leasingnehmer und der refinanzierenden Bank fest. Zentrale Faktoren sind die Art des Objektes, die Laufzeit des Vertrages und die Konditionen des Bankkredites. Was immer wichtiger wird: Während Büromieten meist an die Inflation gekoppelt sind oder durch eine Staffelung steigen, bleiben die Leasingraten über die Dauer des Leasingvertrages gleich.
IA: Bekannt sind Neubau-Leasing (Build-and-lease), Buy-and-lease sowie Sale-and-lease-back – vor allem im Büro- und Logistikbereich. Bekommt Immobilienleasing aufgrund
KAPITAL & INVEST
der schwierigen Rahmenbedingungen auch für andere Assetklassen eine größere Bedeutung?
KB: Große Potenziale sehe ich vor allem im Pflegesegment, nicht zuletzt aufgrund der demografischen Entwicklung in Deutschland. Gerade in dieser Branche gibt es derzeit einen hohen Kapitalbedarf. Denn die Kostensteigerungen setzen den Pflegeheimbetreibern zu. Hinzu kommt ein massiver Modernisierungsstau. Viele Einrichtungen sind in die Jahre gekommen, müssen für neue gesetzliche Anforderungen und effizientere Arbeitsabläufe fitgemacht werden. Energetische Sanierungen sind entweder notwendig oder wegen eigener ESG-Unternehmensleitlinien erwünscht.
IA: Wie individuell kann Immobilien-
leasing an einzelne Projekte angepasst werden?
KB: Wir bieten keine Verträge von der Stange an. Jedes Unternehmen bringt seine Eigenheiten und Bedürfnisse mit, und kaum eine Immobilie gleicht der anderen. Kreativität ist zunehmend auch bei der Refinanzierung gefragt. Lange Zeit waren Banken zu 100-Prozent-Finanzierungen bereit. Doch mit höheren regulatorischen Anforderungen, schwächelnder Konjunktur und damit gestiegenen Risiken ist dies häufig nicht mehr möglich. Für die nachrangige Tranche holen wir externe Finanzierungspartner mit ins Boot, etwa institutionelle Investoren. Kurzum: Gutes Immobilienleasing lebt immer von individuell auf die Kunden und Objekte.
Interview: Ivette Wagner
Ohne Glasfaser geht es nicht mehr
FullServicePartner sichern die Versorgung der Liegenschaften der Wohnungswirtschaft
Ohne Glasfaser, ohne FTTH-Anschluss ist eine Immobilienentwicklung mittlerweile kaum noch denkbar. Der Ruf der Mieter und Eigentümer nach einer stabilen und hochbitratigen Internetversorgung wird immer stärker. Dabei ist der Blick auf Wertsteigerung, Bestandssicherung durch Sanierung, Modernisierung und Neuvermietung sowie Aufbau neuer Quartiere mit höchstem Anspruch bei der technischen Ausstattung gerichtet, aber auch auf die Energiepreisspirale und die fortschreitende Digitalisierung. Mehrfach zu planen, kann teuer werden oder zum Baustopp führen. Es muss also von Anfang an gesichert sein, dass die Glasfaseranbindung termingerecht und fachlich versiert umgesetzt werden kann. Die DNS:NET engagiert sich als einer der großen alternativen Telekommunikationsanbieter für eine zukunftsfähige Glasfaser-Infrastruktur in Deutschland. Dies geschieht im

überwiegenden Umfang über den eigenwirtschaftlichen Ausbau. Für die Immobilienbranche und die Wohnungswirtschaft ist dies eine gute Chance, mit verlässlichen Partnern vor Ort technologisch und kundenfreundlich die Bestände oder Neubauvorhaben multimediatauglich zu entwickeln.
Die DNS:NET analysiert mit den Projektteams die Ausgangssituation und setzt auf eine zügige Abwicklung. Der Ausbau der sogenannten Netzebene 4, also der Installation einer Glasfaserinfrastruktur bis in die Wohnungen (FTTH), ist hierbei die Norm.
FTTB- und FTTH-Ausbauprojekte finden sich in vielen Referenzen der DNS:NET, von der genossenschaftlich organisierten und kommunalen Wohnungswirtschaft über Bauträger und Verwaltungen bis hin zu den Top 5 der Infrastrukturentwickler Deutschlands.
Infos: dns-net.de/immobilienwirtschaft
IMMOBILIEN AKTUELL 99
ADVERTORIAL
uns unabhängiger vom Kapitalmarkt“
Franz-Bernd Große-Wilde, Vorstandsvorsitzender der Spar- und Bauverein eG Dortmund, spricht über die Spareinrichtung als Investvehikel und Zinsen über vier Prozent sowie über die Investitionsstrategie einer der größten Wohnungsgenossenschaften Deutschlands.
IMMOBILIEN AKTUELL (IA): Die Sparund Bauverein eG Dortmund gehört zu den größten Wohnungsgenossenschaften Deutschlands. Wie sieht Ihre Investitionsstrategie für 2024 aus?
Franz-Bernd Große-Wilde (GW): Die hohe Nachfrage nach bezahlbarem Wohnraum im Großraum Dortmund sowie die weitere Wertentwicklung und Stabilisierung des Wohnungsbestandes sind bedeutsame Gründe für unsere Investitionsstrategie. Die Megatrends Digitalisierung und Nachhaltigkeit sowie der demografische Wandel wirken sich dabei erheblich auf unsere strategische Ausrichtung aus. Insbesondere mit Blick auf die zukünftigen energetischen Anforderungen an Wohngebäude gilt es, das Portfoliomanagement weiterzuentwickeln. Im Zuge der Investitionstätigkeit in den Wohnungsbestand wird darauf abgezielt, den notwendigen Instandhaltungsbedarf weiterhin dienstleistungsorientiert und umfassend abzuarbeiten, das Modernisierungsprogramm zielgerichtet auf etwa gleichbleibendem Budgetniveau
fortzusetzen sowie weiteres Wachstum durch Nachverdichtung und Neubau (abhängig von der weiteren Marktsituation) zu generieren. Die moderate Expansionsstrategie ergänzt die Wohnwerterhaltung und -verbesserung im vorhandenen Wohnungsbestand.
IA: Wie stehen diese Zahlen in Beziehung zu den vergangenen beiden Jahren? Was hat sich verändert?
GW: Im Vergleich zu den vergangenen beiden Jahren sinkt die Investitionssumme um etwa 20 Prozent. Dabei bleiben Volumina in Großmodernisierung und Instandhaltung etwa konstant. Der Rückgang ist im Bereich der Neubautätigkeit zu verzeichnen. Dies folgt als Reaktion auf die Rahmenbedingungen, etwa als Folge des gestiegenen Zinsniveaus oder der negativen Veränderung in Kosten und Finanzierungsstrukturen.
Eine weitere Reaktion ist auch bei Fremdfinanzierung durch Banken zu spüren: eine beispielsweise schlechtere energetische Wohngebäudeeinstufung
kann schon jetzt zu einer Verschlechterung der Konditionen und zu höheren Sicherheitsanforderungen an die Finanzierung führen.
IA: Welche Rolle spielt der Neubau bei Ihnen und wie viel Kapital planen Sie explizit dafür ein?
GW: Unsere Genossenschaft versteht die Schaffung neuen Wohnraumes für ihre Mitglieder als wesentlichen Bestandteil der strategischen Portfolioerweiterung. Trotz erschwerter Rahmenbedingungen halten wir an dieser Strategie fest und setzen aktuell zwei Neubaumaßnahmen um. In Dortmund Renninghausen wird bis Frühjahr 2024 eine Klimaschutzsiedlung – bestehend aus fünf Gebäuden mit insgesamt 37 Wohneinheiten auf 3.000 Quadratmetern Wohnfläche – entstehen. Zudem startet aktuell der Umbau einer denkmalgeschützten Abendrealschule in Dortmunds innenstadtgelegenem Unionviertel. Bis Mitte 2025 werden wir aus den alten Klassenräumen 22 freifinanzierte Wohnungen auf einer
IMMOBILIEN AKTUELL 100 KAPITAL & INVEST
„Macht
Fläche von 1.500 Quadratmetern entstehen lassen. Für dieses Jahr planen wir 7,2 Millionen Euro für unsere Neubautätigkeit ein, für 2024 mit 8,1 Millionen Euro sogar noch mehr.
IA: Ihr Unternehmen ist zugleich eine Bank und hilft Menschen beim Sparen. Wie funktioniert das in der derzeit sehr schwierigen Situation?
GW: Die Spareinrichtung bedeutet bilanziell Fremdkapital. Nach dem Motto ‚Erst sparen, dann bauen‘ sind die Geldanlagen unserer Mitglieder wie ein Sparvertrag bei einer Bank. Wir müssen das Geld mit einer gewissen Mindestreserve liquide halten, den Rest können wir investieren. Das macht uns unabhängiger vom Kapitalmarkt.

IA: Welche Sparmöglichkeiten bieten Sie an?
GW: Die Spareinrichtung bietet unseren Mitgliedern eine breite Palette an sicheren Anlagemöglichkeiten. Diese reicht vom kurzlaufenden Sparbuch bis zum mehrjährigen Sparbrief. Eltern können für ihre Kinder so genannte Juniorsparverträge abschließen. Auch vermögenswirksame Leistungen können über unsere Spareinrichtung abgebildet werden. Der Zinssatz liegt je nach Laufzeit und Angebot zwischen 0,5 und 4,2 Prozent.
IA: „Die Einlagen bilden das finanzielle Rückgrat für den Bau neuen Wohnraumes und die Bewirtschaftung des Gebäudebestandes“, heißt es auf Ihrer Homepage. Wie stark muss denn das
Rückgrat sein hinsichtlich der Sanierungen?
GW: Gerade in der jetzigen Zeit, in der die Banken bei der Finanzierung spürbar zurückhaltender werden, ist unsere Spareinrichtung ein Vorteil. Dies gilt umso mehr für die Zukunft: Es ist nicht auszuschließen, dass die Banken Immobilien der Energieeffizienzklassen G und H nicht mehr finanzieren werden. Das macht die Einlagen unserer Mitglieder noch wichtiger. Hinzu kommt ein weiterer Vorteil: In Zeiten steigender Zinsen ist die Spareinrichtung ein günstiges Finanzierungsinstrument, da der Zinssatz über alle Sparformen zum Teil langfristig festgeschrieben ist und damit im Durchschnitt unter dem aktuellen Marktzins liegt.
Interview: Ivette Wagner
IMMOBILIEN AKTUELL 101 KAPITAL & INVEST
Wirklich Spitze?
Ferienimmobilien scheinen weiterhin eine prosperierende Nische im lahmen Immobilienmarkt zu sein. Im preiswerten Bereich herrscht viel Dynamik. Trotzdem gibt es Verschiebungen. Zwei Themen drängen sich dabei immer weiter in den Vordergrund: Denkmal und Energie.

KAPITAL & INVEST
Sie sind weiter wertstabil: Ferienimmobilien. Dazu eine präferierte Unterkunftsart. Laut Engel & Völkers gab es 51,8 Millionen registrierte Übernachtungen in gewerblich vermieteten Ferienimmobilien. Ein Rekordwert. Kauf-Spitzenpreise – wie üblich – verzeichneten die Analysten auf Sylt, Norderney, am Starnberger und am Tegernsee. Dort können in einzelnen Fällen Quadratmeterpreise von rund 30.000 Euro erreicht werden. Trotz den gewohnten Fakten gibt es aber auch auf diesem Markt Verschiebungen. Die Nachfrage auf Käuferseite war viel höher als das Angebot, diese Entwicklung hat sich etwas abgeschwächt.
„Die stetige Erhöhung der Bauzinsen führte dazu, dass in den mittleren und einfachen Lagen einiger Ferienorte eine gewisse Kaufzurückhaltung einsetzte“, sagt Till-Fabian Zalewski, CEO von Engel & Völkers für Deutschland, Österreich und die Schweiz. „Die Auswirkungen der Zinsentwicklung sind jedoch deutlich geringer als im Erstwohnsitzmarkt, da Ferienimmobilien in der Regel mit hohem Eigenkapitalanteil und von einer finanzstarken Kundschaft erworben werden.“ Trotzdem: Es wird länger gewartet und eine Kaufentscheidung mehr als vor Jahren verschoben.
Sotheby´s International konstatiert, dass bei Objekten bis 500.000 Euro ausreichend Bewegung im Markt sei, „teurere Objekte hingegen schwieriger ihre Abnehmer finden“. Julia Scharfe von Sotheby´s International Realty Sylt / Schleswig-Holstein stellt eine Besonderheit für den Sylter


IMMOBILIEN AKTUELL 103 KAPITAL & INVEST
Markt dar: „Die Nachfrage steigt bei sehr hochpreisigen Objekten, die für Investoren mit einer hohen Liquidität interessant sind. Wir sprechen sogar von der Schere in der Schere.“ Engel & Völkers weist auf die Rendite hin: Gerade durch „kurzfristige Vermietung lassen sich deutlich höhere Mieteinnahmen erzielen, woraus sich bei nur partieller Auslastung ein gutes Renditepotenzial ergibt“. Erst recht, wenn die hohe Nachfrage zu anziehenden Mieten führt. Deren Niveau steigt, laut dem Deutschen Tourismusverband. 2022 lag der Umsatz in der Ferienvermietung laut den Ergebnissen einer Umfrage knapp über fünf Prozent über dem Vor-Corona-Jahr 2019.
Wie auch in anderen Assetklassen bestimmt eine Neuerung den Markt: Preisfindung. Die richtige Bewertung und das Zusammenfinden von Käufer und Verkäufer stelle eine Herausforderung dar, so die Experten von Sotheby´s International. Insgesamt sei für Core-Produkte Kapital im Markt vorhanden. Was stetig bleibt: die Lage. Außergewöhnliche Objekte in Bestlagen finden weiterhin Käufer – auch, wenn sie (noch) nicht den modernsten Standards entsprechen. Ebenfalls im Trend: Denkmalschutzobjekte, vor allem wegen der steuerlichen Vergünstigungen.

„Bis vor kurzem haben selten Kunden nach beispielsweise den Energieverbräuchen gefragt. Hier sehen wir eine absolute Trendwende, sodass das Thema Teil des
Verkaufsprozesses geworden ist“, sagt Julia Scharfe. Bei gestiegenen Energiekosten haben damit moderne und sanierte Objekte klar die Nase vorn. Bei Engel & Völkers schlägt sich das in einem erhöhten Interesse an sanierten Objekten nieder. Was andererseits bedeutet: Die Eigentümer von Immobilien, die nicht den besten Standard haben, müssen sanieren und stehen damit wie alle anderen auch vor großen Herausforderungen. „Preisabschläge sehen wir bei Bestands-Ferienimmobilien in mittleren Lagen, wenn das Mikroumfeld nicht passt, ebenso wie bei Defiziten hinsichtlich der Energieeffizienz und Ausstattungsqualität“, sagt Andreas Gnielka, Geschäftsführer Wohnen von Grossmann & Berger, zwar konkret über die deutsche Ostseeküste zwischen Flensburg und Usedom, es passt wohl aber für alle Regionen. Preisnachlässe bei Neubauwohnungen gebe es dagegen kaum.
Laut dem Deutschen Ferienhausverband haben sich 75,5 Prozent der Eigentümer mit dem Thema Nachhaltigkeit beschäftigt. Fast jeder dritte Vermieter rüstete in den letzten zwei Jahren seine Ferienimmobilie energetisch auf (32,4 Prozent). Dazu gehören die Erneuerung der Heizungsanlage, der Austausch der Fenster oder der sanitären Anlagen. Weitere fünf Prozent planen eine energetische Sanierung. Interessant: 60,9 Prozent der Befragten setzten kleinere Energiesparmaßnahmen um, wie die Installation
IMMOBILIEN AKTUELL 104 KAPITAL & INVEST
wassersparender Duschköpfe oder die Installation moderner Heizungsregler. Nur 8,3 Prozent investierten dagegen in Smart Home.

Smart ist auf jeden Fall der Wunsch nach einer Ferienimmobilie. Das Zukunftsinstitut zählt Individualisierung zu den Megatrends. Der eigene Lebensstil manifestiert sich in individueller Einrichtung der Immobilie, An- und Abreise sind flexibel. Selbstverwirklichung heißt das Zauberwort. Setzt sich das im Bewusstsein der kapitalstarken Klientel noch stärker fest, scheint diese Assetklasse in eine gute Zukunft zu gehen. Oder mit den Worten von Engel & Völkers: „Vor allem langfristig eignet sich die Assetklasse für sicherheitsorientierte Investierende hervorragend und ist eine beliebte Altersvorsorge.“
Ivette Wagner
Übernachtungen in Ferienhäusern und -wohnungen
Anteil an Gesamtübernachtungen

IMMOBILIEN AKTUELL 105
0 20 40 60 80 100 2022 2021 2020 2019 2018 2017 0 3 6 9 12 15 42 ,7 48 ,1 41 ,5 42 ,6 51 ,8 36 ,7 11,5 13,7 13,7 9,7 8,9 8,0 in M io . in P rozent
Quellen: Statistisches Bundesamt (Destatis), Engel & Völkers Residential
Grün und mit Wirkung
Der Investitionsbedarf im Bereich der Pflege- und Gesundheitsimmobilien ist enorm. Um mehr Kapital zu mobilisieren, spielen Impact-Fonds eine wachsende Rolle.

Was bewirkt meine Geldanlage? Wer sich mit dieser Frage auseinandersetzt, stößt früher oder später auf das Konzept der Impact Investments. Dabei wird das Ziel Rendite mit einem positiven Beitrag zur Lösung drängender Umwelt- und Gesellschaftsprobleme verknüpft. Dieser strategische Ansatz steht bei Investoren hoch im Kurs. Die Bundesinitiative Impact Investing gibt das branchenübergreifende Volumen an selbst deklarierten Impact Assets inzwischen mit 38,9 Milliarden Euro an. Steigerungsfähig ist das Ganze allerdings im Hinblick auf die Immobilienbranche. Hier sind Fonds, die gemäß den strengen Nachhaltigkeitsanforderungen nach Artikel 9 der EU-Offenlegungsverordnung klassifiziert sind und somit eine ökologische und soziale Wirkung entfalten sollen, „immer noch nicht sehr zahlreich“, wie Hannah Dellemann weiß,
Teamleiterin ESG bei der Service-KVG INTREAL. Im Immobilien-Publikumsfonds-Segment liege die Zahl der Vehikel bei null, im Segment der offenen Immobilien-Spezialfonds gebe es immerhin circa zehn genehmigte Artikel 9-Fonds. In Zukunft werden es mehr sein, glaubt Hannah Dellemann. Aber vor allem die Krise mit Zinswende und steigenden Baukosten sorge für derzeit „eine gedämpfte Neuauflagetätigkeit“.
Erste Impact-Fonds für Pflegeimmobilien
Die Mehrzahl der Immobilien-Impact-Fonds setzt auf die Assetklasse Wohnen; Pflegeimmobilien sind hingegen die Ausnahme. Dabei besteht gerade auch in diesem Sektor ein erheblicher Investitionsbedarf. Laut der Carestone Group werden in den nächsten zwölf Jahren allein für den Neubau zwischen 80 und 125 Milliarden Euro benötigt. Nicht nur wegen dieser Zahlen sind Unternehmen wie die LHI Gruppe und die NIXDORF Kapital AG regelrechte Pioniere. Die beiden Partner haben Ende 2021 den ersten Artikel 9-Fonds mit einer Impact-Investmentstrategie und explizitem Fokus auf Pflegeimmobilien gestartet. Das Finanzprodukt ist auf zwölf Jahre ausgelegt und hat ein Zielvolumen von 200 Millionen Euro.
Ein weiterer Marktteilnehmer, der sich in diesem Segment positionieren will, ist die Real Blue KapitalverwaltungsGmbH. Für 2023 hat die in Stuttgart ansässige Gesellschaft die Auflage eines eigenen Impact-Fonds angekündigt. Der
IMMOBILIEN AKTUELL 106
Schwerpunkt soll auf Objekten der klassischen stationären Pflege liegen, ergänzt um Gesundheitsimmobilien wie Ärztehäuser und Medizinische Versorgungszentren, so Michael Eisenmann, Geschäftsführer Portfoliomanagement und Konzeption bei Real Blue. Neben Neubauprojekten seien ausdrücklich auch „Bestandsimmobilien mit Potenzial zur Optimierung der energetischen und ökologischen Gebäudequalität“ von Interesse.
Real Blue wurde 2021 als Tochter der Drees & SommerGruppe gegründet und sieht sich als Bindeglied zwischen dem professionellen Immobilienmarkt und dem institutionellen Kapitalmarkt. Den Investitions- und Modernisierungsbedarf bei Pflegeheimen schätzt das Unternehmen bis 2040 auf deutschlandweit rund 109 Milliarden Euro. Mit dem avisierten Impact-Fonds will Real Blue in Einzelobjekte mit einem Investitionsvolumen von 30 Millionen Euro sowie Portfolien mit bis zu 50 Millionen Euro investieren, so Michael Eisenmann. Die Strategie fokussiere auf die Erwirtschaftung stabiler, laufender Erträge über langfristige und wertgesicherte Miet- und Pachtverträge. Das geplante Eigenkapitalvolumen beträgt insgesamt rund

150 Millionen Euro.
Kommt das Finanzprodukt in diesem Jahr, wird es der zweite eigene Fonds von Real Blue sein. Im ersten Geschäftsjahr hat der Investmentmanager bereits unter dem
Namen Real Blue Senior Living einen offenen Artikel 8-Fonds aufgelegt, der sich auf Betreutes Wohnen konzentriert und zugleich ökologische und soziale Merkmale fördern soll. Fünf Transaktionen wurden bis Mitte 2023 getätigt, darunter zuletzt drei voll vermietete Immobilien in der Kleinstadt Selm bei Dortmund. „Obwohl es sich um Bestandsgebäude handelt, erfüllen die Ankaufobjekte die ambitionierten Vorgaben der ESG-Strategie des Fonds“, so Prof. Dr. Robert Göötz, Geschäftsführer Risikomanagement bei Real Blue.
Verifort bringt neuen Publikumsfonds
Dass im Bereich der Pflegeimmobilien auch geschlossene Publikumsfonds eine Chance haben, belegt Verifort Capital. Die Unternehmensgruppe mit Hauptsitz in Tübingen hat im Mai 2023 den Start seines zweiten AIF bekanntgegeben, des Verifort Capital HC 2. Sein Portfolio soll neben Immobilien aus den Bereichen stationäre Pflegeheime, Betreutes Wohnen sowie Tages- und ambulante Pflege auch medizinische Einrichtungen enthalten. Der Artikel 8-Fonds richtet sich mit einer Mindestbeteiligung von 5.000 Euro gezielt an Privatanleger – und soll auch zur Verwirklichung sozialer Ziele beitragen.
Für Projekte, die Wohnraum schaffen
Sie suchen die passende Finanzierung für Bau, Sanierung oder Modernisierung Ihrer Immobilie? Wir haben sie. Kompetent, zuverlässig und mit dem Ziel, Ihr Bauvorhaben erfolgreich zu gestalten. Sprechen Sie mit uns!
Hotline Immobilienförderung: 030 / 2125-2662
ibb.de/vermieter_investoren
Besuchen Sie uns vom 4.– 6.10.2023 auf der EXPO REAL in München
IMMOBILIEN AKTUELL 107 KAPITAL & INVEST
DU230731_IBB_AZ_210x145_Immobilien-Aktuell-Expo_ET231101_wohnen_3_2_RZ.indd 1 31.07.23 09:22
Matthias Klöppel
Auf dem Holzweg
Investments in das nachhaltige Material sind derzeit schwer angesagt. Der eher als konservativ eingeschätzte Bereich ist trotz vieler Bemühungen immer noch schwierig hinsichtlich der Transparenz.
Grünes Gold wird es von vielen genannt. Clark S. Binkley, Geschäftsführer von International Forestry Investment Advisors im amerikanischen Portland, ist überzeugt: „Bei der Umstellung auf Holz steht Europa an der Spitze, aber auch in den USA, einem der größten Immobilienmärkte der Welt, vollzieht sich eine Wende.“ Der Markt für Kreuzlagenholz dürfte bis 2027 weltweit von 1,1 Milliarden US-Dollar im Jahr 2021 auf rund 2,5 Milliarden US-Dollar anwachsen; das entspricht einem jährlichen Anstieg von rund 15 Prozent. Clark S. Binkley glaubt sogar an eine noch höhere Zahl. Auf finanzen.net wird folgende Rechnung erstellt: Die globale Nachfrage nach nicht verarbeiteten Holzstämmen soll bis zum Jahr 2030 auf rund 800 Millionen Kubikmeter ansteigen, was einer Verdopplung des aktuellen Bedarfes entsprechen würde. Kein Wunder,
dass „neben Adelsfamilien und Großgrundbesitzern auch die Stiftungsfonds der Havard und Yale Universität seit mehr als 20 Jahren großzügig investieren“, heißt es dort. Nur: In was investiert man eigentlich? Beim Bundesamt für Naturschutz steht folgender Satz: „Teil des grünen Wertpapiermarktes sind Waldfonds und andere Finanzanlageprodukte mit Waldfokus, welche ebenfalls wachsen. Jedoch tragen diese Anlageprodukte oft kaum zum Waldund Biodiversitätsschutz bei oder schaden diesen Zielen sogar. Neue umweltregulatorische Rahmenbedingungen wie die EU-Taxonomie können für Transparenz sorgen, allerdings benötigen viele Finanzmarktakteure Unterstützung im Umgang mit dem Regelwerk.“ Welche Transportwege nimmt das Holz – quer durch Deutschland, Europa und die Welt? Unter welchen Bedingungen werden Wälder

IMMOBILIEN AKTUELL 108 KAPITAL & INVEST
wieder angelegt? Dazu kommt eine sehr kleinteilige Eigentümerstruktur hier in Deutschland, die Investments eher schwer macht. Faktoren wie Wetter und Schädlinge sind schwierig vorherzusagen. Die langen Laufzeiten – Bäume müssen ja wachsen – haben eine geringe Liquidität zur Folge, was in ein paar Jahren der Rohstoff wert ist, weiß auch niemand so genau.
Die Vorteile liegen aber auf der Hand: eine nachhaltige Kapitalanlage, unabhängig von der Börse. Auch wenn im Forst-Marktbericht von Colliers nachzulesen ist, dass immer weniger Beschäftigte immer weniger in diesem Segment unterwegs sind und die Importe von Holz die Exporte überschreiten. Das Analysehaus zeigt die Kleinteiligkeit des Marktes auf, der auch dadurch nicht gerade mit aktuellen Zahlen gesegnet ist. „Der Umsatz im gesamten Cluster Forst und Holz einschließlich Waren und Dienstleistungen ist seit 2018 gesunken und lag 2020 bei 180,6 Milliarden Euro“, so die Colliers-Experten. 2018 waren es noch knapp 188 Milliarden. Die Umsatzverluste gehen auf – wie fast in allen Bereichen der Immobilienwirtschaft – den Krieg in der Ukraine zurück, auf die Störung von Lieferketten, das Zinsniveau, Inflation und Energiekosten zurück.
Die Preise bleiben davon nicht unbeeinträchtigt und fielen 2020: auf durchschnittlich etwa 12.800 Euro pro Hektar. „Damit liegt das aktuelle Preisniveau jedoch noch über dem zehnjährigen Mittel von etwa 11.000 Euro pro Hektar“, so die Spezialisten des Analysehauses. „Aufgrund einer höheren Nachfrage sowie einer Verknappung der Flächen und somit des Angebotes werden die Preise für Forstflächen in Deutschland vermutlich auch weiter moderat steigen“, sagen sie voraus.
Das hängt natürlich mit der Nachhaltigkeit der Investments zusammen. Denn diese ist in dem Bereich besser abbildbar als in anderen. Es gibt den Forest Stewardship Council und das Programme for the Endorsement of Forest Certification. Diese Zertifizierungen sind international, es bestehen Überschneidungen und Gemeinsamkeiten in den Anforderungen. Und natürlich arbeitet man an der Zertifizierung der Klimaschutzleistung von Wäldern. Ein derartiger Standard sei dann geeignet, die Kohlenstoffspeicherleistung in Form von CO2-Zertifikaten nachzuweisen, so Colliers. In Deutschland ist PEFC am weitesten verbreitet, 2021 waren laut Colliers in Deutschland insgesamt 10,8 Millionen Hektar Wald nach FSC- oder PEFC-Standard zertifiziert, davon 6,8 Millionen nach PEFC und vier Millionen FSC.
Ein White Paper der beiden Schweizer Organisationen
ZHAW School of Management and Law und Timber Finance zeigt Grundlagen und Vorteile der Investments auf. Dort heißt es: „Der aktuelle Markt scheint auf Investoren ausgerichtet zu sein, die mit einer Timber-Anlage vor allem ihr Portfolio diversifizieren oder etwas nachhaltiger gestalten möchten.“ Bedeutet: Die meisten Timber-Fonds enthalten Unternehmen, die holzverarbeitend tätig sind und auch kurzlebige Produkte herstellen. Oft werde dabei die CO2-Speicherfunktion von Holz vielerorts vernachlässigt. „Möchte man als Investor aber genau diese langfristige
Speicherfunktion oder die Substitutionseffekte berücksichtigen und (ausschließlich) in langlebige Holzprodukte, wie beispielsweise Holzhäuser, investieren, wird man mit äußerst begrenzten Anlagemöglichkeiten konfrontiert. Denn solche spezifischen Produkte existieren derzeit kaum“, heißt es dort.
Und weiter: „Durch das Renditepotential von TimberInvestments und die natürliche Klimaleistung von Holz können Investitionen in die Holzwertschöpfungskette eine vielversprechende Option für nachhaltigkeitsfokussierte Anleger sein.“ Klar wird nach der Lektüre auch: Noch ist das Angebot begrenzt, noch bedarf es grundlegender Expertisen, um in diesen doch sehr speziellen Markt sinnvoll zu investieren. Momentan bieten da amerikanische Anbieter
Ivette Wagner
Quelle: Arbeitskreis der Oberen Gutachterausschüsse, Zentralen Geschäftsstellen und Gutachterausschüsse in der Bundesrepublik Deutschland (AK OGA) / Forst-Marktbericht 2023

IMMOBILIEN AKTUELL 109 KAPITAL & INVEST
Hamburg Kiel Schwerin Bremen Hannover Erfurt Dresden Düsseldorf Mainz Saarbrücken Stuttgart München Magdeburg Potsdam Berlin Wiesbaden Preise forstwirtschaftlicher Flächen 2020 (in €/ha) 4.50 0– 6. 00 0 €/ ha 6. 00 0– 7.20 0 €/ ha 7.20 0– 8.80 0 €/ ha 8.80 0– 12.300 € /h a über 12. 30 0 €/ ha ke in e Date n 3. 40 0– 4.50 0 €/ ha unte r 3. 40 0 €/ ha
Augenschmeichler
Die Immobilienbranche ist innovativer als viele denken. Das zeigt sich besonders auf dem weiten Feld der Projektentwicklungen. In unserer Rubrik GALERIE präsentieren wir Ihnen in vier ausgewählten Themenbereichen spannende Bauvorhaben aus dem gesamten Bundesgebiet, die nicht nur mit ihrem Äußeren zu überzeugen wissen.
Texte: Frank Baecke
Future Real Estate – Neubauten für digitale Lösungen
Innovations Park AI – Heilbronn

Mit dem Innovations Park AI (Ipai) wird ab 2024 in Heilbronn das größte Ökosystem für Künstliche Intelligenz (KI) in Europa errichtet. Auf 23 Hektar Fläche entstehen bis 2027 moderne KI-Infrastrukturen und Testfelder für KI-basierte Produkte und Dienstleistungen. Das Rotterdamer Architekturbüro MVRDV hat den Campus als ein Quartier entworfen, in dem Menschen, Technologie und Landschaft zusammenkommen. Der Entwurf wurde unter acht Teilnehmern aus vier Ländern zum Sieger gekürt. www.ip.ai

IMMOBILIEN AKTUELL 110
DIE GALERIE
Siemensstadt Square – Berlin
Innovativ, nachhaltig und inklusiv – so möchte Siemens gemeinsam mit der Stadt Berlin und dem Bezirk Spandau den Zukunftsstandort Siemensstadt Square gestalten. Aus dem geschlossenen 76 Hektar großen Industrieareal soll ein offenes und lebendiges Stadtquartier werden, in dem Menschen aus aller Welt wohnen, arbeiten, forschen und produzieren. Das Projekt soll zum Vorbild für einen zukunftsgewandten Umgang mit bestehenden Gebäuden und Stadtstrukturen werden. www.siemensstadt.siemens.com/de

Wöhr + Bauer Wissenscampus – Stuttgart
Mit einem Neubau in HolzhybridBauweise komplettiert Wöhr + Bauer den Wissenscampus in Stuttgart-Weilimdorf. Das viergeschossige KfW 40 EE-Haus mit Dachbegrünung benötigt dank des Baustoffes Holz rund 50 Prozent weniger Beton. Zugleich erhöht sich durch viele Fertigbauteile das Bautempo. Der Holzhybride namens W15 ist nach dem Neubau des W9 und der Sanierung des W11 das dritte und letzte Gebäude des neuen Business-Distrikts an der Weissacher Straße. Es soll 2024 fertiggestellt werden.

Infineon Chipfabrik – Dresden
Im Herbst 2023 startet Infineon in Dresden den Bau eines neuen Werkes mit 1.000 Arbeitsplätzen. Bis zur Fertigstellung im Herbst 2026 will der Halbleiterhersteller fünf Milliarden Euro in die Smart Power Fab für 300-Millimeter-Wafer fließen lassen – die größte Einzelinvestition in der Geschichte des Unternehmens. Das künftige Werk soll eine der umweltfreundlichsten Fertigungsstätten seiner Art werden und mittels fortgeschrittener Digitalisierung und Automatisierung neue Maßstäbe für Fertigungsexzellenz setzen.


IMMOBILIEN AKTUELL 111
DIE GALERIE
Neue Lebensqualität – Wohnquartiere mit hohem Qualitätsanspruch
Neckarspinnerei – Wendlingen
Die denkmalgeschützte Neckarspinnerei der Textilfabrik Otto in Wendlingen wird zu einem gemischt genutzten, nachhaltigen Stadtquartier weiterentwickelt. Das Areal zählt zu den wichtigsten Industriedenkmälern im deutschen Südwesten und soll künftig als NQ Neckarspinnerei Quartier erneut Wohnen und Arbeiten verbinden. Hierfür wird der historische Gebäudebestand um ein zweites Quartier mit Neubauten für Wohnen und Gewerbe erweitert. Der Entwurf stammt vom Berliner Büro Rustler Schriever. www.neckarspinnerei-quartier.de/

Seepark Pätz – Bestensee Der Alltag soll sich wie Urlaub anfühlen. Diesen Gedanken setzt Bonava im Seepark Pätz um, einem grünen Wohnquartier mit 63 Häusern im brandenburgischen Bestensee südlich von Königs Wusterhausen. Die Einfamilien- und Doppelhäuser sind bereits verkauft. Zwei Mehrfamilienhäuser mit 51 Wohnungen – ein repräsentatives Landhaus und ein kleineres Kavalierhaus – werden gerade bezugsfertig. Mit ihrer Fertigstellung erreicht das Gesamtprojekt vier Jahre nach dem ersten Spatenstich die Zielgerade.


IMMOBILIEN AKTUELL 112 DIE GALERIE
Bredeney Park – Essen Angelehnt an beste BauhausTraditionen entstehen im Essener Stadtteil Bredeney sieben Stadtvillen an den Ruhrhöhen. Die 47 Eigentumswohnungen erhalten hochwertige Ausstattungen und bieten weite Ausblicke auf den Baldeneysee und die bewaldeten Hänge. Das naturnahe Areal war einst der Wohnsitz des KruppGeneralbevollmächtigten Bertold Beitz. Seine Villa wurde 2021 zurückgebaut, um Platz für den Bredeney Park zu schaffen. Das von PROPOS entwickelte Projekt hat im Januar 2023 die Baugenehmigung erhalten. www.bredeney-park.de





KaepseLE Goldäcker – LeinfeldenEchterdingen
Auf dem Goldäcker-Areal am westlichen Rand von Echterdingen entstehen 180 Wohnungen nach höchsten ökologischen Standards. Das Projekt heißt KaepseLE und versteht sich als Experimentierfeld. Die Bauträger sollen Methoden entwickeln und erproben, die auf andere Quartiere übertragbar sind, etwa verdichtete Bauweisen, optimierte Freiflächengestaltung und recyclinggerechtes Bauen. Ziel des technologieoffenen Projektes ist das Finden optimaler Lösungen. www.leinfelden-echterdingen. de/Startseite/Stadtentwicklung/ kaepsele+goldaecker+_echterdingen_.html
IMMOBILIEN AKTUELL 113 DIE GALERIE
Häuser des Geistes – Bauten für Kultur, Bildung und Religion
House of One – Berlin

Ein Gotteshaus für drei Religionen, das ist die Idee des House of One. Es sieht für Christen, Juden und Muslime unter einem Dach eine Kirche, eine Synagoge und eine Moschee vor. Verbunden werden die drei separaten Gebetsräume durch einen zentralen Kuppelsaal als Raum der Begegnung. Der Sakralbau entsteht bis 2028 am Petriplatz in Berlin-Mitte. Die Ausführung erfolgt in traditioneller Ziegelbauweise. Mit Spenden von zehn Euro pro Stein können Interessierte das Projekt unterstützen. www.house-of-one.org/de
Volkstheater – Rostock
Im Herbst 2028 soll sich der Vorhang des neuen Volkstheaters in Rostock zum ersten Mal heben. Gebaut wird es ab 2024 am Eingang der Langen Straße nahe dem Stadthafen an der Unterwarnow. Der Solitär mit Rundblick wird das neue Wohnzimmer der Stadt. Neben zwei Theatersälen ist eine Gastronomie im Turm vorgesehen, die auch Nicht-Theaterbesuchern zugänglich ist. Der Entwurf stammt vom Berliner Architekturbüro Hascher Jehle, das sich in einem internationalen Wettbewerb durchsetzte.


www.volkstheater-rostock.de/theaterneubau

IMMOBILIEN AKTUELL 114
DIE GALERIE
Schulcampus Dietenbach – Freiburg
Der unter 17 Einreichungen als Sieger gekürte Entwurf für eine Gemeinschaftsschule im neuen Freiburger Stadtteil Dietenbach sieht fünf Holzhybrid-Gebäude vor, die an einer verbindenden Magistrale versetzt angeordnet sind und so Vorplätze und Freiräume schaffen. Ergänzt wird das Ensemble, zu dem auch eine Mensa, eine Bühne, zwei Sporthallen und Kinderund Jugendtreff gehören, durch einen Sport- und Bewegungspark, der allen Bürgern offensteht. Der Entwurf stammt von mbpk Architekten und RMP Stefan Lenzen Landschaftsarchitekten. Der Bau soll 2026 beginnen.
Schulcampus Lohsepark – Hamburg
Am Lohsepark in der Hamburger Hafencity soll eine neue Campus-Stadtteilschule für 1.600 Kinder die dortige Containerschule ablösen. Das neue, architektonisch auffällige Schulgebäude wurde vom Stuttgarter Büro Haascookzemmrich Studio 2050 entworfen.


Es verfügt über eine umlaufende Terrasse in der ersten Etage und ein Sportfeld auf dem Dach. Außerdem umfasst der Komplex drei Sporthallen, eine Kita und eine Mensa. Die Bauarbeiten sollen Ende 2024 starten und im Herbst 2026 enden. www.schulcampus-lohsepark.de

IMMOBILIEN AKTUELL 115 DIE GALERIE
Neuer Anstrich – Revitalisierte und umgewidmete Projekte
Klinkerhöfe – Potsdam
In Krampnitz entsteht Potsdams neuer Norden. Der ehemalige Militärstandort am Krampnitzsee umfasst 82 denkmalgeschützte Gebäude, darunter die Klinkerhöfe mit einstigen Mannschaftsunterkünften. In vier dieser Gebäude errichtet die BUWOG zurzeit 185 Wohnungen, die Ende 2024 bezugsfertig werden. Direkt gegenüber entsteht ein Grundschulcampus mit Kita, Hort und Sporthalle. Insgesamt soll in den kommenden Jahren auf dem 150 Hektar großen Areal neuer Wohnraum für 10.000 Menschen entstehen. www.krampnitz.de
Braugold Areal – Erfurt
Die ehemalige Braugold-Brauerei in der Erfurter Löbervorstadt wird in ein modernes Quartier mit 254 Wohnungen umgebaut. Hierfür will CG Elementum die denkmalgeschützten Gebäude sanieren und durch Neubauten ergänzen. Zudem soll das Quartier entsiegelt und begrünt sowie mit PhotovoltaikAnlage, Wärmepumpen, Blockheizkraftwerk, Eisspeicher und E-Lademöglichkeiten ausgestattet werden. In den Gewölbekellern entstehen 260 Pkw-Stellplätze. Teile der Gärkeller bleiben der dort lebenden Fledermauskolonie vorbehalten. www.braugoldareal.de




IMMOBILIEN AKTUELL 116
DIE GALERIE
Garbe Immobilien will den gut 30 Jahren alten Verwaltungsbau der ehemaligen Oberpostdirektion im Frankfurter Westend bis 2025 ESG-konform revitalisieren und als grünes Büroobjekt unter dem Namen Westend Gardens neu positionieren. Hierzu werden unter anderem die Dachterrassen und der Innenhof begrünt, Urban-GardeningAngebote für Mitarbeiter geschaffen und recycelte Materialien verwendet. Das Nachhaltigkeitskonzept mit PhotovoltaikAnlage und Wärmepumpe soll einen klimaneutralen Betrieb der Immobilie bis 2035 ermöglichen.



Aer – München
Im Münchner Stadtteil Neuperlach verwandelt Hines einen ehemaligen Allianz-Standort in das nachhaltige Büro- und Wohnquartier Aer. Nach den Plänen niederländischer Architekten werden 30 Prozent der monolithischen Gebäudestruktur entfernt, um acht einzelne Gebäude sowie Wege durch den Komplex zu schaffen. Ein Neubau ergänzt das Ensemble als neuntes Gebäude. Im künftigen Aer sind neben Flächen für gewerbliche Nutzungen auch 200 Wohnungen geplant. www.aer-muenchen.de
IMMOBILIEN AKTUELL 117
Westend Gardens – Frankfurt
Impressum
IMMOBILIEN AKTUELL
Herausgeber
Michael Rücker
IMMOCOM GmbH
Richterstraße 7 04105 Leipzig ruecker@immocom.com
Redaktionsleitung
Ivette Wagner wagner@immocom.com
Layout Andreas Späthe
Fabian Tholen druckdaten@immocom.com
Autoren
Frank Baecke
Joline Becker
Prof. Dr. Thomas Beyerle
Laura Dommel
Robert Hoffmann
Christian Hunziker
Viviane Karel
Mara Kaemmel
Constanze Kehler
Matthias Klöppel
Markus Lewe
Dr. Ulrich Nagel
Pierre Pawlik
Jörn Glasner
Ivette Wagner
Anzeigenverkauf
Marcus Grundmann grundmann@immocom.com
Bildnachweise
S. 10: Pixabay; SSV Architekten
S. 11: BVIV; Hadi Teherani Architects/Panoptikon
S. 12: Frankfurt School of Finance & Management; IVD
S. 14: Deutsche Wohnen & Co Enteignen
S. 15: Catella
S. 16: Becken Holding GmbH
S. 17: Panattoni; Heribert Schindler
S. 18: Instone Real Estate; Ten Brinke
S. 19: PANDION AG; Gröner Group
S. 20: Stefan Döbler/Nordkirche
S. 25: Arte Charpentier; Petitdidier Prioux
S. 28: Wick + Partner / Stadt Jena
S. 29: MuellerReimann; GW Projects GmbH
S. 30: FinList; N Robotics
S. 31: Voltaro; einwert
S. 32: DIEfabrik GmbH & Peter Rüssmann für DIEAG
S. 35: S&G
S. 36: Renderfriends
S. 37: WABE PLAN
S. 38: bloomimages
S. 39: DIE WOHNKOMPANIE Nord
S. 40 Henn, EuroAltantic
S. 42: Lengfeld & Wilisch
S. 44: Stadt Köln / Aerophoto
S. 45: PASCH Interior Design
S. 46: OFB/Swissinteractive
S. 47: Vattenfall
S. 48: blocher partners
S. 50: Rendertaxi
S. 52: Tobias Kern
S. 54: Bricks&Beyond GmbH
S. 56/57: TU Berlin
S. 58/59: SEMUDO AG
S. 60/61: Mara Kaemmel
S. 66: PREA Group
S. 69: Alexander von Erdély
S. 70/71: Premier Inn Deutschland
S. 72: Prof. Günter Vornholz
S. 73: Render Vision
S. 76/77: IMMOCOM
S. 79: IMMOTISS
S. 80/81: DLE Land Development GmbH
S. 84: pexels marc mueller
S. 85: HIH
S. 87: thirteen seven, P3 Logistic Parks
S. 88: GARBE
S. 89: Panattoni; Deutsche Logistik Holding GmbH & Co. KG
S. 95: design for human nature / tegut
S. 96: Stadt Münster
S. 98: CoRE Solutions GmbH
S. 100: SPARBAU Dortmund
S. 102-105: Engel&Völkers
S. 110: Ipai/MVRDV
S. 111: Greenbox Landschaftsarchitekten / Siemens; WÖHR + BAUER
S. 112: Rustler Schriever Architekten und GDLA Landschaftsarchitektur; Bonava
S. 113: Duplex Architekten; beyond visual arts GmbH
S. 114: Kuehn Malvezzi / Davide Abbonacci; Hascher Jehle Design GmbH
S. 115: mbpk-architekten; haascookzemmrich STUDIO 2020
S. 116: BUWOG; CG Elementum AG / CZ Visual;
S. 117: GARBE Immobilien-Projekte, schneider+schumacher, moka-studio; FransParthesius
Shutterstock:
Titelseite: Pemel
S. 13: Steve Photography; Lisa-S
S. 21: picture.factory
S. 26: lefthanderman
S. 43: Anusorn Nakdee
S. 62: Ground Picture
S. 63: Robert Kneschke
S. 64: zffoto
S. 68: Gorodenkoff
S. 74: hydebrink
S. 78: Africa Studio
S. 83: Monkey Business Images
S. 86: Danila_M
S. 88: Lightspring
S. 90: hanohiki
S. 93: Radu Bercan
S. 94: FamVeld
S. 106: PhotographyByMK
S. 108 Jens Ottoson
Das Copyright 2023 für alle Beiträge liegt bei der IMMOCOM GmbH. Nachdruck, Übernahme in digitale Medien sowie Vervielfältigungen auf Datenträger bedürfen der ausdrücklichen Zustimmung durch den Herausgeber.
IMMOBILIEN AKTUELL 118

Events Unser Netzwerk für Ihren Erfolg Media Branchennews kompakt für Sie aufbereitet Agency Kommunikation für die Immobilienbranche www.immocom.com
Vier Standorte – ein Ziel.





















































































































































































Ob München, Dresden, Leipzig oder Berlin – hochwertige Lebens- und Arbeitsräume sowie nachhaltige Zukunftswerte für Eigennutzer und Kapitalanleger zu schaffen, ist unser Anspruch. Und das natürlich stets in ausgewählten Lagen.
Eilenburger Straße 21a im Lene-Voigt-Park
Am östlichen Ende des Lene-Voigt-Parks entsteht ein karreeförmiger Baukörper mit 120 altersgerechten Wohnungen, zwei Gewerbeflächen und Tiefgarage. Das Vorhaben „Park End“ verbindet ökologische Bauweise mit hoher Energieeffizienz und liegt zentrumsnah und trotzdem im Grünen.

Hardenbergstraße 30 in der Südvorstadt
Direkt am Heinrich-Schütz-Platz entsteht ein eleganter Neubau „Vis-a-Vis“ mit modernen 28 2- bis 4,5-Zimmer-Wohnungen und Tiefgarage. Die Kiezlage zwischen Karl-Liebknecht-Straße und Fockeberg sowie das naturnahe Umfeld bietet für jede Lebensphase die passende Wohnung.



Da, wo das Hafenbecken beginnt, setzt der Lindenauer Hafen seine erfolgreiche Entwicklung fort. Auf dem ersten von vier Baufeldern entsteht ein zum Hafenbecken orientierter Baukörper, mit 36 Servicewohnungen, Tagespflege und Tiefgarage. Die großen Balkone ermöglichen jeder Wohnung den Blick zum Lindenauer Hafen.
An der Dresdner Straße entsteht eine siebengeschossige Eckbebauung mit 55 altersgerechten Wohnungen, zwei Gewerbeflächen und Tiefgarage. Die „Residenz Drei Linden“ verfügt über ein großes, parkähnliches Grundstück sowie kurze Wege in die Innenstadt – perfekt für einen abwechslungsreichen Tagesablauf.
Seit 1966 wurden über 20.000 Wohnungen in über 350 Vorhaben realisiert.

Dabei ist unsere Arbeitsweise schon immer untrennbar damit verbunden, dass wir die Bedürfnisse und Wünsche unserer Kunden erkennen und in unseren Vorhaben zuverlässig umsetzen.





































Hafenstraße 21 am Lindenauer Hafen leipzig@baywobau.de

GRUN Arch t Shake Te Fax nfo@ P anun Datum Le pz g P an nh Pro ek Bayw Ka l-L 04107 Te Fax B h Konzeptans cht M 1 200 Konzeptans cht M 1 200 Linea NS and Rotsporn Kreativbüro
0341/96384-0 LEIPZIG
Visu: GRUNWALD & GRUNWALD
Visu: DNR Daab Nordheim Reutler
Visu: Baywobau
Dresdner Straße 27 im Gra schen Viertel
Visu: KLM Architekten














































































































































 Ivette Wagner
Ivette Wagner







 Laura Dommel
Laura Dommel





 Mara Kaemmel
Mara Kaemmel


















 Frank Baecke
Frank Baecke

Ivette Wagner
Ivette Wagner






















 Matthias Klöppel
Matthias Klöppel


 Jörn Glasner
Jörn Glasner







 Ivette Wagner
Ivette Wagner








































































